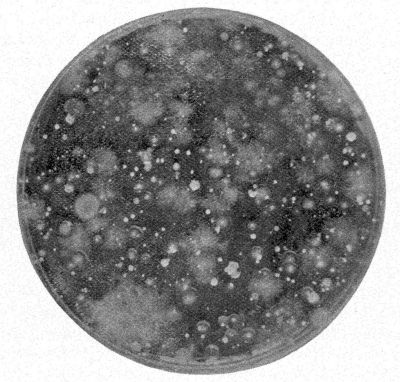

Fig. 1.—Forms of Bacteria.
Fig. 1.—Forms of Bacteria.A, coccus; B, bacillus; C, spirillum.
The Project Gutenberg EBook of Outlines of dairy bacteriology, by
H. L. Russell and E. G. Hastings
This eBook is for the use of anyone anywhere at no cost and with
almost no restrictions whatsoever. You may copy it, give it away or
re-use it under the terms of the Project Gutenberg License included
with this eBook or online at www.gutenberg.org
Title: Outlines of dairy bacteriology
A concise manual for the use of students in dairying
Author: H. L. Russell
E. G. Hastings
Release Date: May 14, 2010 [EBook #32367]
Language: English
Character set encoding: ISO-8859-1
*** START OF THIS PROJECT GUTENBERG EBOOK OUTLINES OF DAIRY BACTERIOLOGY ***
Produced by Stacy Brown, Peter Vachuska, Julia Miller and
the Online Distributed Proofreading Team at
https://www.pgdp.net
BY
Dean of the College of Agriculture
University of Wisconsin
AND
Professor of Agricultural Bacteriology
University of Wisconsin
TENTH EDITION
MADISON, WISCONSIN
H. L. RUSSELL
1914
Copyright 1914
BY
H. L. RUSSELL and E. G. HASTINGS
This text was originally the outgrowth of a series of lectures on the subject of dairy bacteriology to practical students in the winter Dairy Course in the University of Wisconsin. The importance of bacteriology in dairy processes has now come to be so widely recognized that no student of dairying regards his training as complete until he has had the fundamental principles of this subject.
The aim of this volume is not to furnish an exhaustive treatise of the subject, but an outline and sufficient detail to enable the general student of dairying to obtain as comprehensive an idea of the bacteria and their effects on milk and other dairy products as may be possible without the aid of laboratory practice. When possible the dairy student is urged to secure a laboratory knowledge of these organisms, but lacking this, the student and general reader should secure a general survey of the field of bacteriology in relation to dairying.
In this, the tenth edition, the effort has been made to include all of the recent developments of the subject. Especially is this true in regard to the subject of market milk, a phase of dairying that has gained greatly in importance in the last few years. The changes in the methods of handling market milk have been marked. The results of these changes in influencing the quality of milk offered to the consumer are fully discussed.
H. L. R.
E. G. H.
| Structure, Growth and Distribution of Bacteria | 7 |
| Methods of Studying Bacteria | 20 |
| Contamination of Milk | 28 |
| Infection of Milk with Pathogenic Bacteria | 62 |
| Fermentations of Milk | 82 |
| Preservation of Milk | 113 |
| Bacteria and Butter Making | 136 |
| Bacteria and Cheese Making | 161 |
| Bacteria in Market Milk | 189 |
STRUCTURE, GROWTH AND DISTRIBUTION.
Relation of bacteriology to dairying. The arts which have been developed by mankind have been the outgrowth of experience. Man first learned by doing, how to perform these various activities, and a scientific knowledge of the underlying principles which govern these processes was later developed.
The art of dairying has been practiced from time immemorial, but a correct understanding of the fundamental principles on which the practice of dairying rests is of recent origin. In working out these principles, chemistry has been of great service, but in later years, bacteriology has also been most successfully applied to the problems of modern dairying. Indeed, it may be said that the science of dairying, as related to the problems of dairy manufacture is, in large degree, dependent upon an understanding of bacteriological principles. It is therefore essential that the student of dairying, even though he is concerned in large measure with the practical aspects of the subject, should acquire as complete an understanding of these principles as possible.
While bacteriology is concerned primarily with the activities of those microscopic forms of plant life known as the bacteria, yet the general principles governing the life of this particular class of organisms are sufficiently similar to those governing the molds and other types of microscopic life that affect milk and its products to make[Pg 8] it possible to include all of these types in a general consideration of the subject.
Nature of bacteria. The vegetable kingdom to which the bacteria belong consists of plants of the most varying size and nature. Those of most common acquaintance are the green plants varying in size from those not visible to the naked eye to the largest trees. Another class of plants known as fungi or fungous plants do not contain chlorophyll, the green coloring matter, but are usually colorless and, as a rule, of small size; among them are included such forms as the mushrooms, smuts, rusts and mildews, as well as the molds and yeasts. The bacteria are closely allied to this latter class. When first discovered they were thought to be animals because of the ability of some forms to move about in liquids.
The bacteria, like other kinds of living organisms, possess a definite form and shape. They are the simplest in structure of all the plants, the individual organism consisting of a single cell. The larger and more highly organized forms of life are made up of many microscopic cells, and the life of the individual consists of the work of all the cells. The bacteria are very comparable to the single cells of the higher plants and animals, but in the case of the bacteria the single cell is able to exist apart from all other cells and to carry out all of its life processes including reproduction.
Forms of bacteria. With the multicellular organisms much variation in form is possible, but with these single-celled organisms the possible variation in form is greatly limited. Three well marked types occur among the bacteria: the round or coccus form (plural cocci); the rod-shaped or bacillus (plural bacilli); and[Pg 9] the twisted or spirillum type (plural spirilla). Most organisms of special significance in dairying belong to the coccus or bacillus group.
Size of bacteria. The bacteria, as a class, are among the smallest of living objects. None of them are individually visible to the naked eye, and they can be so seen only when clumps or masses are formed in the process of growth.
 Fig. 1.—Forms of Bacteria.
Fig. 1.—Forms of Bacteria.While there is considerable relative variation in size, yet in actual dimensions, this difference is so small as to make careful microscopic determinations necessary. An average diameter may be taken as about one thirty-thousandth of an inch, while the length varies naturally several fold, depending upon whether the type under observation is a coccus or a bacillus.
It is very difficult to conceive of the minuteness of the bacteria; the following may give some idea of their size. In a drop of cream ready for churning may be found as many as 10,000,000 and in a piece of fresh cheese as large as a cherry there may be as many living bacteria as there are people on our earth. While the bacteria are very minute, the effect which they exert in milk and other dairy products is great on account of their enormous numbers.
Manner of growth. The cells of which all plants and animals consist increase in numbers by the division of[Pg 10] each cell into two cells through the formation of a division wall across the cell. The new cells divide and the plant or animal continues to grow. The same cell division occurs in the bacteria but since the bacteria are single celled, division of the cells means an increase in numbers rather than growth as in the higher forms of life.
 Fig. 2.—Division of Bacteria.
Fig. 2.—Division of Bacteria.In the case of those bacteria that have a greater length than diameter, the new wall is formed at right angles to the long axis of the cell. As soon as the division is complete each cell is a complete individual, capable of carrying on all of its life processes. The cells may, however, cohere and thus form distinctive groupings that may serve to identify certain types. Some of the cocci form long chains and the term streptococcus is applied to such. Other groupings may be similar to a bale of twine or they may be massed in clusters with no regularity distinguishable.
Spores. Just as ordinary plants form resistant structures, known as seeds, capable of retaining vitality under conditions unfavorable for growth thereby perpetuating the species, so with certain of the bacteria, definite structures, known as spores, that are analogous in some respects to the seeds of the higher plants, are produced within the mother cell. The spores are exceedingly resistant[Pg 11] to the influence of an unfavorable environment, such as heat, cold, drying, and even chemical agents. It is this property of the spores which makes it so difficult to destroy the bacterial life in the process of sterilizing milk. The property of spore-formation is fortunately confined to a comparatively small number of different species of bacilli.
Movement. Many of the bacteria are provided with vibratory organs of locomotion, known as cilia (singular cilium) which are variously distributed on the surface of the cell. By the movement of these relatively long, thread-like appendages the individual cell is able to move in liquids. It must be remembered, when these moving cells are observed under the microscope, that their apparent rate of movement is magnified relatively as much as their size.
Conditions for growth. All kinds of living things need certain conditions for growth such as food, moisture, air and a favorable temperature. The bacteria prefer as food such organic matter as milk, meat, and vegetable infusions. Those living on dead organic matter are known as saprophytes, while those which are capable of thriving in the tissues of the living plant or animal are known as parasites. Certain of the parasitic forms are capable of causing disease in plants and animals. In the first group are embraced most of the bacteria that are able to develop in milk or its products, such as those forms concerned in the spoiling of milk or its fermentation. It is true that milk may contain disease-producing bacteria coming either from a diseased animal or from a diseased human being. It is also true that some of such harmful forms are able to grow in milk, such as the organisms causing typhoid fever and diphtheria.
Food. The bacteria like all other plants must have their food in solution. Where they apparently live on solids, such as meats, fruits, etc., they dissolve the food substances before utilizing the same. If the solutions are highly concentrated, as in the case of syrups, preserves and condensed milk, the bacteria cannot readily grow, although all of the necessary food ingredients are present. When such concentrated solutions are diluted, bacterial growth will take place and the solutions will spoil.
 Fig. 3.—Photomicrograph of Lactic Acid Bacteria.
Fig. 3.—Photomicrograph of Lactic Acid Bacteria.Generally speaking the bacteria grow best in a neutral or slightly alkaline solution rather than in acid liquids.
Temperature. One of the most important conditions influencing the rate of growth of bacteria is the temperature. Each form has a minimum temperature[Pg 13] below which growth can not take place; also a maximum above which growth is again impossible. For the majority of species the minimum temperature ranges from 40 to 45° F. the maximum from 105 to 110° F. Growth takes place most rapidly at the optimum temperature, which, for each species, lies close to the maximum temperature at which growth can occur. Most of the bacteria of importance in the dairy grow well at from 70 to 100° F.
There are forms that can grow below the freezing point of water when they are in solutions that do not freeze at this temperature. There are still other bacteria that can grow at 140° F. a temperature that is quickly fatal to most forms. These are of importance in the dairy since they limit the temperatures at which milk can be stored for long periods of time.
Air supply. Living organisms, both plant and animal, require air or oxygen for the combustion of their food and for the production of energy. Most bacteria use, as do the green plants and animals, the free oxygen of the air for their respiration. Such organisms are called aerobic or air-living. A much smaller group possess the power of taking oxygen from organic compounds such as sugar and the like and therefore are able to live under conditions where air is excluded. These are called anaerobic bacteria. A large number of bacteria are able to live either in the presence or in the absence of free oxygen. Most of the bacteria of importance in the dairy are of this nature.
Rate of growth. When there is an abundant supply of food and when the temperature conditions are favorable, the bacteria increase in numbers with astounding rapidity. It has been determined by actual experiment[Pg 14] that the process of cell division under favorable conditions takes place in a few moments. Barber has shown that one of the forms of bacteria constantly found in milk will divide in 17 minutes at 98° F. and that a single organism kept at this temperature for ten hours would increase to 1,240,000,000. If the temperature is reduced to 50° F., the time required for division is increased to several hours. The explanation for the rapid spoiling of milk that is not well cooled is thus apparent. The initial rapid rate of increase cannot be maintained for any length of time as the conditions become more and more unfavorable as growth continues, due to the accumulation of the by-products of the cell activity. Thus, the growth of acid-forming organisms in milk becomes checked by the formation of acid from the fermentation of the sugar.
Detrimental effect of external conditions. Environmental conditions of a detrimental character are constantly at work tending to repress the activity of bacteria or to destroy them. These act more readily on the vegetating cells than on the more resistant spores. It is of the utmost importance that those engaged in dairy work be familiar with these antagonistic forces since it is constantly necessary to repress or to kill outright the bacteria in milk and other dairy products. In many lines of dairy work it is likewise important to be familiar with the conditions favorable for bacterial growth.
Effect of cold. While it is true that chilling largely prevents fermentative action, and actual freezing stops all growth processes, still it does not follow that exposure to low temperatures will effectually destroy the vitality of bacteria, even in the growing condition. Numerous non-spore-bearing species remain alive in ice[Pg 15] for a prolonged period, and experiments with liquid air show that even a temperature of-310° F. maintained for hours does not kill all exposed cells.
Effect of heat. High temperatures, on the other hand, will destroy any form of life, whether in the vegetative or latent spore stage. The temperature at which the vitality of the cell is lost is known as the thermal death point. This limit is dependent not only upon the nature of the organism, but upon the time of exposure and the condition in which the heat is applied. In a moist atmosphere, the penetrating power of heat is great, consequently cell death occurs at a lower temperature than in a dry atmosphere. An increase in time of exposure lowers the temperature point at which death occurs.
For growing organisms, the thermal death point of most species ranges from 130° to 140° F. for ten minutes. When spores are present, resistance is greatly increased, some forms being able to withstand steam at 212° F. from one to three hours. In the sterilization of milk, it is often necessary to heat for several hours, where a single exposure is made, to destroy the resistant spores, that seem to be more abundant under summer than winter conditions. Steam under pressure is a much more effective agent, as the temperature is thus raised considerably beyond 212° F. An exposure of twenty minutes, at a temperature of 230° to 240° F. will kill all spores. Where heat is used in a dry state, it is much less effective, a baking temperature of 260° to 300° F. for an hour being necessary to kill spores. This condition is of the utmost importance in the destruction of bacteria in the dairy and creamery.
Effect of drying. The spore-bearing bacteria withstand [Pg 16]effects of desiccation without serious injury, and many of the non-spore-producing types retain their vitality for some months. The bacteria found in the air are practically all derived from the soil, and exist in the air in a dried condition, in which they are able to remain alive for considerable periods of time. In a dried condition, active cell growth is not possible, but when other conditions, such as moisture and food supply are present, resumption of growth quickly begins. This property is also of importance in the dairy as in the preparation of dry starters for creameries and cheese factories.
Effect of light. Bright sunlight exerts a markedly injurious effect on bacterial life, both in a spore and in a growing condition. Where the direct sunlight strikes, more or less complete disinfection results in the course of a few hours, the effect being produced by the chemical or violet rays, and not by the heat or red rays of the spectrum. This action, however, does not penetrate opaque objects, and is therefore confined to the surface. In diffused light, the effect is much lessened, although it is exerted to some extent. Sunlight exerts a beneficial effect on the general health and well-being of animal life, and is a matter of importance to be taken into consideration in the erection of buildings for animals as well as for people.
Effect of chemicals. A great many chemical substances exert a more or less powerful toxic action on various kinds of life. Many of these are of great service in destroying bacteria or holding them in check. Those that are toxic and result in the death of the cell are known as disinfectants; those that merely inhibit, or retard growth are known as antiseptics. All disinfectants[Pg 17] must of necessity be antiseptic in their action, but not all antiseptics are disinfectants, even when used in large amounts. Disinfectants have no place in dairy work, except to destroy disease-producing bacteria, or to preserve milk for analytical purposes. The so-called chemical preservatives used to "keep" milk depend for their effect on the inhibition of bacterial growth. In this country, most states prohibit the use of these substances in milk. Their only function in the dairy should be to check fermentative and putrefactive processes outside of milk and so keep the air free from taints.
Products of growth. All bacteria, as a result of their growth in food substances, form more or less characteristic compounds that are known as by-products. The changes brought about are those of decomposition and are collectively known as fermentations; they are characterized by the production of a large amount of by-products as the result of the development of a relatively small amount of cell life. The souring of milk, the rotting of eggs, the spoiling of meats, the making of vinegar from cider are examples of fermentations caused by different bacteria.
If the substances decomposed contain but little sugar, as do animal tissues, the conditions are favorable for the growth of the putrefactive bacteria, and foul-smelling gases are formed. When sugars are present, as in milk, the environmental conditions are most favorable for the acid-forming bacteria that do not as a rule produce offensive odors.
Many of the bacteria form substances known as enzymes which are able to produce certain decomposition changes in the absence of the living cells, and it is by virtue of these enzymes that the organisms are able to[Pg 18] break down such enormous quantities of organic matter. Most of these enzymes react toward heat, cold, and chemical poisons in a manner quite similar to the living cells. In one respect, they are readily differentiated, and that is, that practically all of them are capable of producing their characteristic chemical transformations under conditions where the activity of the cell is wholly suspended as in a saturated ether or chloroform atmosphere. The production of enzymes is not confined to bacteria, but they are found throughout the animal and plant world, especially in those processes that are concerned in digestion. Rennet, used in cheese making, is an example of an animal enzyme.
Distribution of bacteria. As bacteria possess greater powers of resistance than almost any other form of life, they are found very widely distributed over the surface of the earth. In soil they are abundant, because of the fact that all of the conditions necessary for growth are here best satisfied. They are, however, distributed with reference to the layers of the soil; the soil proper, i.e., that turned over by the plow, is extremely rich in them on account of the abundance of organic matter. But at the depth of a few feet they decrease rapidly in numbers, and in the deeper layers, from six to ten feet, or more, they are normally not present, because of the lack of proper food supply and oxygen. The fertility of the soil is closely associated with their presence.
The bacteria are found in the air because of their development in the soil below. They are unable to grow even in a moist atmosphere, but are so readily dislodged by wind currents from the soil that over land areas the lower strata of the air always contain them. They are more numerous in summer than in winter; city air contains [Pg 19]larger numbers than country air. Wherever dried fecal matter is present, as in barns, the air contains many forms.
Water generally contains enough organic matter in solution, so that certain types of bacterial life find favorable growth conditions. Water in contact with the soil surface takes up many impurities, and is of necessity rich in bacteria. As the rain water percolates into the soil, it loses its germ content, so that the normal ground water, like the deeper soil layers, contains practically no bacterial life. Springs, therefore, are relatively deficient in germ life, except as they become contaminated with soil organisms, as the water issues from the ground. Wells vary in their germ content, depending upon manner of construction, ease of contamination at surface, etc. Wells are too frequently insufficiently protected from surface leachings, and consequently may contain all kinds of organisms found in the surface soil. Typhoid fever is very frequently disseminated in this way, as is cholera and a number of animal maladies.
While the inner tissues of healthy animals are free from bacteria, the natural passages, as the respiratory and digestive tracts, being in more direct contact with the exterior, become readily infected. This is particularly true with reference to the intestinal tract, and in the undigested residue of the food, bacterial activity is at a maximum. The result is that fecal matter of all kinds contains enormous numbers of organisms so that the pollution of any food medium, such as milk, with such material is sure to introduce elements that seriously affect its quality.
METHODS OF STUDYING BACTERIA.
Necessity of artificial cultivation. The bacteria are so extremely small, that it is impossible to study individual germs separately without the aid of powerful microscopes. Little advance was made in the knowledge of these lower forms of plant life until the introduction of culture methods, whereby a single organism could be cultivated, and the progeny of this cell increased to such an extent in a short course of time that the resulting mass of cells would be visible to the unaided eye. This is done by growing the bacteria on various kinds of nutrient media that are prepared for the purpose, but inasmuch as bacteria are so universally distributed, it becomes an impossibility to cultivate any special form alone, unless the medium in which they are grown is first freed from all pre-existing forms of germ life.
Food materials. Many kinds of food substances are used for the cultivation of bacteria in the laboratory. In fact, bacteria will grow on almost any organic substance, whether it is solid or liquid, provided the other essential conditions of growth are furnished. The food substances that are used for culture purposes are divided into two classes,—solids and liquids.
Solid culture media may be either permanently solid, like potatoes and coagulated egg, or they may retain their solid properties only at certain temperatures, like gelatin or agar. The latter two, which were devised by Robert Koch, are of utmost importance in bacteriological [Pg 21]research, for their use permits the separation of the different forms of bacteria that may happen to be in any mixture. Gelatin is advantageously used, because the majority of bacteria present wider differences, due to growth upon this medium, than upon any other. It remains solid at ordinary temperatures, becoming liquid at about 80° F. Agar, a gelatinous product derived from a Japanese seaweed, has a much higher melting point, and is used especially with those organisms whose optimum temperature for growth is above the melting point of gelatin.
Besides these solid culture media, different liquid substances are extensively used, such as beef broth, milk and infusions of various vegetable and animal tissues. Skim milk is of especial value in studying the milk bacteria, and may be used in its natural condition, or a few drops of litmus solution may be added, in order to detect any change in its chemical reaction due to the bacteria.
Sterilization. The various ingredients that are used in the preparation of culture media are not free from micro-organisms, hence the media would soon spoil if they were not destroyed, and the media subsequently protected from contamination from the air, etc. The process of rendering the media free from living micro-organisms is known as sterilization. It may be accomplished in a number of ways, but most often is done by the use of heat. For culture material, which is always organic in character, moist heat is employed. The various culture media, in appropriate containers, are subjected to a thorough steaming in a steam cooker. This destroys all of the vegetating cells but not the resistant spores that may be present. The media are then stored,[Pg 22] for twenty-four hours, at temperatures favorable for the germination of the spores and are then again heated. Three such applications on successive days are usually sufficient to free the media from all living germs, since between the heating periods the spores germinate and the resulting vegetative cells are more easily destroyed. The sterile media will keep for an indefinite period in a moist place.
The media are usually placed in glass containers which may be sterilized before use by heating them in an oven, it being possible to thus secure a much higher temperature than with streaming steam. All glass or metal articles may be sterilized by the use of dry heat but for organic media, to avoid burning, moist heat must be used.
All kinds of materials may be sterilized by treatment with steam under pressure. An exposure for a few moments at 250° F., a temperature attained with 15 pounds steam pressure, will destroy all kinds of bacteria and their spores. This method of sterilization is used in the canning of meats and vegetables and in the preparation of evaporated milk. To avoid contamination of the media after sterilization, the flasks and tubes are, after being filled, stoppered with plugs of cotton-wool, which effectually filter out all bacteria and mold spores from the air, and yet allow the air to pass freely in and out of the containers.
Methods of determining the number of bacteria. The method of determining the number and kinds of bacteria in any substance can be illustrated by the process as applied to milk. For this purpose the method of procedure is as follows: Sterile gelatin in glass tubes is melted and then cooled until it is barely warm.[Pg 23] To this melted gelatin a definite quantity of milk is added. The medium is gently shaken, so as to thoroughly mix the milk and gelatine, and the mixture then poured into a sterile, flat, glass dish, and quickly covered, where it is allowed to cool until the gelatin hardens. After the culture plate has been left for twenty-four to thirty-six hours at the proper temperature, tiny spots will begin to appear on the surface, or in the depth of the culture-medium. These spots are called colonies, and are composed of an almost infinite number of individual[Pg 24] cells, the result of the continued growth of a single organism that was in the drop of milk and which was firmly held in place when the gelatin solidified. The number of these colonies represents approximately the number of living bacteria that were present in the amount of milk added to the tube of gelatin. If the plate is not too thickly sown with the bacteria, the colonies will continue to grow and increase in size, and as they do, minute differences will begin to appear. These differences may be in the color, the contour, and the texture of the colony, or the manner in which it acts toward gelatin.
 Fig. 4.—Plate Culture.
Fig. 4.—Plate Culture.In order to make sure that the number of colonies is not so numerous as to prevent counting and further study of their characteristics, a series of plate cultures is usually made in which varying amounts of milk are added to the tubes of gelatine. This is attained by adding a definite amount of the milk or other substance to be examined to a measured amount of sterile water, e.g., one cubic centimeter of milk to ninety-nine cubic centimeters of water. One cubic centimeter of this mixture may be used for the inoculation of the plate culture. This dilution may be carried on to any desired extent; in the examination of many dairy products, it is necessary to use very minute quantities of material, often only one one-millionth of a cubic centimeter.
To study further the peculiarities of the different bacteria, small portions of the individual colonies are transferred to tubes of sterile culture-media. In order to do this the colony is touched with a piece of platinum wire; the minute amount of growth that adheres to the wire is sufficient to seed the tube of fresh culture-medium. The inoculating needle must always be sterilized before use by passing it through a gas flame.
A culture thus obtained is called a pure culture since it contains but a single kind of an organism, as the colony is the result of the growth of a single cell. These cultures then serve as a basis for continued study, and must be planted and grown upon the different kinds of media that are obtainable. In this way the slightest variations in the growth of different forms are detected, and the peculiar characteristics are determined, so that the student is able to recognize this form when he meets it again.
 Fig. 5.—Different Kinds of Bacteria Growing in Gelatin.
Fig. 5.—Different Kinds of Bacteria Growing in Gelatin.These culture methods are of essential importance in[Pg 26] bacteriology, as it is the only way in which it is possible to secure a quantity of germs in a pure state.
The microscope in bacterial investigations. In order to verify the purity of the cultures, the microscope is in constant demand throughout all the different stages of the isolating process. For this purpose it is essential that the instrument used shall be one of high magnifying powers (600 to 800 diameters), combined with sharp definition.
The microscopical examination of any germ is quite as essential as the determination of culture characteristics, in fact, the two must go hand in hand. The examination reveals not only the form and size of the individual germs but the manner in which they are united with each other, as well as any peculiarities of movement that they may possess.
In carrying out the microscopical part of the work, not only is the organism examined in a living condition, but colored preparations are made by using solutions of anilin dyes as staining agents. These are of great service in bringing out almost imperceptible differences. The art of staining has been carried to the highest degree of perfection in bacteriology, especially in the detection of germs that are found in diseased tissues in the animal or human body.
In studying the peculiarities of any special organism, not only is it necessary that these cultural and microscopical characters should be closely observed, but special experiments must be made in different ways, in order to determine any special properties that the germ may possess. Thus, the ability of any form to act as a fermentative organism can be tested by fermentation experiments; the property of causing disease, studied[Pg 27] by the inoculation of pure cultures into experimental animals, like rabbits, guinea pigs and white mice.
The methods of the bacteriologist in his laboratory are in their effect not dissimilar to those which the farmer employs in securing his crop of pure-bred grain. The laboratory farmer kills the weed seeds in his culture field by the application of heat. His field, which is embraced in his culture dish, has been fertilized and prepared by the addition of certain favorable ingredients. When he has garnered his crop, he maintains its purity by keeping his selected seed, the pure culture, free from all contamination. The dairyman, even though he may not expect to carry on the detailed operations of the laboratory, will understand the reason for the directions which he is often required to follow much better if he knows how the simple operations of the laboratory are carried out. For a fuller knowledge of these matters, the reader is referred to the special texts on bacteriology.
CONTAMINATION OF MILK.
Spoiling of milk. Materials of animal origin are peculiarly prone to undergo changes, rendering them unfit for use, and of these, milk is exceedingly susceptible to such changes. This is due to the fact that the composition of milk is especially adapted to bacterial growth, and that the opportunity for entrance of such organisms is likewise such as to permit of abundant contamination. The consequence is that milk readily undergoes fermentative changes, due to the development of one or another type of micro-organism.
Milk, a suitable bacterial food. While milk is designed by nature for the nourishment of mammalian life, it is, curiously enough, equally well adapted to the growth of these lowest forms of vegetable life. The nutritive substances required by bacteria are here sufficiently dilute to make possible rapid growth.
Milk also contains all the necessary chemical substances to make a suitable bacterial food supply. Of the nitrogenous compounds, albumen is in a readily assimilable form. Casein, the principal nitrogenous constituent of milk, exists in an insoluble condition, and cannot be directly utilized, until it is acted upon by digesting enzymes. The fat in milk does not readily decompose, and while there are a few bacteria capable of splitting this substance, the majority of organisms are[Pg 29] unable to utilize it. Milk sugar, on the other hand, is an excellent food for most species.
 Fig. 6.—Fat Globules and Bacteria.
Fig. 6.—Fat Globules and Bacteria.Sources of contamination. Inasmuch as milk is especially exposed to the inroads of bacterial growth, and because of the fact that much of the contamination can easily be prevented, it is highly important that the milk producer and dealer should be thoroughly cognizant of the various sources of contamination. The different factors concerned in contamination may be grouped as follows: the interior of the udder; utensils, including all apparatus with which the milk is brought in contact subsequent to withdrawal from the animal; infection coming from the animal herself, from the milker, and the surrounding air.
Condition of milk when secreted. Immediately after withdrawal from the udder, milk always contains bacteria,[Pg 30] yet in the secreting cells of the udder of a healthy cow, germ life does not seem to be present. Only when the gland is diseased are bacteria found in any abundance. In the passage of the milk from the secreting cells to the outside, it receives its first infection, so that when drawn from the animal it generally contains a considerable number of organisms.
A study of the structure of the udder shows the manner in which such infection occurs.
Structure of the udder. The udder is composed of secreting tissue (gland cells) that is supported by fibrous connective tissue. The milk is elaborated in these cells and is discharged into microscopic cavities, from whence it flows through the numerous channels (milk sinuses) that ramify through the substance of the udder, until finally it is conveyed into the milk cistern, a common receptacle holding about one half pint that is located just above the teat. This cavity is connected with the outside by a direct opening (milk duct) through the teat. During the process of milking, the milk is elaborated rapidly in the gland cells, and their contents upon rupture of the milk cells, flow down into the cistern. The normal contraction of the muscles at the lower opening of the outer duct prevents the milk from passing out except when pressure is applied, as in milking. The inner walls of the milk duct and cistern are always more or less moist, and therefore afford a suitable place for bacteria to develop, if infection once occurs, and conditions are favorable for growth.
Manner of invasion. Two possible sources of invasion of the udder by bacteria may exist. If bacteria are present in the circulating blood, there is the possibility of organisms passing directly through the tissues into[Pg 31] the milk-secreting cells. The other alternative is the possible direct contamination from the outside by organisms passing up through the milk duct, and so spreading through the open channels in the udder.
 Fig. 7.—Sectional View of Udder.
Fig. 7.—Sectional View of Udder.Number of bacteria in fore-milk. If a bacteriological examination is made of the milk drawn from each teat at different periods during the milking process, it will be found that the fore-milk, i.e., the first few streams,[Pg 32] contains, as a rule, many more organisms per cubic centimeter than that removed later. Not infrequently thousands of organisms per cubic centimeter may be found in the first streams while the middle milk, or strippings, will contain much smaller numbers.
Distribution and nature of bacteria in udder. If the udder itself is carefully examined as to its bacterial content, it appears that the majority of organisms found is confined to the lower portion of this organ, in the teat, milk-cistern and large milk-ducts; while bacteria occur in contact with the secreting tissue, they are relatively less abundant. This would seem to indicate that the more probable mode of infection is through the open teat.
While there is no constant type of bacteria found in the fore-milk, yet it is noteworthy that nearly all observers agree that the organisms most commonly found are not usually the acid-producing, or gas-generating type, so abundant on the skin or hairy coat of the udder and which predominate in ordinary milks. Coccus forms, belonging to both liquefying and non-liquefying types are most generally present. Many of these produce acid slowly and in small quantities.
The bacteria coming from the interior of the udder are of small practical significance since they do not grow rapidly at the temperatures at which milk is stored. If the milk is protected from contamination from other sources, the bacteria from the udder will ultimately cause it to spoil, but under ordinary conditions other forms are present in such greater numbers, and grow so much more rapidly in milk, that the udder forms have small opportunity to exert any effect.
It is interesting to note that the bacteria found in the[Pg 33] udder are similar to those that seem to be most abundant in such glandular tissues as the liver and spleen. This fact increases the probability that these comparatively inert coccus forms of the udder may originate directly from the blood stream. The organisms that normally are found in the udder exert no harmful effects on the gland. It might be thought that due to the presence of abundant food and a favorable temperature that growth would be abundant, but such is not the case. At times the udder may be invaded by forms that are not held in check by the natural factors and an inflammation of the udder is likely to result.
Germicidal property of milk. It has been claimed that freshly drawn milk, like other body fluids, possesses germicidal properties, i.e., the power of destroying bacteria with which it may be brought in contact. If milk is carefully examined bacteriologically, hour by hour, after it is withdrawn from the udder, it will generally be found that there is at first not only no increase in number of organisms during a longer or shorter period when it is kept at temperatures varying from 40° to 70° F., but that an actual reduction not infrequently takes place. When cultures of bacteria, such as B. prodigiosus, a red organism, lactic acid organisms, and even the yellow, liquefying coccus, so commonly found in the fore-milk, are artificially introduced into the udder, it has been found that no growth occurs and that in the course of a few days the introduced organisms actually disappear. Whether this failure to colonize can be regarded as evidence of a germicidal property or not is questionable. In fact, this question is a matter of but little practical importance in the handling of milk since, under the best of conditions, the keeping quality of the[Pg 34] milk is not materially enhanced. It may be of importance in inhibiting growth in the udder.
Rejection of fore-milk. The fact that the fore-milk contains per cubic centimeter so much more germ life than the remainder of the milk has led some to advocate its rejection when a sanitary milk supply is under consideration. While from a purely quantitative point of view, this custom may be considered advantageous, in practice, however, it is hardly worth while since it is not at all certain that the rejection will have any effect on the keeping quality or healthfulness of milk. This is especially true if the ends of the teats are thoroughly cleaned before milking. It is true that the fore-milk is relatively deficient in fat so that the loss of butter fat occasioned by the rejection of the first few streams is comparatively slight.
Contamination from utensils. One of the most important phases of contamination is that which comes from the utensils used to hold the milk from the time it is drawn until it is utilized. Not only is this important because it is a leading factor in the infection of milk, but because much improvement can be secured with but little trouble, and it is especially necessary that the dairy student should be made familiar with the various conditions that obtain. Pails and cans used to hold milk may be apparently clean to the eye, and yet contribute materially to the germ content of the milk placed in them. Not only does much depend upon their condition, but it is equally important to take into consideration their manner of construction. Dairy utensils should be simple in construction, rather than complex. They should be made so that they can be readily and[Pg 35] easily cleaned, or otherwise the cleaning process is apt to be neglected.
Of first importance are those utensils that are used to collect the milk and in which it is handled while on the farm. The warm milk is first received in pails, and unless these are scrupulously cleaned, an important initial contamination then occurs. As ordinarily washed, the process falls far short of ridding the utensils of the bacterial life that is adherent to the inner surface of the pail. Then, too, all angles or crevices afford an excellent hiding place for bacteria, and it is very important to see that all seams are well soldered. Round corners and angles flushed with solder greatly facilitate thorough cleaning of utensils. Tin utensils are recognized as most satisfactory.
Shipping cans are likely to serve as greater infecting agents than pails for they are subject to more wear and tear and are harder to clean. As long as the surface is bright and smooth, it may be easily cleaned, but large utensils, such as cans, are likely to become dented and rusty in spots on the inner side. The storage of milk in such utensils results in its rapid deterioration. The action of rennet has been found to be greatly retarded where milk comes in contact with a rusty iron surface. It is also probable that some of the abnormal flavors in butter are due to the action of acid cream on iron or copper surfaces from which the tin has been worn. It is equally important that attention be paid to the care of strainers, coolers, and the small utensils. Cloth strainers are more or less of a hotbed for bacterial growth, for unless they are boiled, and then dried quickly and thoroughly, germ growth will continue apace in them, as long as they contain any moisture.
Milking machines and farm separators. The introduction of these special types of dairy machinery in the handling of milk on the farm has materially complicated the question of the care of milk. Both of these types of apparatus are much more complicated than the usual milk utensil; consequently, the danger of imperfect cleaning is thereby increased. This is still further accentuated by the fact that cleansing of utensils on the farm can never be done so well as at the factory or milk depot where steam is available. The milking machine may be easily kept in a comparatively germ-free condition, but unless this is done, it contributes its quota of germ life to the milk.
The farm separator is more widely used than the milking machine and in actual practice the grossest carelessness prevails in the matter of its care. Frequently it is not taken apart and thoroughly cleansed, but is rinsed out by passing water through the machine. It is impossible by such a treatment to remove the slime that collects on the wall of the bowl; the machine remains moist and bacterial growth can go on. Such a machine represents a most important source of contamination of milk and cream and it is probable that the widespread introduction of the hand separator has contributed more to lower the quality of cream delivered at the factory than any other single factor.
Contamination from factory by-products. The custom of returning factory by-products in the same set of cans that is used to bring fresh milk is a prominent cause of bad milk. Whey and skim milk are rich in bacterial life, and not infrequently are so handled as to become a foul, fermenting mass. If the cans used to transport this material are not scrupulously cleaned on the[Pg 37] farm, transfer of harmful bacteria to the milk is made possible. In this way the carelessness of a single patron may be the means of seeding the whole factory supply. This custom is not only liable to produce a poor quality of milk, but it is more or less of a menace to all the patrons of a factory, inasmuch as the opportunity always obtains that disease-producing organisms may thus be introduced into the supply. Not infrequently is tuberculosis thus spread through the medium of factory by-products.
 Fig. 8.—Whey Disposal.
Fig. 8.—Whey Disposal.The manufacture of Swiss cheese presents a striking example of the disregard which factory operators show toward the employment of bacteriological principles. In these factories, the custom is widely practiced of apportioning the patrons' allotment of whey into individual[Pg 38] barrels which are supposed to be emptied each day. As these barrels are, however, rarely ever cleaned from the beginning to the end of the season, they become very foul, and the whey placed in them from day to day highly polluted. It is this material which is taken back to the farms in the same set of cans that is used for the fresh milk. When one recalls that the very best type of milk is essential for the making of a prime quality of Swiss cheese, and that to secure such, the maker insists that the patron bring the product to the factory twice daily, the before mentioned practice appears somewhat inconsistent.
Treatment of factory by-products. To overcome the danger of infecting milk from factory by-products with either undesirable fermentative organisms, or disease-producing bacteria, the most feasible process is to destroy these organisms by the application of heat. In Denmark, some portions of Germany, and in some of the states in this country, laws exist which require the heating of all skim milk before it is returned to the farm. This is done by the direct use of exhaust steam, or running the product through heaters.
The treatment of whey in cheese factory practice is especially important since the warm whey must be stored for a number of hours before it is returned to the farms. Even under the best of conditions the whey is certain to be in an advanced state of fermentation when placed in the milk cans, and it only needs the infection of the whey tank with harmful bacteria to cause great loss on account of the injury of the product by these bacteria. Among Canadian factories the custom of heating the whey as it passes from the cheese vat to whey tank has been introduced, and where ever adopted has been retained,[Pg 39] because, it has resulted in such an improvement of the cheese that the gain was much greater than the cost, which is estimated at not over fifty cents per ton of cheese. The whey is heated not to exceed 155° F.; the hot whey serves to scald the whey tank and as the mass of whey is usually quite large, it does not cool to a point where bacterial growth can take place for a number of hours. The whey is thus quite sweet when returned to the farm and has greater feeding value. The heating also prevents the creaming of the whey in the tank and thus avoids the soiling of the cans with grease which is most difficult to remove.
Where compulsory legislation is in force it is generally required that these by-products be heated to a temperature of at least 176° F. This is done so as to destroy effectually the organisms of tuberculosis, and especially to permit of the utilization of the so-called Storch test,[1] which enables a person to determine quickly whether milk or whey has been heated or not.
[1] Storch (40 Rept. Expt. Stat., Copenhagen, 1898) has devised a test whereby it can be determined whether this treatment has been carried out or not; milk contains a soluble enzyme known as peroxidase which has the property of decomposing hydrogen peroxid. If milk is heated to 176° F., (80° C.) or above, this enzyme is destroyed, so that the above reaction no longer takes place. If potassium iodide and starch are added to unheated milk and the same treated with hydrogen peroxid, the decomposition of the latter agent releases oxygen which acts on the potassium salt, which in turn gives off free iodine that turns the starch blue.
Cleaning utensils. Various processes are applied to dairy utensils to cleanse them. In removing visible dirt and foreign matter, much of the bacterial life is mechanically[Pg 40] eliminated, but most of the cleaning processes fail to destroy the germ life in these utensils.
In rinsing, washing, or even scalding, the water is not applied at a sufficiently high temperature to destroy effectively the bacteria. These processes are primarily used for the removal of dirt and other matter. To facilitate such removal, washing powders of various kinds are frequently employed; some of these possess considerable disinfecting action. All utensils after cleansing should be thoroughly rinsed in clean, hot water. Even where no further treatment is given, a careful cleaning may so reduce the germ content on the inner surface of utensil as to render contamination therefrom relatively unimportant. Most of the contamination in a well cleaned utensil comes from the cracks and angles, which permit of the collection of the dirt. If these are properly attended to, thorough cleaning and rinsing alone will accomplish much.
To exert an actual germ-destroying effect on the bacterial content of the utensil, resort must be had to boiling or steaming. To treat utensils so as to render them wholly germ-free would be impractical under ordinary commercial conditions, as it would consume too much time, although with proper apparatus, this process is not impossible, but it is well within the limits of practicability in factory treatment to apply steam for a short period of time. Where cans, pails and such utensils, are steamed for a minute or so after being thoroughly cleaned, the germ content is greatly reduced. In a series of tests by Harrison, the germ content of a set of cans cleaned in an ordinary way was 442,000 bacteria per cubic centimeter in 100 cubic centimeters of wash water; in a set washed in tepid water and then scalded—the best farm practice—it was 54,000 per cubic centimeter,[Pg 41] while in cans carefully washed and then steamed for 5 minutes, it was reduced to 880 per cubic centimeter. It would not be worth while to institute measures that would accomplish the destruction of this small residual content.
The use of steam, therefore, is of great service in eliminating bacterial life in all utensils. In apparatus of at all complicated design, it is absolutely necessary. Of course, ordinarily, steam can be applied only at the factory, as the farm does not usually afford facilities for its easy generation. This fact has led in some cases to the adoption of the method of cleaning and sterilizing the cans at the factory rather than to await their arrival at the farm. This custom is most frequently followed in milk supply plants.
It is also very important in cleaning dairy utensils to see that they are rapidly and thoroughly dried after being washed and steamed. As pointed out above, the short period of steaming that can be followed in practice does not kill all the bacteria. If moisture is retained, conditions permit of the growth of the undestroyed organisms. Tests made on glass milk bottles showed that considerable growth occurred in the condensation water even after quite thorough sterilization. Some of the devices used for the sterilization of such utensils as milk cans are so arranged that, after steam has been introduced, hot air is passed into the can until it is thoroughly dried. Other utensils such as cloth strainers become sources of contamination unless the articles are thoroughly and quickly dried after cleaning.
In a general way, it may be said that whenever a utensil is so constructed and in such a condition that every portion of its surface can be reached by a cloth or a[Pg 42] brush, it can be kept in a sanitary condition. But whenever any portion cannot be thus reached, whether it is an angle or a seam in a pail or can, the interior of the separator bowl, or in the pipes used for conducting milk, contamination is certain to result from such places, unless extreme care is taken to destroy the bacteria therein by steaming.
Contamination from the animal. In the process of milking, the bacterial content of the milk is materially increased. In part this comes from the utensils into which the milk is drawn, but the animal herself, the milker, as well as the surrounding air, also contribute to a varying extent. Of these factors, the one fraught by far with the most consequence, is the influence of the animal herself. It is a popular belief that the organisms found in milk are derived from the feed and water which the animal consumes, but under normal conditions, the bacteria consumed in food pass through the intestinal canal and do not appear in the circulation. It must not be assumed, however, that the character of feed and water supply is of no moment. Stock should be given pure and wholesome water and no decomposed or spoiled food should be used.
The infection traceable directly to the cow is modified materially by the conditions under which the animal is kept and the character of the feed consumed. The nature of the fecal matter is in part dependent upon the character of the food. The more nitrogenous the ration fed, the softer are the fecal discharges, producing a condition which is more likely to soil the coat of the animal unless care is taken. The same is true with animals kept on pasture in comparison with those fed dry fodder.
Stall-fed animals, however, are more likely to have their flanks fouled, unless special attention is paid to the removal of the manure. All dairy stalls should be provided with a manure drop which should be cleaned as frequently as circumstances will permit.
 Fig. 9.—Bacteria on Hairs.
Fig. 9.—Bacteria on Hairs.The animal contributes materially to the quota of germ life finding its way into the milk through the dislodgment of dust and filth particles adhering to its hairy coat. The nature of this coat is such as to favor the retention of these particles. Unless care is taken, the flanks and udder become polluted with fecal matter, which upon drying is displaced with every movement of the animal. Every hair or dirt particle so dislodged and finding its way into the milk-pail adds its quota of organisms to the liquid. This can be readily demonstrated[Pg 44] by placing cow's hairs on the moist surface of gelatin culture plates. Almost invariably bacteria will be found in considerable numbers adhering to such hairs, as is indicated in Fig. 9.
Dirt particles are even richer in germ life. Not only is there the dislodgment of hairs, epithelial scales, and masses of dirt and filth, but during the milking process, as at all other times, every motion of the animal is accompanied by a shower of invisible particles, more or less teeming with bacterial life. All of this material contains organisms that are more or less undesirable in milk. Bacteria concerned in gassy fermentations and those capable of producing obnoxious taints are particularly common, so that this type of pollution is especially undesirable in milk.
Amount of dirt in milk. When one remembers that the larger part of fresh manure is of such a nature that it does not appear as sediment, the presence of evident filth in milk must bespeak careless methods of handling.
The sediment or dirt test is used quite extensively to ascertain the amount of dirt milk may contain. By means of a cotton filter, the insoluble residue is removed and is made evident upon a layer of absorbent cotton. Milk that would show with difficulty any evidence of dirt upon ordinary examination reveals such defects very readily in this test.
Exclusion of dirt. It is better to keep bacteria out of milk, so far as practicable, rather than to attempt to remove them after they have once gained entrance. As is usual, prevention of trouble is much more easily accomplished than removing the difficulty after it once occurs.
 Fig. 10.—Dirt from Milk.
Fig. 10.—Dirt from Milk.Much reduction as to the amount of dirt that finds its way into milk may be accomplished by improved stable environment. The fouling of the udder and flanks comes from wading in dirty water, muddy yards, and from improper type of stalls. Barnyards are often a disgrace through the accumulation of manure and seepage. Cows wading in such mire cannot but accumulate mud and filth to a material degree on the teats and udder. Greater care as to drainage of the barnyard and the paving of same with gravel, cinders, etc., will permit of its being kept clean, and so prevent the fouling of animals. But more important than the yard is the stall[Pg 46] which the animal occupies in the stable. The essential feature is to have a stall of such construction as to keep the animal out of her own manure when she lies down. To accomplish this, it is necessary to have a manure drop behind the stall proper so that the feces and urine are kept out of the bed of the stall as much as possible.
 Fig. 11.—The Model Stall.
Fig. 11.—The Model Stall.Most of the stalls widely advertised in the farm press seek to accomplish this in one way or another, usually by some arrangement by which the cow is forced back when standing and drawn forward on lying down. In Fig. 11 a type of stall is illustrated that accomplishes this most successfully; the essential feature being a 2×3-inch wood strip nailed to the stall floor immediately in front of the hind feet of the animal when in a standing position. When the animal lies down, she crowds forward to avoid lying on this strip, and thus is out of[Pg 47] contact with the manure, except such as is carried onto the bedding by the hind feet. By the use of this stall it is possible to keep the animals free from all accumulations of manure.
Effort should be made to prevent fouling of the animals rather than in cleaning them after once soiled. It is very evident that where the cattle come to the milker with muddy udders, they will not be so cleaned before milking as to prevent a large amount of such dirt from entering the milk. However, when all that can be done towards keeping the cows clean has been accomplished, a small amount of grooming will greatly reduce the contamination coming from them.
The kind of bedding used in the stalls may have a marked influence on the contamination coming from the animal. If the straw is dusty, partially rotten and moldy, the bacteria and molds adhere to the coat of the animal and are thus introduced into the milk. In the case of cattle on pasture, no visible evidences of dirt are usually present but the hair is covered with the dust coming from the soil. There is very good reason to believe that the quality of milk is influenced by the type of pasture on which the cows graze, due to the difference in the types of bacteria in the surface soil. The milk from animals on low land is more likely to show undesirable fermentations than that from those grazing on higher lands. This is not due to the influence of the feed as is often supposed but rather to the dirt from the coat of the animal.
Washing the udder. If a surface is moist, dust and the adherent bacteria cannot be easily dislodged. The air over snow-covered mountains or over oceans is relatively free from bacteria. The udder and flanks of the[Pg 48] animals can be carded to remove the loose hairs and the evident dirt; the fine dust can now be removed by wiping with a clean damp cloth just before the milking process. The actual washing and wiping of the udder and flanks still further reduces the contamination coming from the animal; experiments show a reduction of fully three-fourths of total contamination. Clipping the udder and flanks also aids in keeping the animal clean.
It is often asserted that the treatment of the animals in these ways reduces the yield of milk. It is certain that such an effect will persist for only a short time and there is reason to believe that grooming increases the yield.
 Fig. 12.—Sanitary Milk Pails.
Fig. 12.—Sanitary Milk Pails.Sanitary milk pails. The entrance of organisms into the milk can be greatly reduced by lessening the area of the milk pail exposed to the dust shower. To accomplish this purpose a number of so-called sanitary or hygienic milk pails have been devised. In some cases, these are the regular type of pail provided with a cover having a[Pg 49] small opening through which the milk is received. In other cases, a strainer is interposed so as to remove more effectually the coarse particles. While pails of this type are successful in the removal of a large part of the dirt, and consequently reduce materially the bacterial content of the milk, yet they must be of simple construction, so that they can be kept in a clean condition in order to adapt them for general practical use. The use of such a utensil increases materially the keeping quality of the milk.
 Fig. 13.—Sanitary Milk Pails.
Fig. 13.—Sanitary Milk Pails.Stocking has shown that under ordinary barn conditions, the use of small-topped pails reduced the number of bacteria 95 per cent; with dirty cows the reduction in bacteria amounted to 97 per cent. A six-inch opening presents only one-fourth as large an exposure as a twelve inch, so that the reduction in bacterial content is greater than the lessening in the size of the openings of the pails. The ordinary pail receives dust not only from the udder, but also from the flank which is usually a more important[Pg 50] source of contamination than the udder itself, while the small-topped pail receives only that from the udder.
 Fig. 14.—use of Sanitary Milk Pails.
Fig. 14.—use of Sanitary Milk Pails.Milking machines. Where the milk is removed from the udder by machine methods, instead of by hand, it is possible to eliminate nearly all external contamination from the animal and her surroundings. The only opportunity for infection is then through the leakage of air around the teat cups. Care should be taken to see that the teats are in a clean condition before applying the suction cups. The main problem in the use of a milking machine is to keep the apparatus in an aseptic condition. Immersion of the teat cups and the rubber connections in lime water, brine solution, or other mild antiseptics, prevents bacterial development. Hastings has found that milk having a germ content of less than 10,000 bacteria[Pg 51] per cubic centimeter may be produced by the use of a properly handled milking machine.
Contamination from the milker. While the milker is a small factor in comparison with the animal in the matter of contamination, yet he can not be neglected, as it is within his power to affect profoundly the quality of the milk. His personal habits as to cleanliness and his appreciation of the precautions necessary in the production of clean milk have much to do with the contamination of the milk. The milking should be done with dry hands, although a little vaseline may be used with effect. The hands should be washed before milking as milk is certain to come in contact with them to some extent. The milking should be done with the whole hand rather than stripping between the thumb and finger; the clothing should be covered with clean overalls and jumper, or at least a clean apron should be worn during the milking. If these are of white material, more frequent laundering is likely to result.
Contamination from air. It is difficult to disassociate the contamination arising from the condition of the air from that derived directly from the animal. Barn operations of various kinds result in the production of dust, particularly where dry forage, such as hay or straw, is handled. Where manure is given an opportunity to dry, dust is readily produced, and such material is particularly replete with bacterial life. Some kinds of dust, such as that originating from ground grains, or shavings that may be used for bedding, contain a small amount of bacterial life in comparison with the dust from hay, or other dry fodder. In a dried condition, the slightest movement is apt to dislodge these fine particles, and they float in the air for considerable periods of time. If milk[Pg 52] is drawn and exposed to the air of the barn during the feeding operations, it is subject to the dust shower that is present. Where the storage can is allowed to stand in the stable during the milking, even though it is covered with a strainer, this accumulation of microscopic particles is added to the milk, as they readily pass the meshes of the finest strainer.
Fig. 15.—contamination From the Air.
Fig. 15.—contamination From the Air.Removal of dirt after introduction. The more primitive method of improving the quality of milk, so far as its dirt content is concerned, is to attempt to remove the[Pg 53] grosser particles of contamination after entrance. In the case of straining, the method is usually applied at the time of milking, but in the case of filtering and clarifying, it is carried out at the milk station, in an effort to improve the appearance of milk and overcome the influence of careless methods of the producer. By the use of strainers, either metallic or cloth, it is possible to remove particles of hair, undissolved dirt and manure, but it must be remembered that these grosser visible particles of pollution are not really the cause of the troubles which may ensue in improperly handled milk. The bacteria which are adherent to these foreign particles are in large measure washed off in the process of straining, and pass through the meshes of the finest strainer. The main service, therefore, of straining is to improve the appearance of the milk, and it has no effect on the quality in any way.
Production of clean milk. The problem of clean milk is important, whatever may be the use to which milk may be put. It is important in the manufacture of butter, but owing to the fact that the fat is not readily acted upon by bacteria, it is not so sensitive to bacterial conditions, as when the milk is made into cheese. In this product, the bacterial condition of the milk is a matter of prime importance. In milk destined for direct consumption, the exclusion of the bacteria becomes yet more important. While it is impossible to exclude bacteria so completely that milk will not undergo fermentative changes, yet for domestic consumption it is preferable to have milk with as low bacterial content as can readily be secured. The highest type of market milk, that known as sanitary, or certified, is produced under such extreme conditions of care as to contain the minimum germ[Pg 54] content. To accomplish these results requires such stringent control as to increase greatly the cost of the product. Pure, clean milk can be produced at a very slight increase in cost over the regular expense of milk production, if the right kind of attention is given to certain details of a practical character. Improvement in our milk supplies must largely come from this source, for any improvement to be permanent must be made to pay, and it requires considerable education to secure the co-operation of consumers and their willingness to pay for any material increase in the quality of the product.
In the foregoing factors concerned in the contamination of milk, it is of course impossible to measure accurately the influence of the different sources of infection, as these are continually subject to variation in every case. As a rule, the most important factors are those pertaining to the utensils and the condition of the animal herself. If these two factors are brought under reasonable control, the major portion of contamination that ordinarily obtains is done away with. The application of the remedial or preventive measures heretofore mentioned will greatly reduce the germ content of the milk.
Cooling of milk on farm. Bacterial growth is directly related to temperature conditions, and with summer temperatures, such development goes on apace, unless it is checked by early cooling. The larger portion of bacteria that find their way into milk, especially those that are previously in contact with the air, are in a dormant condition, and are therefore not stimulated into immediate growth, unless reasonably high temperatures prevail. In milk, which comes from the animal at blood heat, this growth is greatly stimulated. To counteract this effect, milk should be chilled as soon after milking as possible.[Pg 55] If the temperature is immediately lowered to 50° F., or lower, actual cell development is greatly retarded, and the rate of souring, and other fermentative changes thereby diminished. In this country ice is liberally used in accomplishing this result. In Europe, the use of ice is much less common. The employment of such artificial means of refrigeration makes possible the shipment of milk for long distances by rail. New York city now receives milk that is produced in Canada and northeastern Ohio.
 Fig. 16.—Effect of Cooling Milk.
Fig. 16.—Effect of Cooling Milk.
Aeration of milk. The custom has been extensively recommended of subjecting milk to the influence of air in the belief that such exposure permits of the interchange of gases that would improve the quality. In practice, this process, known as aeration, is carried on in different ways. In some cases, air is forced into the milk; in others, the milk is allowed to distribute itself in a thin sheet over a broad surface, falling in drops or tiny streams through the air. Whenever this process is carried[Pg 56] on at a temperature lower than that of the milk, it results in more or less rapid cooling.
In earlier times, aeration was generally recommended and practiced, especially in connection with the cheese industry, but carefully controlled experiments fail to show that the process exerts any material influence on the rate of germ development. If it is carried out in an atmosphere more or less charged with bacteria, as in the barn or stable, it is more than likely to add to the bacterial content of the milk. While to some extent odors may be eliminated by the process, the custom is not followed so generally now as it used to be some years ago.
Absorption of taints. A tainted condition in milk may result from the development of bacteria, acting upon various constituents of the milk, and transforming these in such a way, as to produce by-products that impair the flavor or appearance of the liquid; or it may be produced by the milk being brought in contact with any odoriferous or aromatic substance, under conditions that permit of the direct absorption of such odors.
This latter class of taints is entirely independent of bacterial action, and is largely attributable to the physical property which milk possesses of absorbing volatile odors. This direct absorption may occur before the milk is withdrawn from the animal, or afterwards if exposed to strong odors.
It is not uncommon for the milk of animals advanced in lactation to have a more or less strongly marked odor and taste; sometimes it is apt to be bitter, at other times salty to the taste. It is a defect that is peculiar to individual animals, and is liable to recur at approximately the same period in lactation. The peculiar[Pg 57] "cowy" or "animal odor" of fresh milk is an inherent peculiarity that is due to the direct absorption of volatile elements from the animal herself.
Many kinds of feed consumed by the animal produce a more or less pronounced taint or flavor in the milk. With some plants, such as garlic, leeks, turnips, and cabbage, the odor is so pronounced as to render the milk quite unfit for use. In some states along the Atlantic seaboard, wild plants of this character in woodland pastures may be so abundant as to make it impossible to pasture milch animals. The difficulty in such cases is due to absorption of the volatile principles into the circulation of the animal, and if such feed is consumed shortly before milking, the characteristic odors appear in the milk. If consumed immediately after the milk is withdrawn from the animal, sufficient time may elapse so that the peculiar odors are dissipated before the milk is again secreted. The same principle applies in a lesser degree to the use of certain green fodders that are more suitable for feed, such as rape, green rye, or even silage. Silage produces a distinct, but not unpleasant odor in milk, but newly pastured rye often confers so strong an odor as to render the milk unusable.
Where certain drugs are employed in the treatment of animals, such as belladonna, castor oil, sulfur, or turpentine, the peculiar odors may reappear in the milk. Such mineral poisons as arsenic have been known to persist for a period of three weeks before elimination.
On account of the elimination of many drugs, unchanged, from the animal in the milk, the milk of any animal that is receiving medicine should not be used for human food. When such milk is mixed with that of a number of other animals and when it is used by adults,[Pg 58] no harm is likely to result, but when the dilution is not great and the milk is used for young children it may affect them through its content of the drug. The feed may not only affect the quality of milk but its value as food. One of the most prominent of American dairymen, who has for many years produced milk especially for children's use, has said that he could feed his cows so as to make ill every child receiving the milk.
Absorption of odors after milking. If milk is brought in contact with strong odors after being drawn from the animal, it will absorb them readily, as in the barn, where frequently it is exposed to the odor of manure and other fermenting organic matter.
It has long been a popular belief that milk evolves odors and cannot absorb them so long as it is warmer than the surrounding air, but from experiments of one of us (R), it has been definitely shown that the direct absorption of odors takes place much more rapidly when the milk is warm than when cold, although under either condition, it absorbs volatile substances quite rapidly.
The custom of straining the milk in the barn has long been deprecated as inconsistent with proper dairy practice, and in the light of the above experiments, an additional reason is evident why this should not be done.
Even after milk is thoroughly cooled, it may absorb odors, as is noted where the same is stored in a refrigerator with certain fruits, meats, fish, etc.
Distinguishing bacterial from other taints. In perfectly fresh milk it is relatively easy to distinguish between taints caused by the growth of bacteria and those attributable to direct absorption. If the taint is evident[Pg 59] at time of milking, it is in all probability due to character of feed consumed, or possibly to medicines. If, however, the intensity of the taint grows more pronounced as the milk becomes older, then it is probably due to living organisms which require a certain period of incubation before their by-products are most evident.
Moreover, if the difficulty is of bacterial origin, it can be frequently produced in another lot of milk (heated or sterilized is preferable) by inoculating the same with some of the original milk. Not all abnormal fermentations are able, though, to compete with the lactic acid bacteria, and hence outbreaks of this sort soon die out by the re-establishment of more normal conditions.
Factory contamination. As the time element is of importance in the production of troubles due to bacteria, it follows that infection of milk on the farm is fraught with more consequence than factory contamination, as the organisms introduced would have a longer period of development. Nevertheless, the conditions in the factory are by no means to be ignored, as they not infrequently permit the milk to become seeded with highly undesirable types. A much more rigid control can be exercised in the factory, where steam is at hand as an aid in the destruction of organisms. In the cleaning of pumps and pipes, steam is absolutely necessary to keep such apparatus in a sanitary condition.
The water supply of the factory is a matter of prime importance, as water is used so extensively in all factory operations. When taken from a shallow well, especially[Pg 60] if surface drainage from the factory is possible, the water may be contaminated to such an extent as to introduce undesirable bacteria in such numbers that the normal course of fermentation may be changed. The quality of the water, aside from flavor, can best be determined by making a curd test (p. 99) which is done by adding some of the water to boiled milk, and incubating the same. If "gassy" fermentations occur, it signifies an abnormal condition. In deep wells, pumped as thoroughly as is generally the case with factory wells, the germ content should be very low, ranging from a few score to a few hundred bacteria per cubic centimeter at most. The danger from ice is much less, for the reason that good daily practice does not sanction using ice directly in contact with milk or cream. Then, too, water is largely purified in the process of freezing, although if secured from a polluted source, reliance should not be placed in this method of purification, for even freezing does not destroy all vegetating bacteria.
The ordinary house fly is an important source of contamination in creameries, cheese factories and city milk plants. They are of importance not only in increasing the number of fermentative bacteria in milk but they may serve to contaminate it with disease-producing organisms. The windows of all places where milk is handled, whether on the farm or elsewhere should be screened.
It should be kept in mind in the handling of milk and other dairy products that human food is being prepared and that cleanliness is desirable from every point of[Pg 61] view, and that the methods of handling and production should compare with those used in the preparation of foods which like milk cannot be cleaned when once polluted. Desirability, keeping quality, healthfulness and the value of every product made from milk depends upon the extent and amount of contamination.
INFECTION OF MILK WITH PATHOGENIC BACTERIA.
That the disease-producing, or pathogenic bacteria, are able to infect milk supplies is shown by the fact that numerous epidemics of contagious disease have been directly traced to milk infection. Milk is generally consumed in a raw state, and as a considerable number of this class of organisms are able not only to live but actually grow in milk, which is such an ideal culture-medium for the development of most bacteria, it is not surprising that disease processes should be traced to this source. The organisms in milk capable of causing disease do not alter or change its physical properties sufficiently to enable their presence to be detected by a physical examination.
Origin of pathogenic bacteria in milk. Disease-producing bacteria may be grouped, with reference to their relation toward milk, into two classes, depending upon the manner in which infection occurs:
Class I. Disease-producing bacteria capable of being transmitted directly from a diseased animal to man through the medium of infected milk.
Class II. Bacteria pathogenic for man but not for cattle, which are capable of thriving in milk after it is drawn from the animal.
In the first group, the disease produced by the specific organism must be common to both cattle and man.[Pg 63] The organism must live a parasitic life in the animal, developing in the udder, and so infect the udder. It may, of course, happen that diseases toward which domestic animals alone are susceptible may be spread from one animal to another in this way without affecting human beings.
In the second group the bacterial species live a saprophytic existence, growing in milk, as in any other nutrient medium, if it happens to find its way therein. In such cases, milk indirectly serves as an agent in the dissemination of disease, by giving conditions favorable to the growth of the disease germ.
By far the most important of diseases that may be transmitted directly from animal to man through a milk supply is tuberculosis, but in addition to this, foot and mouth disease (aphthous fever in children), Malta fever, and acute enteric troubles have also been traced to a similar source of infection.
The most important specific diseases that are disseminated through subsequent infection of the milk are typhoid fever, diphtheria, scarlet fever, and cholera, but, of course, the possibility exists that any disease germ capable of living and thriving in milk may be spread in this way. In addition to these diseases that are caused by the introduction of specific organisms (the causal organism of scarlet fever has not yet been definitely determined), there are a large number of more or less illy defined troubles of an intestinal character that occur especially in infants and young children that are undoubtedly attributable to the activity of micro-organisms that gain access to milk during and subsequent to the milking, and which produce changes[Pg 64] in milk before or after its ingestion that result in the formation of toxic products.
Tuberculosis. This disease is by far the most important bacterial malady that affects man and beast. In man, it assumes a wide variety of phases, ranging from consumption, tuberculosis of the lungs, which is by far the most common type, to scrofulous glands in the neck, cold abscesses, hip-joint, and bone diseases, as well as affection of the bowels. These various manifestations are all produced by the inroads of the specific organism, Bacillus tuberculosis. The bovine, as well as swine, fowls, and other warm-blooded animals, are also affected with similar diseases. In man, the importance of the malady is recognized when it appears that fully one-seventh of the human race die of this scourge. In cattle, the disease is equally widespread, particularly in those countries where live stock has been intensively developed. In the northern countries of Europe, such as Denmark, Germany, England, France, and the Netherlands, as well as in Canada, and this country, this disease has been most widely disseminated. This has been occasioned, in large measure, because of the exceedingly insidious nature of the disease in cattle, thereby permitting interchange of such diseased stock without the disease being recognized. Tuberculosis is found more abundantly in this country in dairy than in beef stock. Dairy cattle are, however, not more susceptible, but the closer environment in which milch cattle are kept, and the fact that there has been greater activity in the matter of introducing improved strains, accounts for the larger percentage of affected animals.
It has been a disputed question for some years whether the organisms producing bovine and human tuberculosis are identical or from the practical standpoint, whether the bovine type of disease is transmitted under natural conditions to man. The bacteriologist can readily detect differences in appearance, in growth of cultures, and in disease-producing properties between the two strains. Of the two, the bovine is much the more virulent when inoculated into experimental animals. In a considerable number of cases, record of accidental infection from cattle to man has been observed. These have occurred in persons making postmortem examination on tuberculous animals, and the tubercular nature of the wound proven by excision and inoculation.
More recently, since the agitation by Robert Koch of Germany, a number of scientific commissions have studied particularly the problem of transmission. It is now estimated that perhaps seven per cent of the tuberculosis in man is of bovine origin. This is almost wholly confined to children. The portions of the body that become diseased, when the infection has resulted from the use of milk, are the glands of the neck and of the abdomen.
Manner of infection in man. In the main, the source of the malady may be traced either to air infection or to the food, if one disregards the comparatively small number of cases of wound infection. Air is frequently a medium by which the germ is transferred from one person to another. The sputum is exceedingly rich in tubercle bacilli and since this material is carelessly distributed by tubercular people, the air of the cities,[Pg 66] villages and public buildings will frequently contain tubercle organisms. Some of the organisms in the air find their way into the lungs, there to develop and produce consumption. The organisms in the air may be deposited in the nasal passages and throat, and ultimately find their way into the tissues of the body by penetrating the walls of the throat or of the intestine. It is probable that the tubercle bacilli thus introduced may find their way to the lungs and there develop without leaving any trace of their path.
Food may also possibly serve as a medium of infection. The contamination of solid food from flies and other sources is, of course, a possibility, but tuberculous meat from cattle and swine is much more likely to occur, although it must be said that the processes of preparing such food for use (roasting, frying, and boiling) are sufficient to destroy the vitality of the causal organism. The fact that most food products of this character are now inspected renders this possibility less likely to occur.
Unquestionably, the likelihood of ingesting tubercle organisms is much greater with milk than with any other food supply, as milk is consumed usually in an uncooked state, and as microscopic and physiologic tests indicate that not infrequently milk from tuberculous animals contains these organisms.
Distribution of the disease in animals. As practically any organ of the body may be affected with tuberculosis, it naturally follows that the lesions of this disease are widely distributed. The disease germ is introduced, in the main, through the lymph and not the blood system; consequently, in the initial stages the evidence of tuberculosis is often comparatively slight,[Pg 67] and the lesion is restricted in its development. Where such a condition obtains, it is known as "closed," in contradistinction to "open" tuberculosis, where the diseased tissue is more or less broken down and is discharging into the circulation, or elsewhere. Manifestly, the danger of spreading not only in the affected animal itself, but to the outside, is much greater in the case of the open lesion. Especially is this true where the disease is present in the lungs or organs that have an exterior opening so that the material containing the organisms is discharged from the body in the sputum, manure, urine or milk. The intestines themselves are rarely affected, but the lymph glands associated with the intestinal tract are not infrequently involved.
Infection of milk with tubercle bacilli. In a small percentage of cases, the udder itself becomes involved. Where this condition obtains, one or more hard lumps are formed, which slowly increase in size, usually being restricted to one quarter of the udder. Sometimes the affected quarter may develop to an enormous size, producing a hard, painless tumor. Not often does the affected tissue break down into pus; consequently, no abnormal appearance is to be noted in the milk secretion until the disease has made very extended progress, in which case the percentage of fat generally diminishes. Whenever the udder shows physical manifestation of this disease, the milk almost invariably is rich in tubercle bacilli.
Tubercle organisms may also appear in milk of animals in which no physical symptoms of the disease are to be found. This fact has been demonstrated by microscopic[Pg 68] and animal experiments, but it is also abundantly confirmed by the frequent contraction of the disease by calves and hogs when fed on factory by-products. This latter class of animals is particularly dangerous, because there is no way in which the danger can be recognized.
 Fig. 17.—a Tuberculous Animal.
Fig. 17.—a Tuberculous Animal.It has also been proven that milk may become infected through the feces. In coughing up material from the lungs and associated glands, the matter is swallowed, instead of expectorated, as in man. The organisms retain their vitality in the intestine, and are voided in the feces. Under ordinary conditions, the flanks and udder become more or less polluted with such filth, and the evidence is conclusive that infection of milk is not infrequently occasioned in this way. The fact that[Pg 69] hogs following tuberculous steers in the feeding lots are very likely to acquire the disease is explained by the presence of tubercle organisms in the manure of such animals.
 Fig. 18.—a Tuberculous Animal.
Fig. 18.—a Tuberculous Animal.It must be kept in mind that many animals may be infected with tubercle bacilli and therefore have tuberculosis in the incipient stages, without their being able to disseminate the disease to others. In the early stages, they are bacillus-carriers without being necessarily dangerous at that particular time, but the possibility always exists, as the disease develops in the system, that the trouble may assume a more formidable character, and that slowly developing chronic lesions may become acute, and "open," in which case, the affected[Pg 70] animal becomes a positive menace to the herd. As the time when the lesions change from the "closed" to the "open" type and the animal becomes a source of danger cannot be determined, the only safe way to do is to exclude the milk of all tuberculous animals from the general supply, whether for direct consumption, or for manufacture into dairy products and to look upon every diseased animal as a menace to the herd. This is rendered all the more necessary when the milk is used for the feeding of children, who are relatively more susceptible to intestinal infection than the adult. The early stages of the disease in cattle are, however, so insidious that no reliance can be placed upon the detection of the malady by physical means. Fortunately, in the tuberculin test, a method is at hand, which in a simple, but effective manner, enables the disease to be distinguished in even the early stages, long before recognition is possible in any other way.
Tubercle bacilli in dairy products. When infected milk is used for the preparation of butter and cheese, the organisms inevitably are incorporated in them. In the separation of milk a relatively large part of the tubercle organisms in the milk appear in the cream. In the making of cheese even more of the organisms are held in the curd. In butter and cheese, as in milk, no growth of the organism can take place; however, the vitality of the organism is retained for a considerable number of months. It is not believed that these products are of much importance in the spread of tuberculosis in the human family, since they are not consumed by children to any extent. Cream is to be considered as a means of distribution since it is often used by children.
Treatment of tuberculous milk. It is easily possible to treat milk or factory by-products so as to render them positively safe. The process of pasteurization or sterilization is applicable to whole milk, and when effectively done destroys entirely the vitality of any tubercle bacilli. In making such exposure, care should be taken to prevent the formation of the "scalded layer," as the resistance of the organism toward heat is greatly increased under these conditions. In a closed receptacle, 140° F. for 15 to 20 minutes has been found thoroughly effective in destroying this organism. A momentary exposure at 176° F. is likewise sufficient. This is the method that is almost universally used in Denmark in the manufacture of the finest butter.
In the treatment of factory by-products, heat should also be employed. In Denmark, compulsory pasteurization at not less than 176° F. is required. This treatment prevents not only the dissemination of tuberculosis among hogs and young cattle, but is equally efficacious in preventing the spread of foot and mouth disease.
The per cent of tuberculous milch cows varies widely in different sections of the country, being greatest in the older dairy sections, and in those supplying milk to the cities, on account of the constant buying and selling of animals, thus giving more frequent opportunity of introducing the disease into the herds. Throughout the country at large, probably less than ten per cent of the cows are tuberculous, and it is estimated that at least one per cent of the diseased animals have tuberculous udders. It has been suggested that the dilution of the milk of such animals with that of healthy cows would remove a great part of the danger from milk.[Pg 72] In the case where the milk of a large number of herds is mixed, this may be of some importance, but in no case is it safe to assume that dilution of the milk of tuberculous cows is any guarantee of safety.
It has been shown that milk, perfectly normal in appearance, coming from a tuberculous udder could be diluted a million times and still produce the disease on inoculation into experimental animals. In the case of swine, the susceptibility is so great that a single feeding of infected milk, even in a very dilute condition, causes with certainty the production of the disease.
Some observers maintain that the contamination of the milk with the manure of tuberculous animals is of greater hygienic importance, than that coming from diseased udders, since the number of animals having tuberculosis of the lungs and intestines is far greater than those with diseased udders.
Economic aspects of bovine tuberculosis. Not only is this disease invested with much importance because of its inter-relation with the human, but from an economic point of view alone, it is undoubtedly the greatest scourge that affects the dairyman. Its insidiousness makes it exceedingly difficult to recognize. The consequence is that many fine herds become seriously involved before its presence is recognized. In the main, the disease is introduced into a herd by purchase, often by buying in pure-bred stock to improve the quality of the herd. Where the disease has been established in a region for some time, there is also danger that unheated factory by-products, as skim milk and whey, may function in its spread. Where such conditions prevail, the spread of the disease in the creamery district is exceedingly rapid. When once introduced into a herd,[Pg 73] the disease sooner or later spreads from the originally affected animal to others in the herd. Close contact, and close confinement in ill ventilated stables facilitate the spread of the disease, and sooner or later, other animals acquire the trouble. This may all occur while all animals appear in a healthy condition.
The symptoms of the disease in the earlier stages are quite indefinite. As the disease progresses, the nutritive functions appear to be disturbed, and sooner or later, the body weight begins to decline, and finally marked emaciation ensues. Accompanying this condition, especially when the disease is in the lungs, is a cough, which is generally aggravated with active exercise. While the run-down condition permits frequently of the detection of the disease in the advanced stages, it is wholly impossible with any accuracy to diagnose the trouble in the incipient stages. It is at this stage that the tuberculin test comes to the aid of the stockman.
Tuberculin test. This test is made by the injecting beneath the skin of the animal a small quantity (about 2 c. c.) of tuberculin, and noting the temperature of the animal, before and after the injection. Tuberculin, a product of the growth of the tubercle bacillus, when injected into the body causes a marked rise in temperature, in the case of an animal affected with the disease, and no such elevation in the case of a healthy animal. The process of preparing tuberculin makes it absolutely free from danger, so far as liability of producing the disease, or in any way injuring the animal, is concerned. Fig. 19 shows the temperature range of both reacting and non-reacting animals. While the[Pg 74] test is not absolutely infallible, it is so far superior to any and all other methods of diagnosis that it should take precedence over them.
Miscellaneous diseases. There are a number of diseases that affect both human beings and cattle, the causal organisms of which may be transmitted through the milk. Foot and mouth disease is one wide spread in European countries but which has not yet gained a permanent foothold in this country. The ingestion of the milk, which always contains the causal organism, produces the disease in both humans and cattle. In the human the disease is very similar to that in cattle; it may end in death. Vesicles are produced in the mouth, on the lips, nose and fingers. The causal organism, which has not yet been demonstrated, may occur in butter or cheese. It is easily destroyed by pasteurizing the milk.
 Fig. 19.—Temperature Curves.
Fig. 19.—Temperature Curves.Anthrax, actinomycosis (lumpy jaw), rabies, and malta fever are diseases the organisms of which have been found in the milk of affected animals. In case of the first three, while the possibility exists of the infection of human beings by milk, it is improbable that such infection does normally occur. Malta fever is becoming an important disease in portions of southern Europe. It is produced in man by the use of milk of goats suffering from the disease.
The organism causing contagious abortion in cattle is known to be present in the milk of the infected animal at the time of its withdrawal from the udder. It is not probable that the organism is of any sanitary significance as far as man is concerned. It has been shown that the organism is able to produce a disease in guinea pigs on artificial inoculation that is very similar, so far as the lesions are concerned, to tuberculosis. It is also probable that the by-products of creameries and cheese factories may serve to spread the disease from one herd to another.
Inflammation of the udder (garget) is a frequent trouble in every herd. It is marked by the swelling of one or more quarters, by the appearance of fever and changes in the appearance and composition of the milk. The inflammation may be caused by cold or injury, or by the invasion of the udder with pus-forming bacteria. In the first case the trouble is not likely to persist for any length of time, and does not spread to other members of the herd. The milk may be more or less stringy, and may show a slimy flocculent sediment. It cannot be asserted that such milk is harmful to man but it should be rejected on general sanitary grounds, and because it cannot always be differentiated from that coming[Pg 76] from an udder in which the inflammation is produced by bacteria.
Inflammation caused by the invasion of the udder with specific bacteria is usually of greater severity, the entire gland often becoming involved. The secretion of milk may cease and the function of the diseased quarters may never be restored. The milk in the less severe cases may not be abnormal in appearance, but with increasing severity, the nature of the milk changes, until it may be a watery liquid. The milk of any animal suffering from any form of garget should be rejected, as it may cause trouble, especially in children. There is some reason to believe that organisms coming from cases of garget have been responsible for the extensive outbreaks of septic sore throat that have occurred in some parts of the country.
The milk of animals suffering from indigestion, diarrhea, abscesses on any part of the body, as from those which have retained the afterbirth should be likewise rejected. In short only the milk of healthy animals should be used for human food; that from any animal suffering from any disease or which is receiving medical treatment should not be so used.
Typhoid fever. The most important disease germ, distributed through the medium of milk, that is unable to produce a diseased condition in the cow is the organism of typhoid fever. This malady is an intestinal affliction of man, and the germ causing the same is found abundantly in the dejecta, both solid and liquid, as well as in the blood in certain stages of the disease. While the causal organism does not leave the body through the expired air, it is found abundantly in both the urine and feces. Therefore, the dejecta, and any[Pg 77] articles that may be soiled with the same become a positive menace.
Many different methods of transmitting the contagion exist, such as water, food infected in various ways, contact with infected persons, and through the medium of milk. Milk is not so frequently the cause of dissemination as the other factors, but where milk supplies become contaminated, epidemics of considerable magnitude are wont to occur. The danger from milk is also aggravated by the fact that the typhoid bacillus is capable of withstanding considerable amounts of acid, and consequently finds, even in raw milk containing the normal lactic acid bacteria, conditions favorable for its growth. In a considerable percentage of cases, the disease is not sufficiently severe to cause the patient to take to his bed. These so-called "walking typhoid" cases are particularly dangerous, because they serve to spread the disease organism more widely.
A very considerable proportion of the people that recover from typhoid fever still continue to harbor the typhoid bacillus in their urinary and gall bladders. This condition may obtain for years, and since such individuals are in perfect health and are ignorant of their own condition, and since they give off the organisms more or less constantly, they are often the cause of extensive milk borne epidemics. Such persons are known as "typhoid carriers" and constitute one of the gravest problems the public official has to contend with in his struggle to prevent the spread of typhoid fever.
Where outbreaks are caused by milk, they can readily be traced by means of the milk route, as there are always a sufficient number of susceptible persons, so[Pg 78] that outbreaks of epidemic proportions develop. In the Stamford, Conn., outbreak in 1895, 386 cases developed on one milk route. In this case it was shown that the carrying cans were thoroughly washed, but were later rinsed out with cold water from a polluted shallow well.
The mode of infection of milk varies, but in general, the original pollution is occasioned by the use of infected water in washing the utensils, or a case of "walking typhoid" or bacillus carrier, who directly infects the milk. In case of sickness in rural families, some member of the household may serve in the dual capacity of nurse and milkmaid, thus establishing the necessary connection. Busey and Kober report twenty-one outbreaks, in which dairy employees also acted in the capacity of nurses. The fact that the urine of a convalescent may retain the typhoid germ in large numbers for some weeks renders the danger from this source in reality greater than from feces, as, naturally, much less care is exercised in the disposition of the urine.
The house fly is now regarded as one of the important means of spreading typhoid fever, indeed it is often called the "typhoid fly." The infectious material deposited in an open vault may serve as a source from which the fly carries the organisms to milk and other foods in the house or elsewhere. The protection of vaults and the screening of every place where human food is handled or prepared is the only protection.
It should be emphasized that in the case of the tubercle organism, no growth ever occurs in milk, but with the typhoid bacillus growth is possible. It thus needs but the contamination of the milk with the smallest[Pg 79] particle of material containing them to seed the milk. By the time it is consumed it may contain myriads of the disease-producing organisms.
Diphtheria. This is a highly infectious disease, affecting children primarily and is characterized by the formation of membranous exudates in the throat and air passages, which are teeming with the causal organism, the diphtheria bacillus. This organism is capable of forming highly toxic products, and it is to the effect of these poisons that its fatal result is generally due. The organism is thrown out from the body, in the main, through the mouth, the surroundings of the patient being infected directly from the air, and indirectly, by contact with polluted hands, lips, etc. Thus, the germ deposited from the lips of a case of the disease, on the common drinking cup, slate, lead pencils, toys, and the like, may easily pass from child to child. Not infrequently, the causal organism persists in the throat long after all evidence of membranous growth has subsided, and so the child itself may act as a "bacillus carrier."
Not so many epidemics of diphtheria as of typhoid have been traced to milk, but the evidence is sufficient to indict milk as a disseminator of contagion. In several cases, the diphtheria germ has actually been isolated from infected milk supplies. Actual growth of the diphtheria germ is said to take place in raw milk more rapidly than in sterilized.
Scarlet fever. While the germ of scarlet fever has not yet been isolated, and therefore its life history in relation to milk cannot be depicted so accurately, yet milk-borne epidemics of this disease are sufficiently abundant to leave no doubt but that this food medium[Pg 80] may sometimes serve as a means of disseminating such troubles. Infection of the milk doubtless comes in the case of this disease from direct contact with a person suffering from the malady.
Cholera. While this disease is of no practical importance in America, owing to its relative infrequency, yet outbreaks of cholera have been traced to milk, in spite of the fact that the causal organism is more sensitive to the action of acids than most disease-producing bacteria. In several outbreaks in India, milk has been the medium through which the disease was spread. Generally, infection of the milk has been traced to the use of polluted water.
Children's diseases. An exceedingly high mortality exists among infants and young children in the more congested centers, especially during the summer months. In the main, the cause of these troubles is due to intestinal disturbances, and unquestionably, the character of the food enters largely into the problem. As milk constitutes such a large proportion of the diet of the young, and is so susceptible to bacterial invasion, it would appear probable that much of the trouble of this character is due to the condition of this food supply. This is rendered more probable when it is remembered that bottle-fed infants suffer a much higher mortality than breast-fed children, due probably to the fact that the lengthened period between the time the milk is drawn and consumed permits of abundant bacterial growth. Much carelessness also prevails among the poor in cities, relative to the care of utensils used in feeding children. Nursing bottles often serve to infect the milk. Where milk is pasteurized, or properly[Pg 81] heated, it has been found that the mortality rate has been greatly reduced, thus indicating that the condition of the milk was directly responsible for the death rate. In fact, the mortality from these indefinite intestinal troubles probably exceeds that from all of the specific infectious diseases combined. Improved care in handling this sensitive food supply will do much to better conditions in this direction.
Ptomaine poisoning. Acute poisoning affecting adults as well as children, not infrequently occurs from the use of foods of various kinds. Cases of poisoning arising from the use of shell fish, canned meats, ice cream, cheese, and other dairy products, are from time to time reported. These troubles are due to the production of toxic compounds, in the main, probably caused by bacterial decompositions. Often such troubles may affect a number of persons, as at banquets and such gatherings, thereby giving the semblance of an epidemic. While such troubles are doubtless to be ascribed to bacterial activity, they are not transmissible from person to person.
In the case of troubles arising from ice cream and such confections, the probable cause is due to the storage of milk or cream under refrigerator conditions, where germ growth can go on in the product, and yet the temperature be sufficiently low to prevent the usual acid fermentations.
FERMENTATIONS OF MILK.
Milk, under normal conditions, is always contaminated with bacteria coming from the most varied sources. If it is produced under clean conditions, the number of bacteria will be small, but in any case, the number of kinds of bacteria that find their way into milk will be large. Many of them find in milk at ordinary temperatures suitable conditions for growth; they use a portion of some of the constituents of the milk as food, producing certain other compounds that are known as "by-products." These by-products impart to milk a taste and odor that is not found in fresh milk. The effect of the action of bacteria may also be made evident by the change in the appearance of the milk. When these various changes become evident to the senses, either by taste, smell or sight, the milk usually is so modified as to be unfit for many ordinary purposes. The preservation of milk, a subject to be treated later, is a study of the ways of preventing or retarding the growth of bacteria in milk, and thus delaying the time when evidences of their action first become apparent.
Each class of bacteria produces more or less specific changes in the milk as a result of their growth. Certain bacteria are of the greatest benefit to the butter and cheese maker, while others are distinctly harmful to the manufacturer of dairy products. The changes produced by the different bacteria are called "fermentations"[Pg 83] of milk, each being most commonly named from the most important by-product formed.
Acid fermentation of milk. Fresh milk has a sweet taste and little or no odor, but if it is allowed to stand at ordinary temperatures, it sours; the taste is no longer sweet because the sweetness of the sugar of the milk is masked by the acid produced from the decomposition of a portion of the sugar by the bacteria. The change in odor and taste of milk is apparent long before the appearance is altered and increases in intensity as the acid-fermentation progresses. The first alteration in appearance is most usually one of consistency; the liquid milk is transformed into a semi-solid mass. The terms "curdling" and "sour" are usually synonymous. Milk is, however, often said to be sour as soon as the acid fermentation has progressed to a point where it is evident to taste or smell. This process of souring, or the acid fermentation is so common a change that raw milk which does not show this type of fermentation is looked upon with suspicion, and, usually, justly so. The process in the past was thought to be something inherent in the milk, a natural and inevitable change. It is now known that this is not so, but that it is due to certain kinds of bacteria, and that if these are prevented from getting into milk, it will not sour, but will undergo some other less desirable type of decomposition.
The acid-forming bacteria comprise but a very small part of the total number of organisms that find their way into the milk during its production on the farm, yet in sour milk scarcely any other kinds of bacteria can be found. At ordinary air temperatures, the acid-forming bacteria grow more rapidly in milk than do[Pg 84] any other forms, and the acid produced by them renders the milk an unfavorable medium for the growth of other bacteria. This is the reason why milk practically always undergoes the acid fermentation, although it is contaminated with a host of other kinds of bacteria. If a mixture of seeds is sown on low wet ground, certain kinds will grow best; if the same mixture is sown on drier land, other types will find most favorable conditions for growth, and the plants which appeared on the low land will not appear. The same condition is found in milk where the environment is most favorable for the acid-forming bacteria.
Amount of acid formed in milk. In this country the acidity of milk is expressed as so many per cent of lactic acid. A milk that shows an acidity of one per cent should, theoretically, contain one pound of lactic acid in each one hundred pounds of milk. The acid determined does not actually represent lactic acid, as there are other substances in milk which act as acids, with the reagents used in the present methods of determining the acidity of milk. For instance, perfectly fresh milk has an apparent acidity of 0.13 to 0.18 per cent, although no fermentation has occurred. Other acids than lactic are formed in the acid fermentation, but the entire acid content is referred to as lactic when speaking of the acidity of milk. When the developing acidity of milk reaches 0.25 to 0.3 per cent, a sour taste becomes evident and the milk will curdle on heating. When the acidity increases to 0.6 to 0.7 per cent, the milk curdles at ordinary temperatures. The acidity continues, however, to increase until it reaches about 1 per cent, which is the maximum amount that will be[Pg 85] produced in milk by the ordinary acid-forming bacteria. Milk contains about 4 per cent of milk sugar, all of which is fermentable. If this were all decomposed by bacteria, the acidity of the milk would actually exceed 4 per cent. It is thus evident that the reason why more acid is not formed in milk is not because of any lack of sugar. The bacteria, like all other kinds of living things, are injured by their own by-products, unless these are constantly removed in some way; in milk the bacteria cannot escape the action of the acid which they themselves have formed, consequently growth ceases. The amount of acid formed is dependent on the kind of bacteria present and on the composition of the milk. Certain bacteria will not produce enough acid to cause the curdling of the milk; still others will form 2 or even 3 per cent. These types, however, do not play any important part in the spontaneous souring of milk.
In milk the acid first formed combines with the ash constituents and the casein to form salts which do not seriously affect the growth of the bacteria. Ultimately, the limit of the ash and casein to take up acid is reached, and free lactic acid which is harmful to bacterial growth appears. If the content of casein and ash constituents is high, a higher degree of acidity will be reached than in a milk with a lower content. If a large part of the volume of the milk is made up of a compound that has no role whatever in the acid fermentation, such as the butter fat in cream, the amount of acid formed per unit volume of milk will be reduced, since in determining the acidity, a definite volume of milk is taken, and the acidity is expressed, as such a per cent of this amount.
Types of acid-forming bacteria. When substances undergo decomposition, it is a common belief that compounds offensive to the odor and taste are formed; but such is not necessarily the case. The products of the decomposition may be as agreeable and as harmless as the compounds decomposed. Whether the decomposition products of any substance are offensive or not is dependent on the kinds of micro-organisms acting on it. There are forms of acid-producing bacteria that change milk in odor, taste, and appearance, yet the sour milk is not offensive in any sense of the word. Other bacteria also sour the milk, but produce offensive odors and a disagreeable taste. Thus, the acid-forming bacteria may be divided into two main groups, which may be designated as desirable and undesirable. This division is of importance to the butter and cheese maker and to the consumer of milk.
Desirable acid-forming bacteria. If milk is produced under clean conditions, it is not likely to have a disagreeable odor or taste at any time, even when it is sour; rather the taste is agreeable like that of good butter milk. The curd is perfectly homogeneous, showing no holes or rents, due to the development of gas, and there is but little tendency for the whey to be expressed from the curd. This type of fermentation is largely produced by the group of bacteria to which has been given the name, Bacillus lactis acidi.
The main by-product of this group of bacteria is lactic acid; small amounts of acetic acid and alcohol, with traces of other compounds, are also formed. The agreeable odor and to some extent the flavor of milk fermented by these bacteria is due to other by-products than lactic acid, for this has no odor and only a sour[Pg 87] taste. The acid fermentation of milk is often called the lactic acid fermentation. In reality only the fermentation produced by the desirable group in which lactic acid is the most evident by-product should be thus called.
 Fig. 20.—Different Types of Curds.
Fig. 20.—Different Types of Curds.The bacteria of this group may enter the milk from the dust coming from the coat of the cow. They are[Pg 88] also found in the barn dust and on cultivated plants. Under ordinary farm conditions, the larger part of those found in milk come directly from the utensils. If the milk is drawn under extremely clean conditions and care is taken to sterilize the utensils, but few acid-forming bacteria of any kind will enter the milk; under such conditions most of the acid-forming bacteria will belong to the group in question. They find, however, such favorable conditions for growth in milk that they develop more rapidly than most other types with which milk becomes seeded; consequently under normal conditions, they gain the ascendency and so control the type of fermentation.
The desirable type of acid-forming bacteria do not form spores; hence, are easily killed by heating the milk. They can grow in the presence or in the absence of free oxygen. In the bottom of a can of milk or in the middle of a cheese, there is no air, yet these bacteria grow as well under these conditions, as in milk exposed to the air. The range of temperature for growth varies from 50° to 100° F. but development is most rapid at 90° to 95° F. and about 1 per cent of acid is formed.
Another group of bacteria which may be classed among the desirable acid-forming organisms is constantly found in milk. They have little to do with the ordinary acid fermentation as they grow very slowly at ordinary temperatures. If a sample of raw milk is placed at the temperature of the animal body, the acidity will reach 1 per cent in a few hours. Thereafter the acidity will increase slowly and may reach three per cent or above. The continued increase in acid is due to the growth of long rods of the Bacillus Bulgaricus[Pg 89] type, which apparently enter the milk with the fecal matter. The nature of the change produced by them in milk is very similar to that caused by Bact. lactis acidi in that lactic acid is the chief product; no gas is produced and hence the curd is uniform in appearance. Temperatures from 100° to 110° F. favor their development. Organisms belonging to this group are used in the preparation of the fermented milks now so widely sold in the cities.
These desirable, acid-forming bacteria are of the greatest service in every branch of the dairy industry, whether in butter or in cheese making, or in the sale of milk in the city. The dairy industry is dependent upon fermentative activity, as much as the manufacture of beer or wine, and the main basis of this is the acid fermentation of the milk by these desirable types of bacteria.
Although milk contains a large amount of nitrogenous substances (casein and albumen), it does not undergo putrid decomposition, as do meat and eggs, not because it is not fitted for the growth of the bacteria causing that type of change, but because the acid formed in it stops the growth of the putrefactive bacteria. If a sample of milk is placed in a stoppered bottle, it will have much the same taste and odor at the end of several months as at the end of a few days. The acid acts as a preservative, like the vinegar in pickles, or the acid in silage and in sauerkraut. Meat placed in a stoppered bottle which is then filled with milk will be preserved.
The products formed in the decomposition of meat and eggs are not only offensive but may also be injurious[Pg 90] to the health of the consumer. Milk that has been fermented by the desirable kinds of acid-forming bacteria is not harmful. It is consumed in a variety of forms (buttermilk, cottage cheese) as a common article of food and its use is rapidly increasing. The preparation of the pure culture buttermilks or artificially soured milks that are now so frequently recommended for digestive troubles rests upon an acid fermentation of this type.
Undesirable acid-forming bacteria. Other types of bacteria capable of forming substances that impart to milk an offensive odor and a disagreeable taste not infrequently appear instead of the desirable group. Instead of producing from the sugar of milk large quantities of lactic acid, these types generate other acids, such as acetic and formic, which impart a sharp taste to the milk. Besides the acids the bacteria of this group form gases from the sugar of the milk. Some produce small amounts of gas; others so much that the curd will be spongy and will float on the surface of the whey. The fermentation caused by them is often called a "gassy fermentation" and is dreaded by butter and cheese makers since the gas is indicative of bad flavors that will appear in the product. Gas may also be produced in other types of fermentations to be discussed later.
This class of bacteria enters the milk with the dust, dirt, and manure, in which materials they are especially abundant. No spores are formed; hence they are easily killed by heating the milk. They grow both in the presence and in the absence of free oxygen. High temperatures[Pg 91] favor their growth, most rapid development taking place at 100° to 103° F.
Spontaneous fermentation of milk. The normal souring of milk is due to a mixture of these two groups of bacteria. The relative proportions existing between the two in any sample of milk is dependent on a number of factors, most important of which is the degree of cleanliness exercised in the production of the milk. Where careless conditions obtain under which dust and manure particles find their way into milk, it becomes more abundantly seeded with gas-generating bacteria, and consequently, the type of fermentation is undesirable. If, however, the milk is drawn into clean utensils and care is taken to exclude dirt, the pure lactic acid types are able to control the character of the changes produced, and a clean, pleasant tasting liquid results. It will be seen that things are well arranged by nature; one of the most important food products undergoes a type of decomposition that is not offensive and when produced under clean conditions, the sour milk is as healthful a food as is the fresh product. Thus there is every reason for cleanliness in the production of milk, for cleanliness' sake and because clean milk means better products, and greater returns to everyone, producer and dealer.
There are other kinds of acid-forming bacteria in milk but they are of small importance compared with those just discussed. Some of the bacteria derived from the inside of the udder of the cow form acid, but these forms grow very slowly in milk at ordinary temperatures, and have no influence on the keeping quality.
 Fig. 21.—Different Types of Curds.
Fig. 21.—Different Types of Curds.Sweet curdling fermentation of milk. Samples of milk are sometimes found that are curdled, but which do not taste sour, or have the normal odor of sour milk. The curd is usually soft and the taste bitter. It is evident that the curdling cannot be due to the same factors as in the normal souring of milk. Such a change is similar to the action of rennet which is used to curdle the milk in cheese making. This ferment will curdle perfectly[Pg 93] sweet milk, producing a curd that looks like that formed in the acid fermentation of milk. The cause of these sweet curdling milks, which appear from time to time, is due to the introduction of certain bacteria which have the power of secreting an enzyme resembling that found in rennet. In such cases the milks curdle prematurely especially when warmed. The curd may gradually disappear, for the bacteria also produce another enzyme that digests the curd, and thus renders it soluble. When this advanced phase becomes evident, it is often called the digestive fermentation of milk. This change is produced largely by putrefactive bacteria of various kinds that find their way into milk with dust and dirt. Many of them are spore formers; hence, are not killed when milk is heated, as in pasteurization, while the acid-formers are destroyed. Pasteurized milk is thus likely to undergo the sweet-curdling fermentation, if it is kept for any length of time. Raw milk rarely undergoes this type of decomposition, since the rennet-forming bacteria under ordinary conditions are unable to develop in competition with the acid-forming bacteria.
Butyric acid fermentation of milk. A fermentation that is much less frequently noted than the two previously discussed is known as the butyric fermentation, since butyric acid is the principal by-product. The causal bacteria cannot compete with the ordinary acid-forming bacteria in raw milk; hence it is most frequently noted in pasteurized milk, since the organisms produce spores and are not killed by the heating. Pasteurized milk under the action of the butyric acid bacteria undergoes a gassy fermentation, developing a pronounced acidity and the disagreeable odor of butyric acid, which resembles that of rancid butter. The butyric acid bacteria[Pg 94] are anaerobic, and thus can grow in butter and cheese away from the air.
Slimy or ropy fermentation of milk. A slimy or ropy condition of milk is frequently noted on the farm and in the dairy. Several causes for this abnormal condition exist. Sometimes the milk may be slimy when milked from the cow. This occurs most frequently in the case of inflammation of the udder which may or may not be due to bacteria. The direct cause of the abnormal condition in milk is the presence of fibrin and white corpuscles from the blood which form masses of slimy material; in such cases the trouble does not increase in intensity with age, nor can it be propogated by transference to another sample of fresh milk.
 Fig. 22.—Slimy Milk.
Fig. 22.—Slimy Milk.Another type of slimy milk is produced by the growth of certain types of bacteria which enter the milk after it is drawn from the udder. These may come from various sources. The bacteria concerned belong to two groups: (1) those that grow best in the air and do not form acid; (2) those that grow in the absence of air, throughout the entire mass of milk and which form acid. The slimy condition is noted in the milk only after the milk has been stored for some time; it usually increases with the age of the milk and[Pg 95] can be produced in a second sample by transferring a little of the slimy milk to it.
The fermentation produced by the aerobic bacteria is most often met in bottled milk and cream during the warmer times of the year. On account of their relation to oxygen, the growth is confined to the surface of the milk and only the upper layer becomes slimy; thus when the cream is removed, the abnormal condition is noted. The sliminess is due to the mass of bacterial growth rather than to the production of any specific substance in the milk. This trouble may be of considerable economic importance to the dealer, as such abnormal milk is objectionable for ordinary use, but as far as is known, it is incapable of affecting the health of the consumer.
In numerous outbreaks of this trouble the source of contamination has been traced to infection from well water or a stream, as the organisms causing the trouble are found naturally in water. Keeping the milk in a tank in the pump house sometimes permits of troubles of this sort, the water used for cooling giving opportunity for contamination. Cattle wading in a stream sometimes pollute their udders and so indirectly infect the milk. Such outbreaks rarely persist for any considerable length of time as the common acid organisms soon regain the ascendency.
Creameries and cheese factories are sometimes troubled with sliminess in starters. This seems to be due to some change which the ordinary lactic acid bacteria undergo on long propagation rather than to contamination of the starter. There are, however, types of acid-producing bacteria that are able to form specific substances in milk that are slimy in character. Two of these forms of slimy milk are of economic importance. The slimy whey (lange[Pg 96] Wei) of Holland is added to milk in the manufacture of Edam cheese, apparently serving the same purpose as the addition of the pure culture starter in cheddar cheese making. In Norway, a sour, slimy milk (taettemjolk) is used as food. It is produced by the addition of some previously fermented milk. This beverage is also used in some of the Norwegian settlements of Wisconsin, the original seed having been brought from Norway, and the bacteria maintained by constant propagation from one sample of milk to another. The milk has the odor and taste of butter milk, but is not especially appetizing in appearance to any one not accustomed to it; it is, however, as harmless to health as is any other form of sour milk. It is not known that any of these forms of slimy milk are distinctly harmful to the quality of butter or cheese.
Alcoholic fermentation of milk. The bacteria as a class are incapable of producing alcohol in appreciable amounts. The alcoholic beverages, beer, wine, and cider, are produced by the growth of yeast, in such sugar containing liquids as fruit juices, extracts of grains, etc. The common types of yeasts are incapable of acting on milk sugar, but they can ferment glucose, maltose, and cane sugar, forming equal amounts of alcohol and carbonic acid gas, which causes the effervescence of fermented and carbonated drinks. There are, however, some types of yeasts found in milk and its products that are able to ferment milk sugar.
All yeasts grow best in an acid medium, hence those fermenting milk sugar find suitable conditions for growth in sour milk or whey. They may at times become of economic importance in the cheese industry, because of the contamination of the milk with large numbers of[Pg 97] them. The arrangement of the whey vat is often such that it cannot be completely emptied and cleaned; the sour whey thus presents favorable conditions for the growth of the lactose-fermenting yeasts. The return of the whey to the farm in the milk can that is often imperfectly cleaned may serve to contaminate the milk with the yeast. In the making of Swiss cheese the whey is often so handled as to favor especially the growth of such yeasts, and since this type of cheese is prepared from sweet milk, the competition between the yeast and the acid-forming bacteria is not so sharp as in the making of cheddar cheese. The writers have found several instances where considerable loss was occasioned in the Swiss cheese industry through the development of gassy cheese due to this type of fermentation.
The yeasty or alcoholic fermentation may also be of importance in butter making. In many sections of the country the milk is separated on the farm and the cream is forwarded to the creamery at more or less infrequent intervals. It becomes sour and if it has become contaminated with yeasts, they will find favorable conditions for growth in the acid medium. A large amount of carbon dioxide gas is produced. Cans of gathered cream often foam to such an extent as to run over, and in some cases actual explosions have occurred on account of the great pressure caused by the gas.
Bitter fermentation of milk. Bitterness in milk may be due to bacteria that enter the milk after it is drawn from the cow, or it may be caused by the feed consumed by the animal. It has been previously shown that certain specific substances contained in the food may be absorbed and reappear in the milk. If the animal eats[Pg 98] ragweed, lupines, or other plants containing bitter substances, the milk is likely to have a bitter taste, which will be noticeable at the time the milk is drawn. The milk of cows at certain advanced stages of lactation may show a bitter taste, due to a change in the ash constituents of the milk in which the lime salts are largely replaced by salts of sodium.
There are many bacteria that will impart to milk a bitter taste. Milk that has undergone the sweet-curdling fermentation is likely to be bitter, as is the ease with pasteurized milk. Some of the acid-forming bacteria are able to develop a bitter principle, the milk retaining a pleasant odor and having the normal amount of acid, while the taste is intensely bitter. One of the authors (H) found in the case of a Wisconsin brick cheese factory, that the usual acid organism was almost wholly replaced by a bitter type.
Storage of milk at very low temperatures is conducive to the appearance of a bitter taste in milk, the explanation in this case being that the acid-forming bacteria are unable to grow at a low temperature, while some of the putrefactive forms can multiply and develop these astringent or bitter by-products.
Miscellaneous fermentations of milk. There are a number of other abnormal fermentations in milk that occur so rarely as to be of but little economic importance. Some, as the colored milks, are however, quite striking, and on this account have had much attention directed to them in the past. There are bacteria that are able to produce various colored substances, such as red, yellow, and blue. In case milk becomes seeded with large numbers of any of these kinds, it is very likely to be colored[Pg 99] by the growth. Red milk may be due to bacteria, but more frequently is caused by the actual presence of blood in the milk, due to a wound in the udder, or the effect of a severe case of inflammation of this gland. Such a condition may be readily distinguished by allowing the milk to stand for a short time, in which case, if due to blood, the red corpuscles will soon settle to the bottom of the container, while bacterial troubles producing a red coloration are more evident on the surface.
It is also claimed that certain bacteria may impart a soapy taste or turnip flavor to milk.
Cycle of fermentations in milk. If a sample of milk is allowed to stand, it will undergo a certain sequence of fermentations that well illustrates the principle that one type of organisms is dependent on some other type to furnish suitable conditions for its development. This cycle of changes that normally occurs in milk is as follows: (1) The bacteria that come from the interior of the udder are the first to develop, but usually the change they produce is not evident.
(2) Of the types that gain admission, subsequent to the milking, the acid-producing species are able to adjust themselves most perfectly to the conditions that obtain in milk. Within a few hours they greatly predominate and soon the milk curdles under the production of acid. Their growth, however, is soon stopped by the accumulation of their own by-products.
(3) The semi-solid curdled milk, on account of its acid reaction then becomes a favorable medium for the growth of molds; a prevalent form, known as Oidium lactis usually develops as a white velvety layer. The molds in their growth form alkaline by-products, which tend to neutralize the acid reaction, so that in the course[Pg 100] of two to three weeks, if the layer of the milk is not too deep (an inch or less), the chemical reaction of the milk becomes neutral or alkaline.
(4) The putrefactive bacteria which found their way into milk when it was first drawn, and which have remained dormant in the sour milk, now find favorable conditions for growth. As a result of their activity, the milk soon undergoes a putrid decomposition, which is marked by offensive odors.
If the milk is placed under such conditions as will exclude the growth of the mold, such as where the air is excluded from the surface, the sour milk will remain in that condition for an indefinite period, since the putrefactive bacteria are inhibited in their development by the acid, in a manner comparable to the preservation of pickles in vinegar, or the keeping of silage because of the acid that is produced as a result of the changes that the plant tissue undergoes when excluded from the air. The preservative effect of acids is of much importance in the case of certain dairy products (see Chapter VIII).
Fermented drinks from milk. Within the last few years a great deal of attention has been directed toward the preparation of various kinds of drinks from milk. The use of such beverages has rapidly increased. Butter milk is one which meets with the greatest approval. The true butter milk from cream that has been soured by the desirable acid-forming bacteria has a mild agreeable acid taste, wholly free from any sharpness that is often noted in butter milk made from cream in which considerable numbers of the undesirable acid-forming bacteria have grown. Butter milk made from pasteurized cream soured with pure cultures will have good keeping qualities and is a most healthful drink for all classes of people, even for young children.
Butter milk is also prepared by allowing milk to sour and then breaking up the curd by stirring. If the type of fermentation is controlled as may be done (see Chapter VII), such a form of fermented milk is a most desirable drink. It is probably as healthful and has all the therapeutic properties that are ascribed to other forms of fermented milks such as the Bulgarian "Yoghurt."
This type of fermented milk is produced by an acid-forming organism that can form large amounts of acid, 2.0 or 3.0 per cent. The casein is dissolved to some extent and the remainder so changed, that it will remain in suspension for a long time in a finely divided form, after the curd has been broken up. Such milk is sold under various names at home and abroad. One of the authors (H) has found such organisms in practically all milks examined. If raw milk is kept warm (98° to 100° F.) in a stoppered bottle which is filled full, the acidity will be found to increase slowly from day to day, reaching a maximum in ten to fourteen days. If the milk is then examined, it will be found to contain large numbers of an acid-forming organism very different in appearance from the bacteria causing the rapid souring of milk at ordinary temperatures. This organism is very similar if not identical with the one found in the Bulgarian milk to which the name B. Bulgaricus has been given. The use of the milk fermented by this organism has spread rapidly because it is claimed by certain European bacteriologists that it has a favorable effect on the health of people, especially those suffering from intestinal troubles. It is not at all certain that ordinary sour milk or butter milk will not have the same effect; in fact in many of the fermented milks sold in[Pg 102] Europe, B. Bulgaricus has not been found, but only the ordinary lactic acid bacteria.
Several alcoholic drinks made from milk, such as kefir and koumiss, have been originated among the nomadic tribes of Western Asia. Kefir is prepared from cow's milk by adding the kefir ferment in the form of grains which contain a number of kinds of bacteria and a yeast. The acid-forming bacteria impart a sour taste to the fermented milk, while the yeast forms carbon dioxide and about two per cent of alcohol. If the milk is allowed to ferment in stoppered bottles, the resulting product will be an acid effervescing drink, which is claimed to be more easily digested than sweet milk. This drink is used frequently in the treatment of invalids but it is improbable that it is more easily digested than ordinary soured milk or butter milk. The grains are removed from the fermented milk, and are then added to a quantity of fresh milk, or they may be dried and kept for future use. When needed again, they are soaked in water, then added to the milk.
Koumiss is made in Russia from mare's milk and has much the same composition as kefir. In America and Europe it is made from cow's milk, by adding cane sugar and compressed yeast. The yeast ferments the cane sugar while the acid-forming bacteria ferment the milk sugar. There is thus obtained a drink that is similar in composition to the real koumiss, in which both the acid and the alcohol come from the fermentation of the milk sugar. In koumiss and kefir the curd is very finely divided and will remain in suspension for a long time as with butter milk.
Determination of the cause of taints in milk. It is often of the greatest importance to be able to locate the[Pg 103] cause of abnormal odors or tastes in milk, since methods for overcoming the trouble can be intelligently applied only when the actual cause is known. An abnormal condition may be caused either by the direct absorption of odors before or after the milk is drawn from the animal, or it may be due to bacteria. If the milk appears bad-flavored when first drawn, and if such taint becomes less pronounced as the milk becomes older, it is likely that the trouble is due to some characteristic of the feed. Certain feeds, like green rye, rape, cabbage, and certain of the root crops, like turnips, impart a strong odor to milk, if the same are fed shortly before milking. If the tainted condition appears only some time after the milk is drawn, it may be due to the direct absorption of taints from the surroundings in which the milk is kept, or it may be caused by bacteria. These causes can often be differentiated, by noting whether the taint tends to increase in intensity with age. If such is the case, it is likely that the cause is of germ origin, but if the reverse is true, it cannot be ascribed with certainty to bacteria and recourse must be had to other methods, such as the transfer of a small quantity of the tainted milk to a sample of perfectly fresh milk, or preferably to some milk that has been heated to the boiling point and then cooled. In the case of an odor due to direct physical absorption, it will not appear in the inoculated sample, since the small amount transferred is not sufficient to be noted. If it is due to living organisms, the inoculation of the smallest quantity into a fresh sample is likely to reproduce the same change as originally noted.
Tests for the bacteriological condition of milk. Within certain limits milk can be indirectly examined as to its bacterial content without any special equipment.[Pg 104] Milk when drawn from the cow has an apparent acidity ranging from 0.16 to 0.18 per cent. By the use of any of the methods of determining acidity in milk, much can be told concerning the number of bacteria in the milk, and hence concerning its keeping quality. Milk that has an acidity of over 0.2 per cent is certain to contain many bacteria, and consequently will keep poorly. Such milk is of low value for market milk, but may not be objectionable for butter or cheese making. If the acidity is below 0.2 per cent, but little can be told as to the numbers of bacteria, since any increase in acid is always preceded by an enormous increase in the numbers of acid-forming bacteria.
A more important test than the acid test, from the standpoint of the butter and cheese maker, and even the milk dealer, is the fermentation test. In its simplest form, it consists in placing a sample of the milk to be tested in a warm place and noting the time required to curdle and the type of curd formed. In this country the fermentation test has been largely supplanted by the Wisconsin curd test which possesses the advantage of detecting the presence of bacteria harmful in cheese making, especially the gas forming bacteria.
The curd test is helpful in detecting the source of an abnormal condition in a milk supply coming from diverse sources. The milk furnished by each patron can be tested separately and the trouble located, perhaps in an individual herd; the offending herd determined, the test may then be used on the milk of individual cows. The cheese maker and the milk dealer should be able not only to detect which of the patrons furnish him poor milk, but he should be able to give the patron definite instructions how to avoid the sources of such trouble. This information[Pg 105] can be given only when the source is positively known.
 Fig. 23.—Curd Test.
Fig. 23.—Curd Test.The Wisconsin curd test is made as follows: Samples of the milk to be tested are placed in sterile pint fruit jars. The milk is warmed to 90° F., ten drops of rennet are added to each sample, and as soon as the curd is solid, it is cut into small pieces with a case knife so as to facilitate the expulsion of the whey. As the curd settles to the bottom of the vessel, the whey is poured off at intervals so that a pat of firm curd is left. As the milk curdles the bacteria are enmeshed and are carried[Pg 106] with the curd. The jars are kept at a temperature of 100° to 105° F., since this temperature is favorable to growth of the bacteria that are sought, the gas-forming organisms. At the end of ten to twelve hours, the jars are examined; if the curd is solid, the texture firm, not mushy or slimy on the surface, if the odor is agreeable, it indicates that the milk contains few or none of the undesirable forms of bacteria. If the curd is full of gas holes, it is apparent that undesirable bacteria are present and under such circumstances the curd will not have[Pg 107] an agreeable odor. If the gas-forming bacteria are numerous, the curd may even be spongy from the abundance of gas holes, and the undesirable odor more pronounced. Such curds are tough and rubbery. In some cases a bad flavor or odor is apparent even though the texture of the curd is not open and full of holes. The curd, the surface of which is slimy indicates undesirable organisms. A solid curd of agreeable odor is indicative of the presence of the desirable acid-forming bacteria. Such a milk is excellent from the standpoint of the butter or cheese maker, but may not be so desirable from the standpoint of the milk dealer on account of its poor keeping qualities. On the other hand a milk suitable from the standpoint of the milk dealer, on account of its low germ content, and hence good keeping quality, may give a poor curd test. It is certain to contain some bacteria, especially those from the interior of the udder while it may contain none of the desirable acid-forming organisms without which a curd of good texture and flavor can not be obtained. The bacteria in the clean milk will grow rapidly at the high temperatures at which the curds are kept and the changes they will produce as to flavor and odor may be undesirable. The milk might be judged as poor when in reality it might be a most excellent sample, and if kept at the ordinary storage temperatures, it might keep for days. The test when used for market milk should be interpreted with this in mind.
 Fig. 24.—Curd Test.
Fig. 24.—Curd Test.If the results are to be of any value, the test must be made with care to avoid all sources of error; the tester must know that the bacteria causing the gas and bad flavors in the sample were originally present in the milk at the time the sample was taken, and that they have not come from the containers used or from other sources.[Pg 108] To insure these conditions the jars must be thoroughly cleaned and then sterilized just before use by placing them in cold water and bringing them to the boiling point, or sterilized by a thorough steaming. The sample of milk of a patron must be taken so as to avoid contamination from the milk of the other patrons. This can best be done by filling the jars as the milk is poured from the patron's can into the weigh can. In cutting the curds, the knife used must be dipped in hot water between each test to cleanse the same. In short, the test should be carried out with great care so that the tester is certain of the results obtained.
Other tests for the bacteriological condition of milk will be described in Chapter IX.
Overcoming abnormal fermentations. The lactic acid bacteria are often looked upon as normal to milk, and it is certain that they are to be classed as harmful, only as they injure the keeping qualities of milk. In milk designed for butter and cheese their presence is necessary. At times these desirable forms of bacteria may disappear, and be replaced by less desirable types. In one case it was observed that the usual lactic bacteria had been replaced in a cheese factory supply by an acid-forming organism that produced an intensely bitter taste in the milk, thus rendering the cheese of no value. When such harmful forms appear, they must be overcome, and the normal types of bacteria replaced. A thorough cleaning of the milk utensils, attention to the cattle and all places from which such bacteria may find their way into the milk is often sufficient to cause a disappearance of the trouble. If the acid-forming bacteria have disappeared, the inoculation of the milk with cultures in ways later to be discussed is often of advantage.[Pg 109] At times more stringent measures must be employed in order to destroy the harmful bacteria, such as the use of strong disinfectants.
Disinfection and disinfectants. If any building or room becomes infected with disease-producing bacteria, or if organisms causing abnormal fermentations become established in a factory, the use of a disinfectant that will destroy with great rapidity the life of bacteria is necessary. The disinfection of all types of dairy apparatus and utensils can be accomplished by thorough cleansing, and by the use of steam or boiling water. The disinfection of rooms and stables cannot be so readily accomplished.
Consideration must always be given to the resistance of the organism it is desired to destroy. Those that form spores are very resistant toward all chemical agents, while those that do not produce these resistant bodies are easily killed. In the dairy and factory, it is often necessary to destroy the organisms that develop in decomposing organic matter. Here, as in all disinfection, a thorough cleaning should precede the application of any disinfectant. Some chemicals act as deodorants, i.e., destroy the offensive odor, without removing the cause. It is impossible effectually to destroy bacteria embedded in a mass of organic matter, and through the removal of the material itself, the larger part of the bacteria will be removed. The disinfectant then comes in direct contact with the surface to be disinfected, consequently destroys the bacteria not removed in the cleaning.
All places in which dairy work of any kind is done should be provided with an abundance of light and air.[Pg 110] The direct rays of the sun have a powerful disinfecting action, and light makes evident accumulations of dirt that in a darker room would be unnoticed. Ventilation keeps the rooms dry and thus prevents the growth of mold and the development of a musty odor.
Disinfectants are divided into two classes: (1) solid materials used in suspension, or in watery solutions; (2) gaseous substances. The latter are preferable for room disinfection when their use is permissible, for the gas penetrates to every part of the space, even into the cracks. Gaseous disinfectants can only be used when the space is tightly closed, for the gas must be confined for several hours in the room, in order to make the process effective. Such disinfectants can often be used to advantage in the treatment of refrigerators and cheese rooms to destroy mold spores. In less tightly closed spaces, reliance must be placed on the use of the solid or liquid disinfectants.
Lime. Quick lime or stone lime has a considerable disinfecting action. On exposure to the air, quick lime becomes air slaked, and then has no disinfecting action whatever. Water-slaked lime used in the form of white wash, lime water, or the powder is effective. Air-slaked and water-slaked lime are similar in appearance, but a difference can be noted by placing a particle of each on the tongue; the air-slaked tastes like chalk while the water-slaked material causes the tongue to burn.
White wash is one of the most effective agents that can be used in the disinfection of barns, milkrooms, etc. Besides being a fairly strong disinfectant, it has a tendency to absorb odor, it encrusts the walls and lightens the interior of rooms. It can be applied with a brush or with a spray pump.
Carbolic acid and cresol compounds. These substances are among the cheapest and best disinfectants, but their use in the dairy is not advisable, on account of the penetrating and lasting odor. They can be used to advantage on the farm. Some of the proprietary compounds, as Zenoleum, Kresol, etc., are easily applied, since they mix readily with water in all proportions, forming a milky-white emulsion that can be easily applied. They are less caustic and less poisonous than carbolic acid.
Corrosive sublimate. Corrosive sublimate is the most efficient disinfectant under ordinary conditions. It is such an intense poison that it must be used with caution in places to which stock have access, or in the dairy. A solution of one part of the salt to a thousand parts of water (half ounce to 4 gallons of water) is the standard generally used.
For gutters, drains, and waste pipes in factories, ferrous sulphate (green vitriol), and copper sulphate (blue vitriol), can be used to advantage. They are to be classed as deodorants rather than as true disinfectants. Since they have no odor of their own, they can be used in any amount in the dairy.
Sulphur can be used to advantage in the destruction of mold spores in cheese rooms, but the effect of the vapors of burning sulphur on germ life is relatively slight, unless there is an abundant supply of moisture in the air of the enclosed space, in which case sulphurous acid is formed which has a much greater effect. To have the desired effect sulphur should be burned at the rate of three pounds to each one thousand cubic feet of space, and the room kept sealed for at least twelve hours. If the sulphur is placed in an iron kettle which is set in a[Pg 112] vessel of water, danger from fire will be avoided, and the heat generated by the burning sulphur will evaporate sufficient water to increase the effect of the fumes.
Formalin. Another disinfectant that may be used as a liquid or as a gas is formalin, which is a watery solution of the gas, formaldehyde. It is much more powerful in its action than sulphur, and has a great advantage over corrosive sublimate and other strong disinfectants in that it is not so poisonous to animals as it is to bacteria and fungi.
It can be used as a solution (one to five per cent) for the washing of woodwork, or for the treatment of any object, since it has no corrosive action. It can also be employed as a gaseous disinfectant for the treatment of rooms. It is most conveniently applied by suspending large cloths in the room and spraying them with the solution, then closing the room for a number of hours.
Bleaching powder. Chloride of lime, or bleaching powder as it is often called, is a good disinfectant, as well as a deodorant. It is used as a wash in the proportion of four to six ounces to a gallon of water. It must be used with care in factories since the free chlorine that is given off has a penetrating odor.
PRESERVATION OF MILK.
It has been shown in a previous chapter that milk becomes contaminated with a multitude of bacteria not only on the farm where it is produced, but during the various stages prior to its use. Many of the bacteria which find their way into milk are readily able to develop, and by their growth, render the milk unfit, or even harmful for human food. With the most stringent precautions that can reasonably be taken, it is impossible to avoid all contamination; hence, all grades of milk will soon spoil, unless some means of preservation is employed. Indeed, of all the foods classed as perishable, milk is the one that most rapidly deteriorates. Produced under ordinary conditions, it is unfit for ordinary use in a few hours if kept at 70° F.
There are three possible ways by which milk may be preserved: (1) The removal of bacteria that have gained entrance to it; (2) The prevention of growth of the contained bacteria; (3) The destruction of the contained organisms. In practice at least two and sometimes all of these methods are employed. The prevention of contamination, a subject discussed in Chapter III is in reality one of the most efficient means of preserving milk. In milk production, as elsewhere, prevention is preferable to cure. Milk produced under such conditions that its germ content is but a few thousand per cubic centimeter will keep much longer than that handled in the ordinary manner.
It might naturally be supposed that any method by which dirt is removed from milk would improve the keeping quality of milk, due to the reduction of bacteria, yet while the straining of the milk at the time of milking removes dirt of various kinds, it does not appreciably enhance the keeping quality, owing to the fact that the bacteria adherent to the dirt particles are washed off in straining, and pass through the pores of the strainer.
Filtration of milk. It is possible to remove all bacteria from water and other fluids and thus render them sterile by passing through filters of unglazed porcelain. This process can not be used with milk for the fat globules are larger than the bacteria (see Fig. 6) and any process that would remove the latter would also remove the former. The term "filtration" is applied to a process used in some European cities for the removal of the insoluble dirt that has been introduced into the milk. Suitable containers are filled with layers of coarse sand at the bottom and with finer sand at the top. The milk is introduced at the bottom and is forced upward through the sand. Such a filtering process is a very efficient means of removing the dirt; but unless the filters are kept scrupulously clean, the bacteria are likely to grow in the filtering material, so that the number of organisms in the milk may actually be increased by the filtering process. It is necessary to remove the sand daily and thoroughly wash and sterilize the same. The extra care required in keeping these sand filters in sanitary condition has been the great objection to their employment in this country. Filters of other material such as cellulose have been employed but with no marked success.
Clarifying milk. A much more efficient and less troublesome means of removing the insoluble foreign particles from milk is to pass it through a cream separator, allowing the cream and skim milk to mix in the same container. The slime that collects on the wall of the separator bowl is made up of dirt, casein, bacteria, and the cellular debris from the interior of the udder. The bacteria are heavier than the milk serum, and would, therefore, be deposited on the wall of the bowl were it not for other factors that in a measure prevent this. The movement of the fat toward the center of the bowl carries into the cream a considerable proportion of the bacteria in the milk. The slime will always contain many more bacteria than the milk, but the per cent of bacteria thus removed is relatively low, due to the small amount of slime obtained from the milk, so that the actual effect of clarification on the keeping quality of milk is insignificant. The complete removal of all insoluble and therefore visible dirt is, however, regarded of sufficient value to warrant the use.
Machines designed especially for the clarification of milk are now widely used. They differ from the cream separator in that the milk is introduced at the outside of the bowl and hence there is no separation of the fat from the serum. It is claimed that the removal of the dirt, cells from the interior of the udder and bacteria is as efficiently done as when the separator is used. The advantages claimed for the machine are that it has no effect on the subsequent gravity creaming of the milk and that less power is demanded than for the separator.
From the standpoint of the consumer, all processes by which dirt is removed from milk are objectionable, since[Pg 116] they make the milk appear cleaner and better than it really is, the harm having been done when the dirt with the adherent bacteria found its way into the milk. The removal of the foreign matter that has been introduced into the milk will have but little effect in reducing the number of bacteria, since a large part of the organisms will have been washed off the insoluble material. All of these processes improve the appearance of the milk but have little or no influence in increasing its keeping quality or its healthfulness.
Preservation by cold. The only legitimate way of preventing the growth of bacteria in milk is by holding it at temperatures at which the ordinary forms of bacteria cannot thrive. Bacterial growth is greatly checked at temperatures approximating 50° F., or below, although certain types multiply at the freezing point or slightly above. If food products are actually congealed, no germ growth occurs, and they may be kept quite indefinitely, but this process cannot be successfully applied to milk, as the fat and casein are physically changed, so that a normal emulsion can not again be made when the frozen milk is melted. The fat separates in visible masses as though the milk had been partially churned. On account of this fact milk must be stored at temperatures above the freezing point. In Denmark efforts have been made to preserve milk, that is to be shipped long distances, by freezing a portion of the milk, and placing a block of the frozen milk in each can after cooling the main mass of milk nearly to the freezing point. Even this method has not proven practical, and at present reliance is placed on thorough chilling of the milk. At 32° F., the lactic bacteria cannot grow, but other types,[Pg 117] such as certain of the putrefactive forms grow slowly; the milk may, therefore, have no objectionable odor or taste and yet be swarming with bacteria. In cities the practice is followed of placing cream in cold-storage during the cooler periods of summer in preparation for an increased demand, during hot weather or on holidays. It seems probable that poisoning from ice cream may, at times, be due to the use of such cream.
Preservation by the use of antiseptics. Many chemical substances prevent the growth of bacteria when added to food supplies; such substances thus used are called preservatives. In the past some of these have been used in milk to a great extent, but at present, on account of stringent pure food laws, they are employed only to a slight extent. There is a great temptation for the small milk dealer in the city to employ them to preserve the excess of milk from day to day, as through the use of a few cents worth of some preparation, many dollars worth of milk may be kept from spoiling until it can be sold to the unsuspecting consumer.
Formalin has been most widely used in milk because it is a most efficient preservative; it is cheap and cannot be detected by the consumer, although it injures the digestibility of the casein. One ounce will keep one thousand pounds of milk sweet for twenty-four to forty-eight hours. Borax, boric acid, and salicylic acid have also been used, but these substances must be employed in much larger quantities than formalin. Bicarbonate of soda has sometimes been used although it is not a true preservative. Its effect is based upon the neutralization of the acid produced by bacterial growth. The treated milk does not taste sour so quickly, and the curdling of the milk is also delayed.
Many proprietary compounds for milk preservation have been placed on the market in the past, but the use of all of these is illegal in most states. The federal law also prohibits their use in all dairy products that pass into interstate commerce.
Within recent years a method for the preservation of milk was introduced by a Danish engineer, Budde, which consists of adding to milk a very small amount of peroxid of hydrogen which is a very efficient antiseptic. The peroxid is decomposed by some substance in the milk; the products of decomposition being water and free oxygen. The peroxid together with the application of heat at a comparatively low temperature (122° F.) is sufficient to destroy the larger part of the bacteria in the milk. Practical difficulties are encountered in the commercial application, so that it is probable the process will never be a commercial success.
For the preservation of composite samples of milk for analytical purposes, such as the Babcock test, strong disinfectants, as corrosive sublimate, are employed. This material is very poisonous, and leaves the milk unchanged in appearance. Some coloring matter is therefore usually mixed with the sublimate in making the preservative tablets, so as to render their use more conspicuous. Corrosive sublimate not only stops all bacterial growth, but quickly destroys the life of the cells. Bichromate of potash is generally employed in the preservation of composite samples for the Hart casein test.
Destruction of bacteria in milk. Actual destruction of the life of bacterial cells by heat is one of the most important ways for preserving milk. Heat easily destroys the vegetating, growing bacteria, while the spores, of which there are always a number in milk, are very[Pg 119] resistant. If, however, the growing organisms are destroyed, the milk will keep much longer than if it had not been so treated.
The process of pasteurization was first used by the French bacteriologist, Pasteur, for the treatment of the wines of his native district which were likely to undergo undesirable types of fermentations due to bacteria. From the wine industry it was applied in the brewing industry, and was later found to be of the greatest service in the dairy industry. The process of pasteurization may be briefly defined, as the heating of milk to temperatures, varying from 140° F. and upward for a longer or shorter time, and subsequently cooling to a low temperature, so as to prevent the germination of the spores that are not destroyed by the heating.
Effect of heat on milk. When milk is heated it undergoes more or less profound changes, depending on the temperature and time of heating. Some of these changes are of practical importance, since they are more or less evident, and objectionable to the consumer.
In raw milk the fat globules are largely found in larger or smaller aggregates, rather than uniformly distributed throughout the serum. The surface of a mass of fat globules is smaller in proportion to the volume of the mass than is the case with single globules, hence globule clusters encounter less resistance in their passage through the serum, either as they rise to the surface in gravity creaming, or in the separator bowl. If these clusters are broken up, so that the globules are uniformly distributed, the milk will cream much less rapidly and completely. In the process known as "homogenization" of milk, the individual fat globules are broken into such small globules, that they cannot overcome the viscosity[Pg 120] of the serum, and they remain distributed throughout the milk. In such cases, no cream rises, and even the cream separator is unable to remove the fat from such milk.
In selling bottled milk, it is highly desirable that the cream line should show distinctly. In normal milk, this line forms in a few hours, but where milk is heated to a high temperature, and agitated at the same time, the clusters of fat globules are broken apart and the creaming power injured. This physical change is dependent not only on the temperature, but also on the time of exposure. A momentary exposure at 160° F., or for 20 minutes at 145° F., is about the maximum limit which can be applied to milk without material injury to the creaming property.
 Fig. 25.—Fat Globules in Raw Milk.
Fig. 25.—Fat Globules in Raw Milk.The body or consistency of pasteurized cream may be restored by allowing the cream to stand for several days[Pg 121] at low temperatures, or by the addition of a small amount of sucrate of lime. This substance, known to the dairy trade as "viscogen," is made by adding to a thick solution of cane sugar, some freshly slaked lime. The sugar solution permits of the dissolving of a much larger amount of the lime than is possible in water. When the liquid is allowed to settle, the clear solution is then decanted off and is used at the rate of about one part to 100 to 150 parts of cream. The fat globules are, by its action, brought into aggregates and the body of the cream thus restored. Viscogen contains nothing that is at all harmful, but milk and cream to which it is added must be sold under some distinctive name as "visco-cream," since the laws of practically all states do not allow the addition of any substance whatever to milk or cream.
 Fig. 26.—Fat Globules in Heated Milk.
Fig. 26.—Fat Globules in Heated Milk. Fig. 27.—Creaming of Milk.
Fig. 27.—Creaming of Milk.Heated milk has a taste unlike that of raw milk; to one not accustomed to it the taste is objectionable. This change is due to some extent to the expulsion of the carbon dioxide from the milk. The insipid taste of boiled[Pg 123] water is, in part, due to its freedom from carbon dioxide. The production of this cooked flavor is dependent upon the time and temperature of exposure. It has been claimed that heated milk is less digestible than raw, and a considerable amount of experimental work has been done, both on animals and children, in order to determine the relative digestibility of heated and raw milk. The results obtained have been contradictory. It is claimed that heated milk causes such diseases as rickets, scurvy and marasmus in children. It is probably true that milk heated to the boiling point is less fitted as food for the young child than raw milk, but, on the other hand, it has not been proven that properly pasteurized milk is an unsuitable food for children. The best evidence has been accumulated in recent years, in many of the large cities of this country and of Europe, where pasteurized milk has been used with the greatest success in the feeding of children of all ages.
The heated milk does not curdle readily when rennet is added due to the precipitation of the lime salts by heat. The curdling power can be restored by the addition of soluble lime salts or of acids.
Purpose of pasteurization. There are two reasons for the pasteurization of milk: (1) To improve the keeping quality; (2) To destroy any pathogenic bacteria it may contain. The first may be called the economic reason; the second, the hygienic reason fur pasteurization. In the selection of a proper pasteurizing temperature, two factors must be taken into account: First, the effect of heat on milk, and second, the temperature necessary to destroy those forms of bacteria that are of the greatest importance, as far as the keeping properties are concerned, and the pathogenic bacteria that might possibly[Pg 124] be present in the milk. The lactic acid bacteria are non-spore-bearing and are not resistant to heat. Most of them are destroyed when the milk is heated to 140° F. for fifteen minutes or to 160° F. for a moment. To insure proper keeping quality, somewhat higher temperatures must be employed, such as 145° to 150° F. for fifteen to twenty minutes.
Milk pasteurized at these temperatures will, as a rule, undergo an acid fermentation in much the same manner as will raw milk. The rate with which the acid develops is of course much slower than in the raw milk, due to the destruction of 95 to 99 per cent of the acid-forming bacteria. If the milk has been pasteurized at higher temperatures, the acid fermentation may not appear. The spores of the spore-bearing organisms will be left; these may germinate and cause their characteristic change in milk, which, as previously noted, is usually a sweet-curdling or a digesting fermentation. Since the changes they produce in the milk are not evident at first, it might be used as food even though it was so far advanced in decomposition as to be undesirable or even harmful as food. Indeed one of the objections urged against pasteurization is that it destroys the natural safe guard, the acid-forming bacteria. Many people are so accustomed to use this as the indication of spoiled milk that they will use milk long after it should be used if it does not show an acid fermentation.
The butyric acid organisms are spore forming and may at times produce their characteristic fermentation in pasteurized milk. The milk shows gas formation and develops an objectionable odor.
The pathogenic bacteria most likely to be present in the milk are the typhoid and the tubercle organisms.[Pg 125] The typhoid bacillus is no more resistant to heat than the ordinary acid-forming bacteria, and all milk that has been heated, so as to impart to it satisfactory keeping properties, will certainly be free from typhoid bacilli. It has sometimes been asserted that the tubercle bacillus is very resistant to heat; some claiming that it is necessary to heat milk to 200° F. in order to destroy it. Other experimenters have asserted that lower temperatures would suffice, but the temperatures were still above those at which the milk is physically and chemically changed by the heating process. More recent work has shown that not all sources of error were avoided in the earlier attempts to determine the thermal death point of the tubercle bacillus, as, for example, it has been shown by the authors that the "scalded film" that forms on the surface of milk when heated in an open vessel will protect the bacteria imbedded in it. It has also been shown by the authors that a temperature of 140° F., for twenty minutes or 160° F. for one minute will destroy the tubercle bacilli in milk, in case the heating is done with sufficient thoroughness to insure all particles of the milk being heated to the same temperature for these periods of time.
The pasteurization of milk can be done in such a manner as to impart to it good keeping qualities and to insure its freedom from pathogenic bacteria, and yet not impair its physical and chemical properties, but much of the so-called pasteurized milk placed on the market is not treated in accordance with proper hygienic methods.
 Fig. 28.—The Pott's Discontinuous Pasteurizer.
Fig. 28.—The Pott's Discontinuous Pasteurizer.Methods of pasteurization. In order to destroy the bacteria in milk, it is necessary that the milk be heated for a varying time dependent upon the temperature employed. A lower temperature for a considerable period[Pg 126] may exert the same effect on the bacteria as a higher temperature for a shorter time. In practice, two types of pasteurizing machines are employed, depending on the temperature at which the milk is to be treated. The discontinuous machines or intermittently operated pasteurizers are those in which the milk is heated for any desired time at any temperature. Such machines consist of jacketed containers the inner receptacle being filled with milk, while the outer space between the walls is filled with circulating hot water or steam. The milk is kept agitated by the rotation of the machine. After it is heated, it is cooled in the same container by replacing the hot water first with cold water, then ice water. The disadvantage of this process is that the capacity of the machine is limited which precludes its use in places where large quantities of milk or cream are handled; for the pasteurization of limited quantities, it is very successful, as every particle of milk or cream is under the direct control[Pg 127] of the operator and may be thoroughly and efficiently treated.
As pasteurization was introduced for the treatment of market milk, and for the preparation of cream for butter, machines have been devised which permit large quantities, as thousands of pounds, to be handled per hour. It is evident under these conditions that the milk must be heated for only a short time, and hence a higher temperature must be employed. These machines are called "continuous flow" pasteurizers since the milk passes through them in a constant stream. The period of exposure is very short, in some only a few seconds; hence, they are sometimes called "flash" pasteurizers.
 Fig. 29.—A Continuous Pasteurizer.
Fig. 29.—A Continuous Pasteurizer.All machines of this type possess the obvious disadvantage that it is impossible to heat all of the milk for a uniform period. The milk in contact with the walls of the machine flows much more slowly than in the middle of the stream, just as the current near the bank is less rapid than in mid-stream. In none of the machines yet devised have the designers been able to overcome this disadvantage. In a test of one of the most widely used pasteurizers of this type, it was found that some of the milk passed through the machine in 15 seconds, while the larger part of it was held for about 30 seconds, and some as long as forty-five to sixty seconds. If the temperature employed had been such as to destroy the bacteria in that part of the milk heated for the minimum time, hygienic safety would be assured, but in order to avoid injuring the physical properties of the milk, the tendency is to use as low a temperature as possible, so that the milk heated for the minimum time may often contain organisms that have passed through the machine uninjured.
Many devices have been proposed for the heating and cooling of the milk. In many of the pasteurizers, the milk flows in a thin stream over a metal surface, on the opposite side of which is the heating agent, usually steam; while in others, the milk is allowed to flow through a vat in which revolve a series of discs into which steam is passed. The discs are of considerable size; thus, making a large heating surface; the milk is thus heated quickly, and is constantly stirred by the rotation of the heating discs. In other types the milk passes into the bottom of a chamber in which a dasher revolves at a rapid rate. This catches the milk, throwing it in a thin film onto the wall of the chamber, which is heated with steam on the opposite side. From such machines, of which the Fjord, the Jensen, and the Reid machines are types, the milk may be forced to a considerable height. These are widely used in this country for the pasteurization of milk and cream for butter making.
Milk that has been heated must be cooled at once by the use of cold water and ice. In order to economize in the use of both steam and cooling agents, the so-called regenerative machines were devised. The essential feature of these machines lies in the fact that the cold milk inlet and the hot milk outlet are on opposite sides of a single partition; thus the inflowing cold milk is partially heated by means of the already treated hot milk which it is desired to cool.
In order to avoid the disadvantages of the continuous machines, viz., lack of control, an apparatus has recently been devised which can handle large quantities of milk, heating the same to any temperature for any desired time. In such a machine the milk is first heated in a continuous heater, and is then passed into large tanks in which it is allowed to remain for the desired time, and[Pg 130] from which it flows over the coolers. Such an apparatus is called a "holding" machine, and is probably the most feasible type of pasteurizer now on the market, when all factors are considered. In some of the continuous machines, an attempt is made to accomplish the same result, by building the machine so that the milk requires fifteen to twenty minutes for passage through the machine, but in all such cases the same disadvantage of variation in rate of flow, as in other continuous flow type of machines obtains.
Tests of pasteurizing machines. It is possible for the operator to test the rate of flow in a machine, so as to determine whether all of the milk is heated for a uniform time. This is done most easily in the following manner: The machine is first filled with water, heating the same to the desired temperature, and regulating the rate of flow as it would be if milk was used. The flow of water is then turned off, and a stream of milk containing a known per cent of fat admitted to the machine. The time elapsing between the admission of milk to the machine, and that at which the first sign of turbidity is noted at the outlet, will be the minimum period necessary for any portion of the milk to flow through the machine. At frequent intervals thereafter, samples of the outflowing liquid may be collected, noting the time at which each sample is taken. The percentage of fat in the various samples is determined by the Babcock test; at the moment when all of the water has been removed, the sample taken will show the same fat content as the milk used. The samples taken previous to this will show a lower fat test, dependent upon the relative amount of water and milk. In this manner, the minimum, the maximum, and the average period of exposure of milk in the machine tested, can be determined with exactness.
The accompanying table gives results that were obtained in the testing of one of the continuous types of machines. The machine in question required about three hundred pounds of milk to fill it and was supposed to handle 1,000 pounds per hour. Thus theoretically it should require twenty minutes for any portion of the milk to pass through the machine. As will be seen from the data, some of the milk passed through within seven minutes after the water was shut off and the milk turned on. The figures also show that not all of the water had been replaced by the milk in even 45 minutes. In actual practice like results will be obtained, and a portion of the milk will be heated to the temperature employed but a short time. In this, the vegetating bacteria will not be wholly destroyed.
| Trial | Per cent of fat in milk | Per cent of fat in milk coming from machine at following times | |||||||
| MINUTES | |||||||||
| 7 | 11 | 15 | 19 | 23 | 27 | 36 | 47 | ||
| No. I | 4.0 | 0.2 | 0.8 | 1.6 | 2.0 | 2.4 | 2.6 | ||
| No. II | 3.8 | 0.2 | 0.6 | 1.5 | 1.8 | 2.2 | 2.6 | 3.0 | 3.4 |
| No. III | 3.5 | 0.7 | 1.9 | 2.4 | 2.8 | 2.8 | 3.0 | 3.4 | 3.4 |
Pasteurization of small quantities of milk. It is often desirable to treat a small quantity of milk for home use, in which case the commercial types of pasteurizers are out of the question. This treatment can be done in a number of ways, consideration always being paid to the manner of heating which should be done under such conditions, as have been shown to be necessary for efficient pasteurization. Milk may be heated in tall,[Pg 132] narrow cans which are placed in hot water. In the household, milk may be treated by placing the filled bottle in a pail having a false bottom so the bottle shall not be broken when the pail is placed on the stove. The pail should be filled with water so that its level is about the same as that of the milk. The water is then heated to the desired temperature, maintained for the requisite period of time, and is then cooled as rapidly as possible. During the heating, the mouth of the bottle should be covered, either with an inverted glass tumbler, or the paper cap may be left in place, simply punching a small hole through it so as to permit of the insertion of a thermometer.
 Fig. 30.—A Pasteurizer for Use in the Home.
Fig. 30.—A Pasteurizer for Use in the Home.Efficiency of pasteurizing. It is easy to destroy over 99 per cent of the bacteria present by the use of any of the modern types of machines. The number remaining after treatment will be largely dependent, other things being equal, upon the number of bacteria before pasteurization. The pasteurizing process is not one by which poor milk can be changed into good milk, nor is it legitimate to use the process in place of cleanliness, as is sometimes done. There is a legitimate field for the process in the handling of market milk, as well as in the creamery; but it should be used to improve the keeping quality, and to insure the freedom of the milk from pathogenic bacteria, when other protective measures have been carried as far as possible under the prevailing conditions.
Details of process. If the process is to be successful, due attention must be given to certain details. In the treatment of market milk, care should be taken to use only that in which the acidity has not materially increased. A fair standard is about 0.2 per cent. High acid milk usually means old milk or dirty milk, either of which is very likely to contain many more spore-bearing bacteria than clean, fresh milk. The greater the number of spores, the more rapidly will the pasteurized milk spoil. If it is possible to exercise any selection of milk prior to pasteurization, the rapid test for determination of acidity will prove of great advantage.
Care should be taken to prevent fluctuations in the temperature to which the milk is heated. With varying steam pressure and variations in the rate of flow of milk, these fluctuations may be very considerable. Regulators are now made that will control the temperature within narrow limits.
In all pasteurized milk as it flows from the machine, there will remain some living bacteria. The spores will not be destroyed by any pasteurizing process, and under commercial conditions, vegetating bacteria are also present. If the milk is not quickly chilled after heating, these forms will grow, and their development is particularly hastened by the destruction of the lactic bacteria, the acid of which would otherwise hold them in check. The result is that, unless immediately chilled, pasteurized milk spoils almost as rapidly as though it had not been heated at all. Efficient and rapid cooling are, therefore, as essential a portion of the process as the heating itself.
Care should also be taken to protect the milk from contamination after treatment. Every utensil with which it comes in contact should be sterilized. The bottles should be thoroughly washed and sterilized and subsequently protected from dust until used.
Sterilization of milk. It is possible to render milk sterile by the use of temperatures above the boiling point of water, where it is heated in a closed vessel, in which steam under pressure is generated. Such milk is often found in the European markets. In our own country, the only milk of this kind is the so-called "evaporated milk." In this process sweet fresh milk is evaporated in vacuum pans to about one-third of the original volume. This is then placed in tin cans, which are treated, as in the canning of such vegetables as peas and corn, by heating the milk to 230° or 240° F. for a few minutes. In this process, the bacteria (spores as well as vegetating forms) are completely killed, and the milk acquires a brownish tint, due to the caramelization of the sugar. The appearance of the product is very similar[Pg 135] to cream, and previous to the passage of the pure food law, it was sold as evaporated cream.
Condensed milk is not wholly free from bacteria, but is sufficiently thick, by reason of its treatment so that the contained bacteria cannot grow. They remain dormant in the milk, but as soon as it is diluted to a normal consistency, growth takes place, and the milk rapidly spoils. Condensed milk is prepared by adding cane sugar to fresh sweet milk, then evaporating the mixture to one-third the original volume, forming a semi-solid product. Syrups owe their keeping qualities to the same factor, as condensed milk, i.e., the high consistency.
Milk is also preserved by wholly evaporating the water, thus leaving a dry powder, which on being mixed with water again will have much the same properties as the original milk. Various methods have been devised for the preparation of these milk powders, all of which have been patented by the inventors. If the powder is to be kept for long periods, skim milk must be used, since the fat slowly undergoes changes which cause it to have a rancid odor. These dry preparations are largely used by bakers in place of fresh milk.
BACTERIA AND BUTTER MAKING.
In the making of butter it is necessary to concentrate the milk fat into a small volume. This process, known as creaming, may be accomplished by gravity, if the milk is allowed to stand undisturbed, the fat globules rising slowly to the surface. Much more rapid separation may be secured, by placing the milk in a rapidly revolving container in which it is subjected to centrifugal force, which causes the heavier parts of the milk to pass to the outside of the bowl, while the lighter part, the fat, collects at the center of the revolving bowl. There is an enormous number of fat globules in milk, over 5,000,000,000 in each cubic centimeter, and as these move through the milk serum, they carry with them many of the bacteria. The cream is thus much richer in bacteria than is the skim milk, or even the milk before separation. Besides the mechanical separation in the manner described, the method of creaming is of importance, in determining not only the number but also the kind of bacteria in the cream.
Methods of creaming. In the shallow-pan method of creaming, the milk is kept at ordinary room temperatures. These temperatures favor especially the growth of the acid-forming bacteria. The milk is usually sour by the time the cream is removed from it; consequently, the bacterial content of the cream is high. Moreover, the cream is exposed to air contamination, and is thus[Pg 137] seeded with molds, and those forms of bacteria that are always found in the air. The cream obtained in this manner is likely to contain not only numerous bacteria, but a great variety of forms, some of which undoubtedly are the cause of the poor keeping qualities of butter made from such cream.
In the more modern method of gravity creaming, in which the milk is placed in deep narrow cans kept in cold water, the conditions are not favorable for the growth of acid-forming bacteria. If the milk is produced under clean conditions, and is placed in cold water at once, the bacterial content of the cream will be low, and it will be less likely to contain undesirable forms than the cream which is obtained from the shallow pans.
In separator cream the bacteria will be represented by the kinds present in the milk at time of separation. If this milk is quite old, the cream will contain large numbers of bacteria; if, however, early separation is made and the milk is clean, the bacterial content of the cream will be low.
Types of butter. Butter may be divided into two types—acid or sour-cream, and sweet-cream, depending upon whether the cream is allowed to undergo the acid fermentation or not before it is churned. In southern Europe, it is the custom to churn the cream as sweet as possible, and the resulting product possesses only the natural, or primary milk flavor. To one accustomed to butter made from sour or ripened cream, this taste is flat, and if the butter is free from salt, may remind one of grease. Sweet-cream butter has a delicate flavor when it is made from good milk, and the taste for it is rapidly acquired. In some centers, as in Paris, the market demands this type of butter quite exclusively.
If the cream is allowed to undergo the acid fermentation before churning, the butter has a much higher degree of flavor and one that differs materially in kind. Under primitive methods, it was difficult to keep the cream sweet until it could be churned. On the small farm with gravity creaming in shallow vessels and infrequent churning, the cream was certain to be sour when churned. Undoubtedly, the making of butter from sour cream came into use because of its greater convenience; people became accustomed to sour-cream butter, and at the present time it is used in the greater part of the world, and is the type made in all of the great dairy countries.
Ripening of cream. In modern dairy practice the souring of the cream is called the ripening process, and is, where the best methods are employed, largely under the control of the butter maker. The changes that go on in the ripening process are the same as have been discussed in the acid fermentation of milk. The increase in acid is accompanied by an enormous increase in the number of bacteria; the ripe cream will contain hundreds of millions of bacteria in each cubic centimeter. The effect of this germ life is to improve or injure the butter, depending upon the class of bacteria to which it belongs. The problem of the modern butter maker is to control the kinds of bacteria growing in the cream.
The temperature at which cream is held during the ripening process is favorable to the growth of the acid-forming bacteria; hence, in ripe cream, they are practically the only kind of bacteria to be found. It must be remembered however, that there are different classes of acid-forming organisms, some of which produce desirable flavors, while others are distinctly harmful.
The intensity of flavor of butter is, in a general way, directly related to the amount of acid that is formed in the cream. A low acidity at time of churning is usually associated with a mild flavor, while a higher degree of acidity, up to a certain point, imparts a more pronounced flavor to the product. If cream is over-ripened, the quality of the flavor is seriously impaired.
In determining the acidity of cream, a definite volume is taken, and the acidity determined by titration, expressing the results as such a per cent of lactic acid. Manifestly, the amount of fat in the cream influences the apparent per cent of acidity. The acidity will not usually exceed 0.5 to 0.7 per cent, but in reality the serum will contain more than this, as the acid is formed in the serum, the butter fat having no role whatever. In a very rich cream, 40 to 50 per cent fat, it is impossible to develop more than 0.4 to 0.5 per cent of acidity, and the flavor of the butter will be low, because of the relation between the amount of acid and fat, while in a thin cream having the same acidity, the ratio between the amounts of fat and acid will be very different. For example, in one hundred pounds of 50 per cent cream of 0.5 per cent acidity there will be one-half pound of acid and fifty pounds of fat; in the same quantity of cream containing 20 per cent of fat and having an acidity of 0.5 per cent there will be one-half pound of acid to twenty pounds of fat. The flavor of the butter from the rich cream will be quite different in intensity from that made from the thinner cream.
The acidity of cream cannot be determined with any degree of accuracy by the taste or odor. Every butter maker should have some method of determining the degree of acidity in his cream, so that he may better control[Pg 140] the flavor of his product. Several methods have been devised for this purpose and the necessary apparatus is sold by all dairy supply houses.
The effect of the ripening of the cream is shown not only in the flavor of the product, but in a number of other ways. Sour cream churns more easily, and more exhaustively than does sweet cream. It is supposed that the fat globules are surrounded by a film of albuminous material which prevents their coalescing readily. During the ripening process, the action of the acid apparently dissolves this enveloping substance, and the globules cohere more easily in the churning process.
When raw cream is used the ripened-cream butter keeps better than that made from sweet cream. In sweet cream there are few lactic bacteria, the majority of the bacteria present being of various kinds, many of which may be injurious, so far as the keeping quality is concerned. In sour-cream butter the lactic bacteria make up over 99 per cent of the bacteria present, and their presence tends to prevent the development of undesirable non-acid forms.
Source of butter flavor. The flavor of ripened-cream butter has been shown to be directly connected with the acid-fermentation of the cream. The amount of lactic acid formed from the sugar fermented is dependent upon the kind of bacteria present. The acid-producing organisms that are desirable from the standpoint of the butter maker form comparatively small amounts of other by-products, but these undoubtedly affect the flavor of the butter. As fats have the power of absorbing odors, the butter fat absorbs some of the by-products of the acid fermentation, thus acquiring a certain aroma and flavor.
It is not necessary that the cream be ripened, in order to have the fat acquire a flavor, for if sweet cream is churned with a considerable proportion of sour milk, the butter will have much the same flavor, both as to intensity and kind, as though the cream had been allowed to sour naturally. A process of butter making known as the LeClair method is based on this principle. The flavor-producing substances can also be absorbed by the butter after it is churned, by working the butter in contact with sour milk. Attempts have been made to add pure lactic acid to the cream, instead of allowing the acid to be formed by the bacteria, but while the physical effect on the cream is the same, the flavor and aroma of the butter are deficient, because the acid itself does not supply the necessary aromatic products. This emphasizes the importance of the by-products of the acid fermentation other than the lactic-acid.
In the past numerous attempts have been made to find organisms that might be added to the cream, in order to produce the delicate flavor characteristic of the best type of butter. Some bacteriologists have claimed that the source of the flavor-giving substance was to be found in the decomposition products of the nitrogenous constituents of the milk. None of these attempts have stood the test of practical use in creameries, and it has been demonstrated that the finest type of butter can be made by the use of lactic bacteria alone. Formerly, when butter was made wholly from cream soured under natural conditions, a much higher degree of flavor was developed. Under present market demands, a less pronounced flavor is desired, a condition more readily met by the use of modern methods.
Importance of butter flavor. The importance of flavor in determining the commercial value of butter is evidenced by the relatively high value placed upon this factor in scoring, viz., flavor, 45 points; body or texture, 25 points; color 15; salt 10; and package 5 points. The factors on which butter is judged, are with the exception of flavor, wholly under the control of the maker, but as the production of flavor is dependent on the kind of bacteria present in the cream, it is a far more difficult matter to control, and yet it is of the utmost importance in determining the value of the product.
The flavor of the butter is dependent on the quality of the cream. If this is dirty and sour, the maker has little control over the type of fermentation, and hence, little control of the flavor of the butter. This has led in some cases to the grading of the cream, basing the division on the acidity, flavor, and fat content. Such practice is entirely justifiable, as a better quality of butter can be made from fresh, sweet cream than from that already fermented. It is noteworthy that the quality of butter has not improved since the introduction of the centralizer system, in which cream is shipped for long distances.
Control of the type of fermentation. In the older methods of butter making, there was little or no control of the type of fermentation that took place in the cream. Where milk is produced under clean conditions, and kept at ordinary temperatures, it will generally undergo fermentation changes, due to the desirable type of acid-forming organisms. In milk, which is less carefully handled, the undesirable bacteria are more abundant and the quality of the butter of lower grade. When butter was made on the farm, before the development of the factory system, it was not a question of vital importance[Pg 143] whether the product was uniform from day to day, but with the advent of the modern creamery, turning out thousands of pounds of butter per day, and with the extension of the markets for the product, the question of uniformity came to be of much importance. A uniform product can be secured only by the control of the type of fermentation in the cream, or by the control of the kinds of bacteria that cause the souring of the cream. Modern methods of butter making have been devised on the basis of an improvement in the ripening process.
Starters. From the earliest practice of allowing the cream to stand until sufficient quantity had accumulated for churning, it was only a step, but a most important one, to the addition of sour milk, sour cream, or butter milk, to hasten the ripening process. This was the beginning of the modern starter. Experience demonstrated that the addition of these already fermented liquids exercised a desirable effect upon the production of butter flavor, even though, at that time, the phenomenon of milk fermentation was not satisfactorily understood, and the relation of bacterial by-products to the production of flavor in butter was not recognized.
As a result of experience alone, improvements in the development of the "home made" starter took place. By careful selection of clean milk, and the natural fermentation of this under carefully controlled conditions, as well as the control of the temperature of the cream during the ripening, improvement in the technique of cream ripening gradually developed. More and more attention was given to the preparation of the starter, and its propagation from day to day, under conditions which would prevent its deterioration. This method of utilizing naturally fermented milk or cream was gradually [Pg 144]extended, until it became almost universal in the larger butter-producing districts.
In 1890 a more refined and scientific process was introduced by the Danish bacteriologist, Storch. Recognizing the fact that butter flavor was attributable to the development of the bacteria present in the ripening cream, he conceived the idea of isolating the various types of organisms found in milk and testing them as to their effect on the quality of flavor. Selection was then made of the most favorable flavor-producing types, and these were propagated in suitable culture media, such as skim milk, which was rendered more or less perfectly sterile by pasteurization or sterilization. Under such conditions the addition of a selected ferment could be made to the fresh cream, and so control the type of fermentation which occurred therein. An essential requisite in any organism used for this purpose must be the ability to produce relatively large amounts of acid rapidly at ordinary ripening temperatures, and also to form sufficient quantities of the proper flavor-producing substances to impart a suitable flavor to the butter fat. Such starters are known as pure culture or commercial starters, and are prepared in both liquid and dry form. At present they are used to a greater or less extent in all of the leading dairy districts.
Liquid starters consist of a mass of sterile nutrient medium, milk or beef broth, inoculated with the pure culture. The dry starters are made by adding liquid cultures, containing the growing bacteria, to some absorbing material, such as milk sugar, milk powder, or starch, the whole mass being dried at low temperatures, so as not to injure the bacteria. Under such conditions the bacteria, exist in a dormant state, and are protected[Pg 145] from their own by-products, to which they would be exposed if maintained in liquid cultures. The keeping quality, therefore, of dry cultures, is much better than that of liquid cultures.
By the use of the pure-culture starters, the butter maker is able to add to his cream the same kind of bacteria from day to day, and the butter will be more uniform than when the less constant home-made starter is employed. In cream to which the starter is added, there are present a greater or less number of acid-forming bacteria, depending upon the age of the cream, and upon the condition under which it was produced. These will grow during the ripening process, and the flavor of the product will be the result of the mixture of the bacteria in the cream. The maker can not, therefore, be certain that the addition of a pure culture to raw cream will effectively control the type of fermentation. This can be secured only by first destroying the existing bacteria in the cream, before the selected culture is added. Heating the cream accomplishes this; and in cream thus freed from the various kinds of bacteria, the butter maker can insure the dominance of the desirable types, contained in the pure-culture starter. If the cream can be obtained in a sweet condition, the maker through this process of pasteurization, and the use of pure cultures, secures almost perfect control over the type of fermentation that occurs in the cream, and thus exercises control over the degree and kind of flavor of the product. This most scientific type of butter making is now used by the most progressive butter makers in the leading butter-producing regions of the world.
Pasteurization of the cream also distinctly improves the keeping quality of butter, a condition doubtless due[Pg 146] to the freedom of the same from organisms other than the lactic bacteria. This is a factor of as much importance as uniformity, because under modern business conditions, the surplus production must be kept in storage, and it is essential that the quality should not deteriorate materially during this time.
Process of pasteurization for butter making. In the pasteurization of market milk, it is necessary to take into account the effect of heating on the physical and chemical properties of the milk, and the degree of heat that can be employed is limited. In pasteurizing cream for butter, there is no such limitation, and the cream may be heated to any temperature desired. In Denmark where the process of pasteurization has been used most extensively, temperatures ranging from 176° F. to 190° F. are used. The machines are of the "continuous flow" type, and the cream rather than the whole milk is treated. To prevent the spread of tuberculosis and other diseases, the Danish government requires that all cream and milk be heated to 176° F., before the skim milk or butter milk is returned to the farms.
The heating of the butter fat to high temperatures has an injurious effect on the texture of the butter, unless the cream is cooled to 50° F., for a period of at least two hours previous to churning.
Propagation of starters. As has been previously shown, the quality of butter depends on the kind of bacteria in the cream or in the starter added. The commercial starters contain lactic acid bacteria that have been selected with especial care; most of the starters now sold contain but a single kind of bacteria; hence, are often called pure-culture starters. The package purchased contains but a small quantity, and before the[Pg 147] starter can be used in the ripening of cream, it must be increased in amount. It must also be propagated from day to day so that a fresh starter shall be available daily for addition to the cream. The propagation of the starter must be done with especial reference to keeping it in good condition and in as high a state of purity as possible.
In the past the starter was propagated, by adding the contents of the bottle purchased to a small amount of milk that had been heated and cooled; this, if kept in a warm place, would be curdled in twenty-four hours, and could be used for the inoculation of a large mass of milk, that had been treated in a like manner, and which, when curdled, was added to the cream; a small amount was saved for the purpose of again inoculating a mass of milk that had been heated and cooled. Following this method it was very difficult to keep the culture from becoming contaminated with other forms of bacteria. More recently the most successful butter makers have propagated the so-called "mother starters" in small vessels, and have used the larger mass of starter for the inoculation of the cream alone.
Glass vessels are preferable for the propagation of the mother starters since they are impervious and through the transparent wall the condition of the ripened starter can be more easily determined than in a metal or earthenware vessel. An ordinary milk bottle with an inverted tumbler for a cover, to protect the starter from contamination from the air, is a most convenient vessel.
The starters may be propagated either in whole or skim milk; the former is preferable since, in most creameries, it can be more easily selected. The quality of the milk used has much to do with the quality of the starter;[Pg 148] it should be as fresh and clean as it is possible to obtain. The clean bottle should be filled half to two-thirds full, covered and heated in some manner so that the milk shall be at a temperature close to the boiling point for fifteen to twenty minutes. The heating may be done by placing the bottles in water, which is heated on a stove or by steam, or the bottles may be subjected to streaming steam. The milk is cooled quickly and the contents of the package purchased added and well mixed with the milk. In the case of the dry starters, the mixing should be done with especial care. The bottle is kept in a warm place and in twenty-four to thirty-six hours, the milk should be curdled. A second bottle must be treated as before and inoculated from the first, and the process repeated daily since the bacteria must have fresh food, if they are to be maintained in good condition.
In order to accomplish this, the maker must be able to maintain constant conditions from day to day, especially with reference to the amount of the ripened starter that is transferred to the fresh bottle of milk, and the temperature at which the bottles are kept. A spoon, arranged as shown in Fig. 31, enables one to carry a definite amount of the ripened starter to the bottle of milk to be inoculated and a constant temperature box (Fig. 32) permits of the maintenance of the same temperature from day to day. Through careful supervision of these points, and by taking care at every step to avoid the introduction of contaminating organisms, the purity of the culture can be maintained, and the bacteria kept in a healthy condition.
The starter is used because of the acid-forming bacteria it contains; it is said to be ripe and in the best condition for use at the time it contains the greatest number[Pg 149] of living bacteria. It has been found by experiment that this is at the time the milk curdles at ordinary temperature, or when the acidity is about 0.6-0.7 per cent. If the acidity is allowed to increase to 0.8 or 0.9 per cent, the number of bacteria will be less and a larger amount of the starter must be used in order to ripen a definite amount of cream in the desired time. The use of an overripe starter may also have an injurious effect on the flavor.
 Fig. 31.—Bottle for Mother Starters.
Fig. 31.—Bottle for Mother Starters.The ripened starter should be perfectly homogeneous, showing no bubbles of gas or free whey; the odor should be agreeable and the acid taste mild; on shaking, the curd should break up into a smooth, creamy liquid free from lumps. This is especially important in the starter[Pg 150] that is to be added to the cream, since otherwise the starter cannot be uniformly mixed with it and white specks of curdled casein will be noted in the butter.
 Fig. 32.—An Incubating Chamber for Starters.
Fig. 32.—An Incubating Chamber for Starters.The firmness of the curd is not so dependent on the amount of acid formed as upon other factors. If the curd shrinks to any extent and the whey is expressed, it is certain to produce a starter that will contain lumps that cannot be broken up. With a pure culture of lactic bacteria, there is little difficulty in this regard, but as[Pg 151] soon as gas-forming bacteria are introduced, trouble is likely to result.
In the propagation of starters, it is always to be remembered that the bacteria, although invisible to the eye, are living things, and unless conditions are favorable in every particular, it is impossible to keep them in a healthy condition, so that growth in the cream is rapid, producing the acid demanded for churning, and imparting to the butter the desired flavor, both as to degree and kind. No part of the daily routine of the butter maker should be performed with more care than the preparation of the starters, both the mother starters, and the larger one for addition to the cream. The latter can best be made in one of the many forms of starter cans now on the market, since by their use, the maker can heat and cool the milk with little trouble, and can maintain the starter at any desired temperature. Better starters cannot be made in them than by the use of simple and improvised apparatus, but better results can be obtained with the same expenditure of time and labor.
In the handling of the large starter, care should be used not to overripen, since the larger quantity is more likely to "whey off" than is the smaller starter. Skim milk rather than whole should be used for this. It should be selected with care and heated to 200° F. for thirty minutes. When it is impossible to secure fresh milk for starter making purposes, either condensed skim milk or milk powder may be used. The condensed milk is diluted with water until its volume is about the same as the milk before concentration; the mixture is then treated the same as fresh milk, being heated and cooled before inoculation. In the case of milk powder, one part of the powder is added to ten or twelve parts of[Pg 152] water, allowed to dissolve as far as possible, and the mixture heated and cooled. Either of these liquids will give satisfactory starters; the cost however is high, and in most places milk can be obtained more cheaply. The inoculation and the temperature should be so controlled, as to ripen the starter at the time it is to be needed. These conditions must be determined by the maker for himself. It should be remembered that the bacteria grow much more rapidly, as the temperature is increased; and hence, the amount of inoculation is dependent on the temperature at which the starter is to be kept.
When the starter is propagated under practical conditions, it sooner or later deteriorates, either in acid production, or in flavor, and a new pure culture must be procured from the manufacturer. It is impossible to give a hard and fast rule as to the length of time a starter can be kept in good condition. It will depend on how well the maker satisfies the conditions necessary for maintaining its purity and strength. The use of imperfectly sterilized milk, or dirty utensils soon contaminates it; overripening is likely to injure the flavor. One of the most frequent troubles encountered is the appearance of a slimy or ropy condition in the starter, although the acidity developed may be normal and the flavor desirable. It has been found that this condition is not necessarily due to contamination, as was considered true in the past, but rather to some change in the lactic bacteria themselves. If the propagation is continued, the slimy condition will often disappear.
Starters in "process" butter and oleomargarine. The advance which has recently been made in the science and practice of cream ripening and butter production is utilized most effectively in the treatment of cream in the[Pg 153] renovating process. Old, soured, and stale cream is reduced in acidity by the addition of lime. The cream is then pasteurized and aerated to expel the odors as much as possible. A large amount of starter is then added and the cream immediately churned. Under these conditions, the bad flavors are materially reduced in intensity, and desirable flavors absorbed by the fat from the selected starter used. It is thus possible to produce butter of good quality from cream that would at first be regarded as quite unsuitable for butter production.
In the manufacture of oleomargarine the same principle is utilized. The butter aroma and flavor is imparted to the neutral oils and tasteless fats by mixing the same with a properly prepared starter. Renovated or process butter is given a desirable flavor in the same way.
Wash water. It has been found that the purity of the water used in washing the granular butter has a marked influence on the keeping quality. If the water is from a shallow well into which surface water finds its way, it is certain to contain large numbers of those types of bacteria that are found in the soil, while if it comes from a deep well that is properly protected from surface contamination, the bacterial content of the water will be low and no injurious effect on the butter will be noted. When it is impossible to obtain pure water for washing purposes, a proper supply may be secured by sterilizing the water. The most convenient way of heating the water is by the direct injection of steam. It is necessary to use that coming directly from the boilers and not the exhaust from the engine, since the latter is likely to contain small amounts of oil that will impart to the butter an objectionable flavor. After cooling, the[Pg 154] water is ready for use. It has been shown that the cost of treating an impure water is more than covered by the increased returns from the product.
A pure and healthful water supply should be one of the essential things of every dairy, creamery, and cheese factory, not only for the sake of the quality of the product, but also to avoid contamination of products with disease-producing bacteria.
Bacteria in butter. The germ content of butter will depend on the type of cream. Sweet-cream butter contains but few bacteria. In sour-cream butter the content in bacteria will be greatly increased, especially as to lactic organisms. Often, it may amount to several millions of organisms per gram. The germ content of butter is said to be greater on the outside of a package than within the mass, due doubtless to the free access of air, thus favoring the growth of the aerobic forms.
The composition of normal butter does not favor the growth of the majority of kinds of bacteria that are contained in it. The washing process removes much of the material suitable as food for the bacteria, such as sugar and albumen. If considerable butter milk is left in the butter, the growth of bacteria will be quite rapid, at first, but does not continue for any considerable length of time. The addition of salt also tends to restrain the growth of most kinds of bacteria.
Butter is at its best when it is perfectly fresh. Deterioration begins within a short time and the rapidity with which the changes go on is dependent on the temperature at which the butter is stored. The temperature of the butter rooms in the large cold storage plants is kept below 0° F. The butter in such rooms will deteriorate very slowly, but on removal from the cold[Pg 155] rooms and in storage at ordinary temperatures deterioration goes on more rapidly than would have been the case when the butter was fresh. At the temperature of an ordinary refrigerator the changes go on much more rapidly. This fact has often been looked on as indicating that the factors causing the changes are biological ones. The influence of temperature in accelerating the changes would be the same if no biological factor were active.
That biological factors are of importance is indicated by the fact that the keeping quality of the product is profoundly affected by the quality of the cream. Butter made from sweet, fresh cream, that has been thoroughly pasteurized, has the best keeping quality, while butter made from such cream, but not pasteurized, has the poorest keeping quality, especially when no salt is added. Every process by which the desirable lactic bacteria are increased in proportion to other kinds has a marked effect in enhancing the keeping quality of the butter. Thus, the use of pure cultures in raw cream, and pasteurization together with the pure cultures, have a marked beneficial effect.
The addition of preservatives exerts an effect on keeping quality. Borax is the chemical most frequently employed for this purpose. Its use is allowed in Australia and New Zealand in butter that is shipped to England, but the use of all preservatives is forbidden in the United States.
The size of the package also has an effect on the keeping quality; the smaller the package, the greater is the surface exposed to the air and the more rapidly the butter deteriorates. Butter used in the United States Navy is packed in hermetically sealed cans so as to exclude the air as far as possible.
From the fact that any condition which restrains or inhibits the growth of micro-organisms has a tendency to improve the keeping quality of butter, it would appear that the detrimental changes in the quality of butter are due to biological causes. The most common defect known is that usually referred to as rancidity. There are, however, different types of changes that are probably included under this head and it is very probable that different causes are operative in their production. True rancidity is probably due to biological causes; the so-called tallowy change, in which the butter acquires the odor of tallow is probably due to the combined action of light and air on the fat.
Bacterial defects in butter. There are a number of defects in butter that are positively known to be due to the growth of bacteria in the milk or cream, or in the butter itself. The lack of flavor is looked upon as a defect in the case of ripened-cream butter. It may be due to insufficient ripening of the cream, or to the lack of acid-forming bacteria that produce the desirable flavor-forming compounds. Not all acid-forming bacteria are able to produce favorable, flavor-giving compounds; hence, sour cream butter may sometimes be deficient in flavor by reason of this fact.
Putrid butter. This specific butter trouble has been observed in Denmark, where it was first studied by Jensen. Butter affected by it rapidly acquires a peculiar putrid odor that ruins it for table use. Sometimes this flavor may be developed in the cream previous to churning. It may be caused by a number of bacteria.
Turnip flavored butter. Butter sometimes acquires a flavor resembling turnips. This trouble may be due to the feeding of such roots, the aromatic substances peculiar[Pg 157] to them being absorbed directly by the milk and thus transferred to the butter. Weigmann traced a similar flavor to certain bacteria that entered the milk from barn filth.
Cowy odor in butter. There is sometimes to be noted an odor in butter as in milk that resembles that of the cow stable. Usually this defect has been ascribed to the absorption of these odors directly by the milk. Organisms have also been described that impart to the butter a very similar odor. Bitter butter may be due to the feed that is consumed by the cow, or it may be due to those forms of bacteria that produce a bitter fermentation of the milk.
Other abnormal flavors. Among the numerous abnormal flavors that have been noted in butter is one of quite frequent appearance, the so called "fishy" flavor. It is now believed by many that this flavor is due to the presence of small amounts of iron or copper salts that have been introduced into the milk from utensils from which the protective coating of tin has been worn. If the milk or cream stored in such utensils develops any marked degree of acidity, the acid will dissolve a small amount of the iron or copper. The fishy flavor has not been found in sweet-cream butter as would be expected from the above explanation. In fresh butter a metallic taste is sometimes present. It is believed by some that on storage this flavor changes to the fishy flavor.
All utensils used for the storage of milk and cream should be kept in good condition so as to prevent the acid milk or cream from coming in contact with iron or copper.
 Fig. 33.—Moldy Butter.
Fig. 33.—Moldy Butter.Moldy butter. A defect that causes a great amount of loss is the development of mold on the surface of the[Pg 158] butter, either in tubs or in prints. This trouble is easily prevented. Butter is not well suited to the growth of mold, but the paper used for lining the tubs, or wrapping the prints is an excellent medium for mold growth. The wood of the tub also furnishes ample food for this type of life, especially where the wood contains any sap. One other essential condition for mold growth is a supply of oxygen. The mold spores are widely disseminated, and are always to be found on the butter tubs and on the paper. The number is not likely to be sufficient to cause trouble unless the tubs and paper have been kept under such conditions, as to allow growth to take place on them before use. During damp, hot weather, the amount of moisture absorbed by these materials is often sufficient to allow molds to grow on them. This trouble can be prevented by the storage of tubs and paper in a clean dry place, or by a disinfecting treatment which will destroy the mold spores. The most successful[Pg 159] method of treatment of tubs is to apply paraffin to the inner surface, which can be easily done by the use of some one of the various machines now on the market.[Pg 160] The thin layer of paraffin excludes the moisture from the wood, and also prevents the mold from obtaining a supply of oxygen for its growth. The tubs may be steamed, treated with hot water, or filled with a dilute solution of formaldehyde, and allowed to stand overnight. Soaking in brine as is usually done in the creameries is of some effect, but will not completely kill mold spores.
 Fig. 34.—Moldy Butter.
Fig. 34.—Moldy Butter.Butter may mold where the tubs have been thoroughly treated, because of the mold spores on the paper used for the lining. One of the black molds is able to thrive on parchment paper whenever the air is damp. In the past but little attention has been paid to the paper as a source of trouble. It is certain that it is often at fault, and that as much attention should be paid to the paper as to the tub. A most efficient way of treating paper, either for tub liners or print wrappers is to place same in boiling water for a few minutes.
BACTERIA AND CHEESE MAKING.
Butter, such as that of the sweet-cream type that is highly esteemed in many parts of the world, may be made without the aid of bacteria, but no important kind of cheese can be made under commercial conditions without them.
Types of cheese. Cheese consists of the fat and the precipitated casein of milk, together with a large amount of water and the salts found in milk. The numerous types of cheese may be divided into two groups, depending on the manner in which the curdling of the milk is brought about. Sour-milk cheese is made from curd, formed as a result of the acid fermentation of the milk. Thus, at the very first stage in the making of this type, the importance of bacteria is apparent.
The second type is that made from curd, which is precipitated by the addition of rennet to the milk. This type may also be divided into two groups, depending upon their texture; the hard cheese, and the soft cheese. The ordinary cheddar, the common American type, is the most important example of the hard cheese; Limburger, of the soft cheese. Cheese are designated as hard or soft, depending upon the amount of whey that is retained in them during the making process. The moisture content has an important influence on the type and amount of life that develops on and in the curd mass, and as will be seen, the ripening and flavor of the cheese are dependent upon these biological factors.
The two groups of hard and soft cheese have no sharply defined limits, but merge into each other. The[Pg 162] extreme types of the hard cheese are so dry and firm that they can be cut only with difficulty. Such cheese are used primarily as condiments to impart a flavor to certain dishes, as macaroni, and for this purpose are grated. The extreme type of soft cheese is a soft, pasty mass and can be easily spread with a knife.
Hard cheese, because the ripening process goes on uniformly throughout the entire mass of cheese, may be made of any size which permits of commercial handling. They can also be kept for long periods and preserve their good qualities. Soft cheese are made in small sizes, since on account of their consistency, they could not otherwise be handled, and also because of the manner of ripening. The ripening is due to the action of organisms developing on the surface, the by-products of which diffuse into the curd. If the cheese are too large, the outer layers become overripe, while the interior remains more or less unchanged, or insufficiently changed. Soft cheese mature much more rapidly than hard cheese; consequently they are short lived.
Although made from the same substance, milk, it is noteworthy that there are over four hundred varieties of cheese produced. Most of these find only a local market where made. Less than a dozen varieties are to be regarded as general articles of commerce.
Quality of milk. In the making of butter there are a number of processes that the maker can use when he finds himself obliged to utilize poor milk. The milk can be pasteurized and the harmful bacteria thus destroyed; desirable kinds can then be added in the form of a pure-culture starter. Pasteurization also drives off some of the volatile by-products of the first acid fermentation. By the use of these means, the maker can prepare a very good product from poor material.
In the making of most kinds of cheese, especially those of the greatest commercial importance, the cheese maker can call to his help no such aids, but must use the milk as it is brought to him. It is possible to prepare certain kinds of soft cheese from pasteurized milk that differ in no essential point from the same cheese made from raw milk. Hard cheese are also made from pasteurized milk, but in most cases such cheese differ, especially in the degree of flavor, from that made from unheated milk. It is quite probable that, as the factors concerned in the ripening of cheese become better known, methods will be evolved for the successful production of many kinds of cheese from pasteurized milk.
It has been shown that the quality of milk is almost wholly dependent upon the number and kinds of bacteria it contains. These bacteria pass into the cheese, and there produce the same products as they would have done in the milk itself. In butter making, practically all processes are under the control of the maker, until the product is ready for the market; but cheese, on the other hand, passes through a complicated series of changes after it has left the maker's control. During the manipulation of the milk and the curd in the vat, he can exert some influence on the quality of the product, but he is much more dependent on the quality of the milk than is the case in butter making.
Every effort should therefore be made to furnish to the cheese maker the quality of milk from which he can prepare fine cheese. In other words, the milk should be produced under clean conditions and carefully cooled and handled until delivered to the maker. Poor milk from a single farm may have such an effect upon the cheese made from the milk of twenty farms as to depreciate[Pg 164] the selling value of the entire product several cents per pound.
The tests that have been previously described (p. 105) have been devised especially for testing the quality of the milk for cheese making purposes, and are of the greatest service to the maker in tracing the source of poor milk.
Cheddar cheese. The first step in the making of cheddar cheese is the "ripening" of the milk, or the development of a small amount of acid. In this fermentation, the development of acid is preceded by an enormous increase in the number of acid-forming bacteria. Milk for cheese making should show an acidity of about 0.2 per cent or slightly more than in fresh milk. In other words, the maker wishes the milk to be in such condition, bacteriologically, that if kept at a temperature favorable for the growth of the acid-forming bacteria, the acidity will increase rapidly.
The curdling of the milk to precipitate the cheese solids is produced by the addition of rennet, which is obtained by extracting the fourth stomach of the young calf with a solution of common salt. In the past the maker prepared his own rennet solution from the dried stomachs ("rennets"), but at present, the extract is prepared commercially, in a much more uniform manner. The rapidity of the curdling is dependent upon the acidity of the milk. In order to secure proper rennet action, a slight increase of acid over that found in fresh milk is usually necessary; thus at the very beginning of the process of making cheddar cheese, the bacteria are of importance.
As the milk curdles, the bacteria are enclosed in the curd as are the fat globules. The curd is cut into small[Pg 165] fragments by means of a curd knife, and as the mass is warmed, the acid develops, causing the curd particles to shrink, thus expressing the whey. Within a short time, the volume of the curd is not more than one-eighth that of the milk, but in the curd are held over 75 per cent of the bacteria of the milk. To secure rapid curdling in the vat, the milk is warmed to 85° to 90° F., a temperature that is most favorable for the growth of the lactic bacteria. Since there is a large number of bacteria concentrated in a small volume, and the temperature, as well as all other conditions, is favorable to growth, multiplication of the bacteria goes on rapidly, and as a consequence, acid is formed in large amounts, as is shown by the following figures given by Publow for the manufacture of the export type of cheddar cheese:
| Acidity of milk before adding rennet | .2 to .21 | per cent |
| Acidity of whey before heating curd | .14 to .145 | " |
| Acidity of whey before removing from curd | .16 to .18 | " |
| Acidity of whey coming from the curd after removal of whey and curd is packed | .24 to .30 | " |
| Acidity of whey coming from curd before milling | .65 to .75 | " |
| Acidity of whey coming from curd before salting | .90 to 1.10 | " |
If the milk had been kept at the same temperature as the curd, the acidity would have increased much more slowly since the acid would have been distributed through a larger volume. In the cheese curd the same amount of acid is probably formed, as would have been produced in the total amount of milk during the same interval.
The acid produced by this bacterial activity has a most marked effect on the curd. At first the curd masses are[Pg 166] tough and firm, the particles showing no tendency to adhere to each other. As the acid increases in amount, the curd becomes plastic, the outer surface of the particles adhering or "matting," as the maker expresses it. The result is a solid coalescent mass of curd, which is cut into small pieces, i.e., "milled," before it is put to press. The acid allows the blending of the pieces under the influence of the pressure so that a cheese is one single mass. Under certain abnormal conditions, the development of acid may be interfered with and the particles of curd fail to mat, in which case, the cheese will be crumbly when it is cut. The determination of the proper time for pressing is made by the application of what is known as the hot iron test. This is made by determining the length of the "strings" or "threads" which can be drawn from a mass of curd when it is brought in contact with a hot iron at a cherry red heat, the length of the curd threads being a measure of the amount of acid that has been formed in the curd.
The rate of acid formation within the curd particles is also measured by determining the acidity of the whey as it comes from the curd at different stages in the making. This test, which is often used in place of the "hot iron" test is carried out in the same manner, as in determining the acidity of milk or cream. The quality of the cheese, both as to texture and flavor, is dependent to a great degree upon the amount of acid that is formed during the various stages in making; hence, the successful maker must follow closely by some means the acid formation in the curd until it is put to press.
It is very necessary that the milk shall contain a sufficient number of acid-forming bacteria to produce the required amount of acid. If a sufficient number of bacteria are not present in the milk as it is received, as is[Pg 167] the case with very sweet milk, they must be added by the maker in the form of a starter, or the process of making will be much prolonged.
 Fig. 35.—Bacteria in Cheese.
Fig. 35.—Bacteria in Cheese.Starters in cheese making. The starters used in cheese making, are identical with those employed in butter making and the same precautions should be observed in their propagation. It is important that the starters should not be such as to form a hard curd that cannot be mixed uniformly with the milk, since the curd particles would appear as white specks in the cheese. The starter should be added to the milk through a hair sieve, and well mixed with the milk, so as to distribute the bacteria uniformly. Amounts varying from 0.5 to 2 per cent are used. In butter making, it is essential [Pg 168]that the bacteria of the starter be able to form not only acid, but sufficient flavor-forming substances to impart to the butter a desirable flavor. In cheese making it is not probable that this latter characteristic is of any particular importance.
 Fig. 36.—Bacteria in Cheese.
Fig. 36.—Bacteria in Cheese.It is desirable that the process of cheese making shall conform as closely as possible to that which experience has shown to give the best results. The rate at which acid is developed in the curd and the rapidity with which the whey is expelled therefrom should bear a certain ratio to each other. If the milk has too high a degree of acidity, i.e., is overripe, the acidity developed in the curd will be too high before the curd is sufficiently firm; with a very sweet milk, the reverse may be true.[Pg 169] It is desirable for the cheesemaker to obtain as good an idea as possible of the condition of the milk with reference to its bacterial content, since this will determine the rate at which acid will be formed in the curd. If the milk is too sweet, i.e., too low in acid-forming bacteria, a starter should be added. The only methods by which this information can be obtained by the maker is by determining the acidity by the usual method or better by the use of the rennet test by which is ascertained the time required for a given amount of rennet to curdle a definite quantity of milk at a standard temperature. The varying factor in the test will be the acidity of the milk. Very slight differences influence profoundly the time of curdling. If, working under standard conditions, it is found that the time of curdling of one sample is 10 seconds and of another sample, 20 seconds, it is proof that the acidity of the first is higher than that of the second, that its bacterial content is greater and that acidity will develop in the curd more rapidly. The first may need a small amount of starter, the second a larger quantity. Working with milk from the same source, the maker, from his experience, will know how much starter should be added to milk that has given a certain result with the rennet test in order that the acid shall be developed in the curd at a desired rate.
Ripening of cheese. The curd at the time it is put to press is tough and rubbery, and has none of the characteristic flavor of cheddar cheese; it is also quite insoluble and indigestible. Before the cheese is fit to eat it must pass through a complex series of changes which are collectively known as ripening. In these changes there is not only a breaking down of the casein into soluble compounds, which process makes the cheese soft[Pg 170] and plastic under pressure, but the characteristic flavor is developed in greater or less degree. A very considerable part of the cheese thus becomes soluble in water, and it is much more easily digested than in an unripened condition.
The different factors that are operative in the ripening changes are not yet fully known, but in recent years as a result of scientific study, material progress in the study of the changes has been made.
Rennet. The commercial rennet extract when in condition for use contains very few bacteria. A preservative, boric acid, is added by the manufacturer to restrain the bacteria, otherwise the extract would soon be unfit for use. The bacteria in the commercial rennet extract are too few to be of any importance whatever in the ripening process.
Rennet extract contains an enzyme, rennin, that causes the milk to curdle; also another enzyme, pepsin, that exerts a digestive action on the curdled casein. Pepsin is always found in the stomach juices of all animals, but no digestive action takes place, unless the reaction is distinctly acid, as is the ease under normal conditions, since hydrochloric acid is excreted by the walls of the stomach. Outside of the stomach, the same conditions must obtain with reference to the presence of acid, if pepsin is to exert a digestive effect. In the cheese curd, the milk sugar is rapidly changed into lactic acid by the action of the bacteria. This gives the proper chemical reaction for peptic action, and the enzyme is then able to act on the paracasein, the nitrogenous part of the cheese. If milk contains no acid-forming bacteria, conditions will not permit of peptic action, and as a consequence, the ripening processes do not take place.[Pg 171] If the sugar is fermented by some organism that does not form acid, as the lactose-fermenting yeasts, the cheese does not ripen. The lactic bacteria are therefore an essential factor in inaugurating the ripening changes in all types of rennet cheese.
Preservative action of acid. In a previous chapter it was shown that raw milk does not undergo putrefaction because of the restraining effect of the acid formed by the lactic bacteria on the putrefactive organisms. This same phenomenon is noted in cheese. Milk always contains putrefactive bacteria which pass into the cheese, but they cannot grow therein because of the high acidity. In the absence of the acid-forming organisms in the cheese, the cheese may remain tough and rubbery, on account of the lack of suitable conditions for the action of the pepsin of the rennet extract, or when the milk contains large numbers of digesting organisms, the cheese may develop a putrefactive condition, as noted by the offensive odor and soft pasty texture.
Other factors concerned in cheese ripening. There are other factors that are also concerned in the complex series of ripening changes noted in cheddar cheese. All animal fluids and tissues, if kept under perfectly sterile conditions at ordinary temperatures, will undergo a certain amount of decomposition, due apparently to their content in enzymes that have a digestive action. Meat kept in storage becomes more tender due to the softening of the connective tissue. Milk, derived as it is from actively secreting cell tissue, gives certain reactions that are common to living material. If chloroform, which restrains the action of bacteria, but does not prevent the activity of enzymes, is added to it, it will curdle in the course of a few weeks and will become partially digested.[Pg 172] This digesting ferment found in milk is known as galactase. Compounds are formed in milk thus preserved that are similar to those found in a ripe cheddar cheese. Many experiments have been made with pasteurized milk, but it has not been possible to produce typical, normal cheese from thoroughly pasteurized milk. Such cheese are markedly deficient in the typical flavor of cheddar cheese. From this fact it is believed that the inherent enzymes of milk are a factor of some importance in the ripening of this type of cheese at least, if not of all types.
In the past, other factors have been thought to be of importance. Duclaux, a French bacteriologist, considered that the enzymes formed by the digesting bacteria are responsible for the ripening. It is now known that they can have but little if any part in the process, since they are not present in all cheese in sufficient numbers to have any marked effect, and since the acidity of the cheese mass will not permit of their development.
Other types of bacteria have been considered by bacteriologists to be of importance in the ripening process, but it is certain that the purely digestive change in the mass of the cheese can be accounted for through the action of the factors already noted.
Flavor production. The flavor of any type of cheese is the most important characteristic, just as it is in butter, for it is largely the flavor that determines the selling value of the product, and is the most difficult thing to control. It has been thought that the flavor-producing substances were derived from the paracasein of the curd and were produced by the factors that are concerned in the digestion of the paracasein. It has been shown that a cheese may be thoroughly ripened as far as its physical properties are concerned; that it may contain the end[Pg 173] products of casein digestion, and yet be low in flavor. From recent researches it seems probable that the production of flavor is connected with the change that the sugar undergoes in the acid fermentation, as volatile acids, acetic, formic, etc., as well as alcohols and esters are formed in increasing amounts as the ripening progresses. These may have come from the decomposition of the milk sugar, or from a secondary change in the products of the lactic fermentation. There are organisms in both milk and cheese that do not grow on the ordinary culture media used by the bacteriologist, and it may well be that some of these are of importance in flavor production. Their destruction in pasteurization is likely to be one of the reasons for the failure of cheese made from pasteurized milk to develop typical flavor.
Effect of temperature on ripening. The temperature at which the ripening cheese is kept has been found to be of the greatest importance in determining the quality of the product. If the cheese is kept at high temperatures, the ripening proceeds rapidly; the cheese is short lived, and has a sharp, strong flavor, and generally a more or less open texture. Unless the cheese is made from the best quality of milk, it is likely to undergo undesirable fermentations when ripened at high temperatures.
Within recent years it has been found possible to ripen cheese at temperatures that were previously thought to be certain to spoil the product. Much of the cheese is now ripened at temperatures below 50° F. The ripening goes on more slowly than at higher temperatures, but the flavor of the cheese is clean and entirely devoid of the sharp undesirable tang that is so frequently noted in old cheese, and the texture is solid and meaty. Ripening at low temperatures, when the milk is[Pg 174] not of the best quality, is certain to result in a much better product than when higher temperatures are employed.
Abnormal fermentations in cheese. As has been previously shown, it is necessary to have an abundant supply of acid-forming bacteria in the milk from which cheese is to be made. If these bacteria are supplanted by other kinds, the product will be more or less abnormal either in texture or in flavor, or possibly in both. Many of these abnormal fermentations have been studied and the organisms concerned in the changes found.
If the milk is handled carelessly, it will contain many bacteria able to form acid and gas. As noted previously, these organisms form products in milk that have an offensive odor and a disagreeable taste. In cheese the gases cause the formation of holes, more or less numerous, depending on the number of the gas-forming bacteria in the milk. Where these bacteria are abundant, gas may appear while the curd is in the vat, causing it to float in the whey, when it is known as a "floater." Again, the gas may not become evident until the cheese is in the press or on the curing shelf, when it becomes apparent by the swelling or bulging of the cheese. Such cheese is termed "huffed" or "swelled." The internal pressure may be so great as to cause the cheese to crack and to force out some of the curd. The presence of gas holes is indicative of a poor cheese, because the formation of gas is always accompanied by the presence of other undesirable compounds.
Pure culture starters are often used to overcome gassy fermentations. In cheese a certain amount of acid can be produced by the acid-forming bacteria. When the pure lactic bacteria alone are present, the cheese is very[Pg 175] likely to be of good quality. If the sugar is fermented by gas-forming organisms, the curd will be full of holes and the flavor poor, while if the sugar is fermented by a mixture of the desirable and undesirable bacteria, the quality of the product will depend on the relation of the two types. If through the addition of a pure-culture starter, the proportion of desirable bacteria is increased, the gas will be lessened in amount and the cheese improved.[Pg 176] It was formerly supposed that the lactic bacteria had an injurious effect on the gas-forming organisms. There is no good reason to believe that this is the case, but that both grow in the milk and cheese, but since only a certain amount of acid can be produced, it is important to have as much of it formed by the lactic bacteria as possible, since the amount of injurious products in the cheese will thus be limited.
 Fig. 37.—Gassy Cheese.
Fig. 37.—Gassy Cheese.The gas formed in the curd before the cheese is put to press can be gotten rid of by proper manipulation of the curd. While this treatment may improve the appearance of the cheese, it does not eliminate the substances that impart to the cheese undesirable qualities.
Gassy curds have also been treated by washing the curd with cold water. Care must be taken in applying this method for the removal of too much of the sugar and acid from the curd by the washing will permit the growth of injurious forms of bacteria. The addition of salt or of saltpeter has also been made to the milk in order to overcome gassy conditions in the milk. In the handling of gassy milk, the usual practice has been to develop a larger amount of acid before drawing the whey than in the case of good milk. This was done with the idea that acid suppressed gas formation. It has been shown previously that this is not the case. It has also been shown by Doane that the development of too much acid before drawing the whey is likely to result in undesirable flavors, producing what is known as "high-acid" or "sour" cheese.
The gas-forming bacteria grow best at high temperatures; hence, cheese kept under these conditions are more likely to be affected by this trouble than are those kept at lower temperatures.
The most successful method of preventing trouble with gassy milk in cheese making is to eliminate undesirable milk by frequent testing of the supply of the different patrons by means of the Wisconsin curd test.
Not only gas-forming bacteria may be the cause of gassy cheese, but the lactose-fermenting yeasts may cause similar trouble. If these are abundant in the milk, a considerable part of the sugar may be fermented by them, in which case, carbon dioxide gas is abundantly formed. The cheese thus rendered gassy will present the same appearance to the eye as where the gas is formed by bacteria, but will have a different flavor. The odor of alcohol may be evident, and if most of the sugar has been fermented by the yeast, the acidity of the cheese may not be sufficient for the pepsin to exert its digestive action.
Milk containing many gas-forming bacteria occurs most frequently in summer. It is claimed by some that the milk of cattle pastured on low lands is more likely to contain the gas-forming organisms than that from cattle running on higher lands. If this is true, it must be due to the bacterial content of the soil; the udders of the animals become soiled as they lie on the ground, and during the milking, the dust finds its way into the pail. Many cheese makers think that the milk from an animal suffering from a garget may be the cause of the huffing of cheese. This belief is undoubtedly well founded, as some of the bacteria known to be the cause of garget are gas-forming.
Bitter cheese. In a previous chapter the bitter fermentation of milk has been discussed. If milk containing large numbers of such organisms is made into cheese, the bitterness is very likely to be noted in it. Cheese[Pg 178] made from milk containing few or no lactic bacteria is likely to develop a bitter taste, due to the growth of the digestive bacteria that are able to grow through the lack of acid in the cheese.
If the milk contains considerable numbers of yeasts, a sweet or fruity flavor is apt to develop, due to the products of the fermentation of the sugar by the yeast. This flavor resembles that of fermented fruit, or the bouquet of certain kinds of wine.
Putrid cheese. In the absence of acid-forming bacteria, the cheese may develop a putrid or rotten odor, due to the growth of some types of putrefactive or digesting bacteria. This trouble is very infrequent in cheddar cheese, since this is made from ripened milk, but occurs more frequently in those types in which no acid is developed.
Bacteria develop in the cheese in colonies or masses, just as they do in the plate cultures of the bacteriologist, made with transparent media, such as gelatin. Cheese is opaque; therefore, the growing colonies cannot be readily discovered, but when pigment-forming bacteria grow in the cheese, their presence is likely to be noted, because of the colored spots that are formed.
Rusty spot. The "rusty spot" that has been encountered in New York and Canada is due to one of the colored bacteria which produces an orange or yellowish-red pigment. Various other pigment-forming organisms have been met in cheese, each producing its colored colony which differentiates itself from the mass of the cheese. If the pigment is produced in considerable quantities, and is soluble in any of the constituents of the cheese, the color will not appear in spots but will be more diffuse, or may impart a color to the entire mass.
Cases of acute poisoning arising from the ingestion of cheese are not infrequently reported; similar instances result from the use of ice cream. In both cases it is believed that poisonous products have been formed by bacteria, probably by some of the putrefactive forms.
From what has been said with reference to the abnormal fermentations of cheese, it will be seen that they are always due to the lack of acid-forming bacteria, or to their partial replacement by other types. In order to prevent such troubles, it is necessary to insure that the milk has been produced under clean conditions, from healthy cows, and has been handled in such a manner as to reach the maker in as sweet and fresh condition as possible. The maker can, by the use of proper starters, control the kinds of bacteria essential for the ripening process. A well trained maker should be able to prepare from such milk a uniform product of the highest quality. The effort of cheese makers at the present time is to handle milk of more or less objectionable quality so as to secure from it as good cheese as is possible. But cheese is so sensitive as to character of milk used that greater effort should be spent in securing an improved supply.
Moldy cheese. In the case of the cheddar cheese and other types of hard cheese, it is essential that their surfaces be kept clean, and not discolored by the growth of molds, which find favorable conditions for growth on the surface of the cheese in the moist atmosphere of the curing room. The molding of cheddar cheese can be prevented by covering the cheese with a layer of paraffin which stops the development of the mold spores, by shutting off the necessary supply of oxygen. For this purpose[Pg 180] the cheese are dipped in melted paraffin when a few days old.
In the case of types of cheese which are salted by applying the salt to the surface, or with soft cheese which ripen from the outside, other methods of mold prevention are employed, such as rubbing and washing the cheese. The curing room itself may be freed from the mold spores by the use of such standard disinfectants as formalin or sulphur.
Swiss cheese. One of the most important kinds of hard cheese, is the Swiss or Emmenthaler, so named, from the country and valley in which the cheese was first made. In America, this type was introduced by Swiss immigrants, and is being made in constantly increasing quantities in Ohio and Wisconsin.
Swiss cheese is a hard firm type, appearing in the markets in the form of the flat circular "drum" cheese, two to three feet in diameter, and six to eight inches thick, or in the smaller "block" form. In this country the cheese is prepared twice a day, since it is necessary to work up the milk while it is perfectly sweet. Indeed, the milk is received at the factories while it is still warm, and within five or six hours after it is drawn from the cow the cheese is on the press. If the attempt is made to prepare Swiss cheese from the kind of milk that is best suited for cheddar purposes, i.e., milk in which the acidity has increased to some extent, the flavor of the resulting product is likely to approximate a cheddar cheese rather than that of a Swiss.
In the salting process, the salt is not mixed with the curd before it is pressed, but is applied by immersing the cheese for a few days in a saturated brine, and then rubbing salt over the surface of the cheese. In this way[Pg 181] the salt gradually diffuses quite uniformly through the cheese. The method of salting has apparently a marked influence on the ripening process, since if the salt is added in the same way, and in amounts used in the cheddar process, the flavor will not be that of a Swiss cheese but will resemble a cheddar.
In cheddar cheese, the whey is expelled from the curd by means of the acid which is developed in the curd, and by heating the curd to a temperature of 95° F. to 100° F. In Swiss cheese the development of acid during the making process is prevented, because of the smaller number of acid-forming bacteria in the milk; other factors must therefore contribute to the expulsion of the whey to secure a firm curd. This is accomplished by cutting the curd into very small pieces and by briskly stirring it during the making, heating it during this process for a period of 20 to 30 minutes at 130° to 140° F. It might be thought that this high temperature, which is approximately that used in pasteurization would destroy the acid-forming bacteria, but these are apparently protected as they are within the curd. During the time the cheese is being pressed, the contained bacteria begin to grow and the whey coming from the cheese toward the end of the pressing shows a high acidity. If it does not show such a development of acid, the maker has reason to believe that the cheese may never ripen in a typical manner.
It has been mentioned that the milk contains but few acid-forming bacteria. The maker, however, attempts to insure the presence of a sufficient number by the use of "home-made" rennet. This is prepared by placing a piece of dried rennet, i.e., the stomach of the calf, in whey, keeping the same in a warm place for twenty-four[Pg 182] to thirty-six hours. As the rennet contains acid-forming organisms, these grow rapidly in the warm whey, so that by adding this sour whey to the milk, the maker is not only adding rennet, that is to curdle the milk, but also a small starter of lactic bacteria. If the rennet thus prepared contains no harmful bacteria and the milk is of good quality, the cheese is likely to ripen in a normal manner. The rennet should be prepared with due regard to bacteriological principles, a condition that is rarely met in Swiss factories in this country.
Swiss cheese has two striking characteristics, the flavor and the presence of holes or "eyes." The flavor is sweetish rather than the sharp and pungent flavor of cheddar cheese. The bacteria concerned in its production are not known, but it is certain that specific organisms play some role, since if the flora of the cheese is changed by salting the curd or by the use of milk containing large numbers of lactic bacteria, the flavor will also be changed. This role of the acid-forming bacteria in Swiss is the same as in cheddar, i.e., through the acid, conditions are established for peptic action, the curd being partially digested while at the same time the curd mass is protected from putrefactive processes.
In Swiss cheese during the ripening process, holes about the size of a large cherry develop which should be quite uniformly distributed throughout the cheese. The inner surface of the hole is glistening and, in a well-ripened cheese, a small quantity of clear brine, i.e., "tears" may be noted. These holes or "eyes" may be called the trade mark of the Swiss cheese, since without them the product has a lessened commercial value, even if it possesses the typical flavor. The "eyes" are caused by bacteria that ferment the lactic acid produced by the[Pg 183] lactic bacteria, forming from it propionic acid and carbon dioxide, the latter gas being the cause of the hole or "eye."
 Fig. 38.—Swiss Cheese.
Fig. 38.—Swiss Cheese.The "eye"-forming organisms cannot grow in the presence of any amount of salt, hence, if salt is added directly to the curd, the cheese is likely to be "blind" or free from holes. The eyes are formed not at the time gas holes are produced in a cheddar cheese, i.e., early in the ripening process, but after a lapse of three or four weeks. They are most abundant in the middle of the cheese since the manner of salting is such as to inhibit their formation near the surface. The eye-forming bacteria may have some effect on the flavor of the cheese.
The Swiss maker encounters the same troubles as does the cheddar maker. Gassy cheese is more prevalent in the Swiss than in the cheddar industry, since the maker cannot call to his aid the methods used by the cheddar maker, viz., the addition of a heavy starter, the washing of the curd, etc. It is especially important that the quality of the milk be first class in every respect, and[Pg 184] yet customs prevail in the Swiss industry that are directly inimical to the production of good milk. The grossest carelessness prevails at the factories in the matter of handling the whey. It is often kept in individual barrels for each patron. (See Fig. 8.) These are not kept thoroughly clean and the result is that the whey taken back to the farm in the cans that are used to bring the fresh milk is often in an advanced stage of fermentation.
There are many other kinds of hard cheese; but in each, so far as is known, the role of the acid-forming bacteria is identical with that noted in cheddar and Swiss cheese, viz, in preparing conditions favorable for peptic action, and preventing the development of putrefactive bacteria present in the curd.
Roquefort cheese. Among the more important foreign types of cheese that are characterized by the development of mold is Roquefort, so named from the district in France in which it is made. This cheese is made from sheep's milk, in much the same manner as cheddar. The characteristic process in its preparation is the inoculation of the curd, at the time it is put to press, with the spores of a particular kind of mold, a type closely related to the ordinary green mold of bread and cheese. The mold for inoculation is grown on bread, the whole mass being dried so that it can be powdered; then the ground-up material is sprinkled on the curd as it is placed in the press hoops. The first stage in the ripening of Roquefort is probably identical with that of the types of hard cheeses already considered, the breaking-down of the curd being due to the pepsin of the rennet used, which action is made possible by the acid formed by the bacteria.
The second stage in ripening, and one in which the characteristic flavor of the cheese is developed, is due to the growth of the mold with which the cheese is seeded. Molds can grow only in the presence of air, and in order to provide this condition, the cheese are run through a machine having a series of needle-like projections which fills the cheese with fine holes. This allows the air to penetrate the cheese and the mold to grow, the fruiting of which develops the characteristic flavor. The changes produced by the mold are not well understood, but the flavor is evidently connected with its development since in the absence of mold, it does not appear. The cheese must be cured under carefully controlled conditions, as to temperature and moisture; in France these are secured by curing the cheese in limestone caves that are highly saturated with moisture. Attempts have been made to make Roquefort cheese in other parts of the world, but they have never been successful, due undoubtedly to the fact that the proper environment and conditions for the development of the various types of organisms necessary in the ripening process have not been met. This cheese is sold for 50 to 75 cents per pound in the markets of the world.
There are two other kinds of cheese that are closely related to Roquefort, as to the manner of ripening, viz., the Gorgonzola of Italy and the Stilton of England, both of which possess their characteristic flavors by reason of the development of molds. In Stilton cheese the mold is not intentionally added, the maker relying on the contamination that comes from the factory for the usual seeding. If this does not develop, it is sometimes inoculated by exchanging plugs with a well-ripened Stilton.[Pg 186] This method is not so certain as in the inoculation of Roquefort.
Camembert cheese. A typical example of soft cheese is one of the French types, known as Camembert. This cheese is prepared from cow's milk which is curdled by rennet. The curd is not cut but is dipped into the forms, which condition, taken with the absence of pressure in forming the cheese, accounts for the large quantity of whey in it. The finished cheese are about one inch in thickness and three inches in diameter. In the ripening, the moisture and temperature of the curing room are very carefully regulated.
The first stage in the ripening is due to the rennet and the lactic bacteria. Later there appears on the surface of the moist cheese, a moldy growth. In this, there are at least two kinds of molds, the ordinary mold that appears on sour milk, Oidium lactis, and another that is related to the bread mold but which has a white instead of a green fruiting stage. These molds are confined to the surface of the cheese but the enzymes which they produce diffuse into the substance, changing the color from a dull, opaque white to a translucent yellow. The acid that has been formed by the lactic bacteria is gradually used up by the growth of the mold, and conditions then become favorable for the growth of putrefactive bacteria which digest the curd. The cheese is ready for use when the action of the mold has penetrated to the center of the cheese, and before any pronounced putrefaction has taken place. The production of the typical flavor is dependent upon there being a definite relation between the growth of the molds and bacteria. This relation is dependent largely upon the moisture and temperature of the curing room. These cannot always be[Pg 187] regulated with exactness; and hence, much of this type of cheese is not of first quality, and must be sold for a low price. While such fancy cheeses, as Camembert, bring fifty cents and upward per pound, and the yield from the milk is much greater than with the hard type of cheese, yet the difficulties of successful manufacture are such as to make success less easily attained than with the other types.
There are many other kinds of soft cheese that depend for their ripening upon factors similar to those concerned in the ripening of Camembert; most of them are, however, of small importance from a commercial standpoint.
Limburger cheese. A very famous cheese is one originally made in Germany to which the name Limburger is given. It is classed as a soft cheese although it is much firmer than Camembert. This cheese is made from cow's milk and is pressed very lightly or not at all, which condition accounts for its high per cent (50 per cent) of moisture. The surface is kept moist by repeated washing of the cheese, and by keeping the air of the curing room very moist. A yellowish, slimy, bacterial layer soon develops on the surface under these conditions. The enzymes produced by this external growth gradually diffuse to the center of the cheese, when it is regarded as ripe. The odor of the matured product is somewhat putrefactive, but is not so offensive as is usually supposed.
Definite knowledge concerning the types of organisms concerned in the surface layer is very limited. It is not certain whether the same kinds of organisms must always be present. Limburger is much easier to make than Camembert, due possibly to the fact that there are not[Pg 188] needed definite forms of life and that the balance between them is not so delicate.
A cheese known as brick is closely related to Limburger in its method of making and of ripening but is less pronounced in flavor.
In the manufacture of all of these types of cheese, troubles are likely to develop, due to an abnormal bacterial condition of the milk.
It will be seen from what has been said that the bacteria are essential factors in cheese ripening, and that the cheese industry, like the butter industry, may be called a true fermentation industry. Close co-operation must exist between the milk producer, and the maker so that the type of fermentation that goes on in the milk can be controlled. A recognition of the fundamental principles governing these fermentations, both normal as well as abnormal, is now regarded as an essential part of the training of the dairy manufacturer of today.
BACTERIA IN MARKET MILK.
Within the last decade attention has been especially directed toward the quality of milk that is furnished to the people in the cities. This has come about, in part, in connection with the demands made for better and purer food of every kind. These demands are reflected in the pure-food laws enacted by the federal government, and by the various states and municipalities. Another factor that has focused attention on the milk supplies has been the belief that it plays an important role in the production and distribution of disease, especially among children. The rapid growth of cities in all of the great countries of the world, the higher standard of living, and the greater demand for milk and other dairy products, has, of necessity, widened the zone from which the milk supply of any particular city must be drawn. Milk is now an article of export and of import; some of the great cities draw a portion of their supply from farms hundreds of miles away. This means that a longer time must elapse between the time of production and consumption, necessitating the exercise of greater care in production and handling in order to preserve the milk until it reaches the consumer.
In the past in the cities, as in the smaller towns at present, the supply was largely furnished by the producer directly to the consumer. This direct contact afforded the consumer the opportunity of informing himself of the conditions under which his milk supply was[Pg 190] produced if he desired. The advent of the middleman in the business, and the gathering of the milk from many hundreds of farms, and its redistribution to thousands of homes has made it impossible for the individual consumer to learn anything of the conditions surrounding production. When the individual cannot protect himself against fraud and unhealthful conditions, it is the duty of the government to protect him. This is the theory underlying the modern control of food supplies, water supplies, and of living conditions in general. Acting on this basis the cities are seeking to control, to an increasing degree, the healthfulness and cleanliness of the milk supply.
Formerly such control as was given was largely with reference to the composition of the milk, the regulations providing that it should contain not less than a minimum amount of fat and other solids, and be free from preservatives. The more modern regulations are much more complex and touch every phase of production and handling that can, in any way, affect the value of the milk as human food.
Municipal regulations. The different cities vary widely in the methods employed to secure a satisfactory milk supply. Rules and regulations are adopted to which the producer and dealer must conform. In order to ascertain whether the regulations are being obeyed, two types of examinations may be made: first the inspection of the farms and of the plants of the dealers; second the examination of the milk itself with reference to its chemical composition, bacterial content and temperature.
The city of New York is doing more to safeguard and to improve its milk supply than any other large city in[Pg 191] this country. A brief summary of its regulations and methods follow. A copy of the rules is furnished to each dairyman and is supposed to be posted in the stable.
The Cows.
1. The cows must be kept clean, and manure must not be permitted to collect upon the tail, sides, udder and belly of any milch cow.
2. The cows should be groomed daily, and all collections of manure, mud or other filth must not be allowed to remain upon their flanks, udders or bellies during milking.
3. The clipping of long hairs from the udder and flanks of the cows is of assistance in preventing the collection of filth which may drop into the milk. The hair on the tails should be cut, so that the brush will be well above the ground.
4. The udders and teats of the cow should be thoroughly cleaned before milking; this to be done by thorough brushing and the use of a cloth and warm water.
5. To prevent the cows from lying down and getting dirty between cleaning and milking, a throat latch of rope or chain should be fastened across the stanchions under the cow's neck.
6. Only feed which is of good quality and only grain and coarse fodders which are free from dirt and mould should be used. Distillery waste or any substance in a state of fermentation or putrefaction must not be fed.
7. Cows which are not in good flesh and condition should be immediately removed and their milk kept separate until their health has been passed upon by a veterinarian.
8. An examination by a veterinary surgeon should be made at least once a year.
The Stable
9. No stagnant[Pg 192] water, hog-pen, privy or uncovered cesspool or manure pit should be maintained within 100 feet of the cow stable.
10. The cow stable should be provided with some adequate means of ventilation, either by the construction of sufficient air chutes extending from the room in which the cows are kept to the outside air, or by the installation of muslin stretched over the window openings.
11. Windows should be installed in the cow barn to provide sufficient light (2 sq. feet of window light to each 600 cubic feet of air space the minimum) and the window panes be washed and kept clean.
12. There should be at least 600 cubic feet of air space for each cow.
13. Milch Cows should be kept in a place which is used for no other purpose.
14. Stable floors should be made water-tight, be properly graded and well drained, and be of some non-absorbent material. Cement or brick floors are the best, as they can be more easily kept clean than those of wood or earth.
15. The feeding troughs and platforms should be well lighted and kept clean at all times.
16. The ceiling should be thoroughly swept down and kept free from hanging straw, dirt and cobwebs.
17. The ceiling must be so constructed that dust and dirt therefrom shall not readily fall to the floor or into the milk. If the space over the cows is used for storage of hay, the ceiling should be made tight to prevent chaff and dust from falling through.
18. The walls and ledges should be thoroughly swept down and kept free from dust, dirt, manure or cobwebs,[Pg 193] and the floors and premises be kept free from dirt, rubbish and decaying animal or vegetable matter at all times.
19. The cow beds should be so graded and kept that they will be clean and sanitary at all times.
20. Stables should be whitewashed at least twice a year unless the walls are painted or are of smooth cement.
21. Manure must be removed from the stalls and gutters at least twice daily. This must not be done during milking, nor within one hour prior thereto.
22. Manure should be taken from the barn, preferably drawn to the field. When the weather is such that this cannot be done, it should be stored not nearer than 200 ft. from the stable and the manure pile should be so located that the cows cannot get at it.
23. The liquid matter should be absorbed and removed daily and at no time be allowed to overflow or saturate the ground under or around the cow barn.
24. Manure gutters should be from six to eight inches deep, and constructed of concrete, stone or some non-absorbent material.
25. The use of land plaster or lime is recommended upon the floors and gutters.
26. Only bedding which is clean, dry and absorbent should be used, preferably sawdust, shavings, dried leaves or straw. No horse manure should be used as bedding.
27. The flooring where the cows stand should be so constructed that all manure may drop into the gutter and not upon the floor itself.
28. The floor should be swept daily. This must not be done within one hour prior to milking time.
29. If individual drinking basins are used for the cows, they should be frequently drained and cleaned.
30. All live stock other than cows should be excluded from the room in which the milch cows are kept. (Calf or bull pens may be allowed in the same room if kept in the same clean and sanitary manner as the cow beds.)
31. The barnyard should be well drained and dry, and should be as much sheltered as possible from the wind and cold. Manure should not be allowed to collect therein.
32. A suitable place in some separate building should be provided for the use of the cows when sick, and separate quarters must be provided for the cows when calving.
33. There should be no direct opening from any silo or grain pit into the room in which the milch cows are kept.
The Milk House.
34. A milk house must be provided which is separated from the stable and dwelling. It should be located on elevated ground, with no hog-pen, privy or manure pile within 100 feet.
35. It must be kept clean and not used for any purpose except the handling of milk.
36. The milk house should be provided with sufficient light and ventilation, with floors properly graded and made water-tight.
37. It should be provided with adjustable sashes to furnish sufficient light and some proper method of ventilation should be installed.
38. The milk house should be provided with an ample supply of clean water for cooling the milk, and if it is not a running supply, the water should be changed twice[Pg 195] daily. Also a supply of clean ice should be provided to be used for cooling the milk to 50 degrees within two hours after milking.
39. Suitable means should be provided within the milk house, to expose the milk pails, cans and utensils to the sun or to live steam.
40. Facilities consisting of wash basins, soap and towel should be provided for the use of milkers before and during milking. During the Summer Months the Milk House should be properly screened to exclude flies.
The Milkers and Milking.
41. Any person having any communicable or infectious disease, or one caring for persons having such disease, must not be allowed to handle the milk or milk utensils.
42. The hands of the milkers must be thoroughly washed with soap and water, and carefully dried on a clean towel before milking.
43. Clean overalls and jumpers should be worn during the milking of the cows. They should be used for no other purpose, and when not in use should be kept in a clean place protected from dust.
44. The hands and teats should be kept dry during milking. The practice of moistening the hands with milk is to be condemned.
45. The milking stools should be at all times kept clean, and iron stools are recommended.
46. The first streams from each teat should be rejected, as this fore milk contains more bacteria than the rest of the milk.
47. All milk drawn from the cows 15 days before, or 5 days after parturition should be rejected.
48. The pails in which the milk is drawn should have[Pg 196] as small an opening at the top as can be used in milking; top opening preferably not to exceed 8 inches in diameter. This lessens the contamination by dust and dirt during milking.
49. The milking should be done rapidly and quietly, and the cows should be treated kindly.
50. Dry fodder should not be fed to the cows during or just before milking, as dust therefrom may fall into the milk.
51. All milk utensils, including pails, cans, strainers, and dippers, must be kept thoroughly clean and must be washed and scalded after each using, and all seams in these utensils should be cleaned, scraped and soldered flush.
The Milk.
52. Milk from diseased cows must not be shipped.
53. The milk must not be in any way adulterated.
54. The milk as soon as drawn should be removed to the milk house and immediately strained and cooled to the proper temperature.
55. All milk must be cooled to a temperature below 50 degrees F., within two hours after being drawn, and kept thereafter below that until delivered to the creamery.
56. The milk should be strained into cans which are standing in ice water which reaches the neck of the can. The more rapidly the milk is cooled, the safer it is, and longer it will keep sweet. Ice should be used in cooling milk, as very few springs are cold enough for the purpose.
57. If aerators are used, they should stand where the air is free from dust or odors, and on no account should they be used in the stable or out of doors.
58. Milk strainers should be kept clean; scalded a second time just before using, and if cloth strainers are used, several of them should be provided, in order that they may be frequently changed during the straining of the milk.
59. The use of any preservative or coloring matter is adulteration, and its use by a producer or shipper will be a sufficient cause for the exclusion of his product from the City of New York.
Water Supply.
60. The water supply used in the dairy and for washing utensils should be absolutely free from any contamination, sufficiently abundant for all purposes, and easy to access.
61. This supply should be protected against flood or surface drainage.
62. The privy should be located not nearer than 100 feet of the source of the water supply, or else be provided with a water-tight box that can be readily removed and cleaned, and so constructed that at no time will the contents overflow or saturate the surrounding ground.
63. The source of the water supply should be rendered safe against contamination by having no stable, barnyard, pile of manure or other source of contamination located within 200 feet of it.
In order that the farm inspection shall be as effective as possible, and to make the work of the several inspectors as uniform as may be, the dairies are scored. A copy of the score card follows.
DEPARTMENT OF HEALTH
The City of New York
Division of General
Sanitary Inspection
Dairy Report
Inspection No.___ Time___A. P. M. Date______191__
| Perfect | Allow | ||
| EQUIPMENT | |||
| 15 | COW STABLE is______located on elevated ground with no stagnant water, hog-pen, privy, uncovered cesspool or manure pit within 100 feet | 1 | |
| 16 | FLOORS, other than cow beds, are of concrete or some non-absorbent material | 2 | |
| 17 | Floors are______properly graded and water-tight | 2 | |
| 18 | Cow beds are______of concrete or planks laid on concrete | 2 | |
| 19 | DROPS are.....constructed of concrete, stone or some non-absorbent material | 2 | |
| 20 | Drops are......water-tight and space beneath is clean and dry | 2 | |
| 21 | CEILING is constructed of______and is tight and dust proof | 2 | |
| 22 | WINDOWS No______total square feet [Pg 199] there is______2 square feet of window light for each 600 cu. ft. air space (1 sq. ft. per each 600 cu. ft.—1) | 2 | |
| 23 | VENTILATION consists of______sq. ft. muslin in ceiling or______which is sufficient 3, fair 2, poor 1, insufficient 0 | 3 | |
| 24 | AIR SPACE is______cu. ft. per cow (600 and over—3) (500 to 600—2) (400 to 500—1) (under 400—0) | 3 | |
| 25 | LIVE STOCK, other than cows, are______excluded from rooms in which milch cows are kept | 2 | |
| 26 | There is______direct opening from stable into silo or grain pit | 1 | |
| 27 | Separate quarters are______provided for cows when calving or sick | 1 | |
| 28 | COW YARD is______properly graded and drained | 2 | |
| 29 | WATER SUPPLY for cows is______unpolluted and plentiful | 1 | |
| 30 | MILK HOUSE has______direct opening into cow barn or other building | 1 | |
| 31 | Milk house has______sufficient light and ventilation | 1 | |
| 32 | Floor is______properly graded and water-tight | 1 | |
| 33 | Milk house is______properly screened to exclude flies | 1 | |
| 34 | Milk pails are______of smoothly tinned metal in good repair | 1 | |
| 35 | MILK PAILS have______all seams soldered flush | 2 | |
| 36 | Milk pails are______of the small mouthed design, top opening not exceeding 8 inches in diameter. Diameter | 2 | |
| 37 | Racks are______provided to hold milk pails and cans when not in use | 2 | |
| 38 | Special milking suits are______provided | 1 | |
| 40 | |||
| Perfect | Allow | ||
| METHODS | |||
| 39 | STABLE INTERIOR painted or whitewashed on______which is satisfactory 3, fair 2, unsatisfactory 1, never 0 | 3 | |
| 40 | FEEDING TROUGHS, platforms or cribs are______well lighted and clean | 1 | |
| 41 | Celling is______free from hanging straw, dirt or cobwebs | 3 | |
| 42 | Window panes are______washed and kept clean | 1 | |
| 43 | WALLS AND LEDGES are______free from dirt, dust, manure or cobwebs | 2 | |
| 44 | FLOORS AND PREMISES are______free from from dirt, rubbish or decayed animal or vegetable matter | 2 | |
| 45 | COW BEDS are______clean, dry and no horse manure used thereon | 2 | |
| 46 | Manure is______removed to field daily 4, to at least 100 feet from barn 2, stored less than 100 feet or where cows can get at it 0 [Pg 200] | 4 | |
| 47 | Liquid Matter is______allowed to saturate ground under or around cow barn | 2 | |
| 48 | Milking stools are______clean | 1 | |
| 49 | Cow Yard is______clean and free from manure | 2 | |
| 50 | COWS have______been tuberculin tested and all tuberculous cows removed | 7 | |
| 51 | Cows are______all in good flesh and condition at time of inspection | 2 | |
| 52 | Cows are______all free from clinging manure and dirt. (No. dirty ____) | 4 | |
| 53 | LONG HAIRS are______kept short on belly, flanks, udder and tail | 1 | |
| 54 | UDDER AND TEATS of cows are______thoroughly brushed and wiped with a clean damp cloth before milking | 3 | |
| 55 | ALL FEED is______of good quality and distillery waste or any substance in a state of putrefaction is______fed | 2 | |
| 56 | MILKING is______done with dry hands | 2 | |
| 57 | FORE MILK or first few streams from each teat is______discarded | 2 | |
| 58 | Clothing of milkers is______clean | 1 | |
| 59 | Facilities for washing hands of milkers are______provided in cow barn or milk house | 2 | |
| 60 | Milk is strained at______and______in clean atmosphere | 1 | |
| 61 | Milk is______cooled within two hours after milking to 50 degrees F. 3, to 55 degrees F. 2 to 60 degrees F. 1 | 3 | |
| 62 | Ice is______used for cooling milk | 1 | |
| 63 | MILK HOUSE is______free from dirt, rubbish and all material not used in the handling and storage of milk | 1 | |
| 64 | Milk utensils are______rinsed with cold water immediately after using and washed clean with hot water and washing solution | 2 | |
| 65 | Utensils are______sterilized by steam or boiling water after each using | 2 | |
| 66 | Privy is______in sanitary condition, with vault and seats______covered and protected | 1 | |
| 60 | |||
Remarks
Equipment 40 per cent. Score ....per cent
Methods 60 per cent. Score ....per cent
Perfect Dairy 100 per cent. Score ....per cent
A copy of the completed report is left with the dairyman.
Before the farm inspection is carried out the creameries to which the milk is delivered by the farmers are inspected at the time the milk is being delivered. The temperature of the milk and its cleanliness are noted. In the creamery the straining, cooling and handling of the milk are observed as well as the washing of the milk cans and other utensils, and the construction and condition of the creamery, the opportunity for the water supply to become contaminated, and the presence of infectious diseases among the employees.
Grades of milk. Three grades of milk have been established. Each dealer is required to state which grade or grades he expects to handle. The specifications for the different grades are as follows.
Grade A. Guaranteed Milk. Guaranteed milk is that produced at farms holding permits therefor from the Department of Health and produced and handled in accordance with the following minimum requirements, rules and regulations:
1. Only such cows shall be admitted to the herd as have not re-acted to a diagnostic injection of tuberculin.
2. All cows shall be annually tested with tuberculin, and all re-acting animals shall be excluded from the herd.
3. No milk from re-acting animals shall be shipped to the City of New York for any purpose whatever.
4. The milk shall not contain more than 30,000 bacteria per c. c. when delivered to the consumer, or at any time prior to such delivery.
5. The milk shall be delivered to the consumer only in sealed bottles, which have been sealed at the dairy.
6. The milk shall be delivered to the consumer within 30 hours of the time at which it was drawn.
Grade A. Certified Milk. Certified milk is milk certified by a milk commission appointed by the Medical Society of the County of New York, or the Medical Society of the County of Kings, as being produced under the supervision and in conformity with the requirements of that commission as laid down for certified milk, and sold under a permit therefor issued by the Board of Health.
No milk shall be held, kept, offered for sale, or sold and delivered as certified milk in the City of New York which is produced under requirements less than those for guaranteed milk.
Grade A. Inspected Milk—Raw. Inspected milk (raw) is milk produced at farms holding permits therefor from the Board of Health, and produced and handled in accordance with the following minimum requirements, rules and regulations:
1. Only such cows shall be admitted to the herd as have not re-acted to a diagnostic injection of tuberculin.
2. All cows shall be tested annually with tuberculin, and all re-acting animals shall be excluded from the herd.
3. No milk from re-acting animals shall be shipped to the City of New York for any purpose whatsoever.
4. The farms at which the milk is produced must obtain at least 75 points in an official score of the Department of Health. These 75 points shall be made up as follows: A minimum of 25 points for equipment, and 50 points for method.
5. The milk shall not contain more than an average of[Pg 203] 60,000 bacteria per c. c. when delivered to the consumer, or at any time prior thereto.
6. Unless otherwise specified in the permit, the milk shall be delivered to the consumer only in bottles.
Grade A. Selected Milk—Pasteurized. Selected milk (pasteurized) is milk produced at farms holding permits therefor from the Board of Health, and produced and handled in accordance with the following requirements, rules and regulations:
1. The farms at which the milk is produced must obtain at least 60 points in an official score of the Department of Health. Of these 60 points, a minimum of 20 points shall be required for equipment and a minimum of 40 points for method.
2. All milk of this grade shall be pasteurized, and said pasteurization shall be carried on under a special permit issued therefor by the Board of Health, in addition to the permit for "Selected Milk (Pasteurized.)"
3. The milk shall not contain more than an average of 50,000 bacteria per c. c. when delivered to the consumer, or at any time after pasteurization and prior to such delivery.
4. Unless otherwise specified in the permit, the milk shall be delivered to the consumer only in bottles.
5. All containers in which pasteurized milk is delivered to the consumer shall be plainly labeled "Pasteurized." Labels must also bear the date and hour when pasteurization was completed, the place where pasteurization was performed, and the name of the person, firm or corporation performing the pasteurization.
6. The milk must be delivered to the consumers within 30 hours after the completion of the process of pasteurization.
7. No milk shall be pasteurized more than once.
8. No milk containing in excess of 200,000 bacteria per c. c. shall be pasteurized.
General Regulations for Grade A—
1. The caps of all bottles containing milk of Grade A shall be white, and shall contain the words "Grade A" in black letters, in large type.
2. If cans are used for the delivery of milk for Grade A, the said cans shall have affixed to them white tags, with the words "Grade A" printed thereon in black letters, in large type, together with the designation "Inspected Milk (Raw)" or "Selected Milk (Pasteurized)," as the quality of the contents may require.
Grade B. Selected Milk—Raw. Selected milk (raw) is milk produced at farms holding permits therefor from the Board of Health, and produced and handled in accordance with the following minimum requirements, rules and regulations:
1. Only such cows shall be admitted to the herd as have been physically examined by a regularly qualified veterinarian and declared by him to be healthy, and free from tuberculosis in so far as a physical examination may determine that fact.
2. The farms at which the milk is produced must obtain at least 68 points in an official score of the Department of Health. These 68 points shall be made up as follows: A minimum of 25 points for equipment, and a minimum of 43 points for method.
3. The milk shall not contain an excessive number of bacteria when delivered to the consumer, or at any time prior thereto.
Grade B. Pasteurized Milk. Pasteurized milk (Grade B) is milk produced under a permit issued therefor by[Pg 205] the Board of Health, and produced and handled in accordance with the following minimum requirements, rules and regulations and in further accordance with the special rules and regulations relating to the pasteurization of milk.
1. The milk after pasteurization must be at once cooled and placed in sterilized containers, and the containers immediately closed.
2. All containers in which pasteurized milk is delivered to the consumer shall be plainly labeled "Pasteurized". Labels must also bear the date and hour when the pasteurization was completed, the place where pasteurization was performed, and the name of the person, firm or corporation performing the pasteurization.
3. The milk must be delivered to the consumer within 36 hours after the completion of the process of pasteurization.
4. No milk shall be pasteurized more than once.
5. No milk containing an excessive number of bacteria shall be pasteurized.
General Regulations for Grade B—
1. Caps of bottles containing milk of grade B shall be white and marked "Grade B" in bright green letters of large type.
2. The necks and shoulders of cans containing grade B milk shall be painted bright green, and a metal tag shall be attached to each can with the words "Grade B" in large type, and the words of the subdivision to which the quality of the milk in said can conforms.
Grade C. Grade C is to be used for cooking and manufacturing purposes only. It includes all raw milk that does not conform to the requirements of any of the subdivisions of grade A or grade B.
1. The caps of all bottles containing milk of grade C shall be white and shall contain in red the words "Grade C" in large type and "for cooking" in plainly visible type.
2. Cans containing milk of grade C shall be painted red on necks and shoulders and shall have in red the words "Grade C" in large type and the words "for cooking" in plainly visible type affixed to each can.
All creameries handling milk of different grades will be required to demonstrate to the Department of Health that they are capable of keeping the grades separate, and must keep records satisfactory to the Department of Health concerning the amount of milk of each grade handled each day.
It is to be noted that the grades of milk are based on the bacterial content of the milk and on the opportunity for the milk to become contaminated with pathogenic organisms. From the statements made in a previous chapter it is evident that the number of bacteria in any sample of milk is dependent upon (1) the original amount of contamination, (2) the age of the milk, and (3) the temperature at which it has been held. A high bacterial content is indicative of poor milk, while a low bacterial content can be obtained, in the case of raw milk, only where due attention is paid to cleanliness and cooling. This relation between the quality of milk and its bacterial content has led many cities to adopt numerical bacterial standards, even when grades of milk have not been established. Boston requires that the milk shall not contain more than 500,000 bacteria per cubic centimeter. Rochester, N. Y., has a standard of 100,000 per cubic centimeter, while Chicago requires that the milk on arrival in the city shall not contain more than[Pg 207] 1,000,000 per cubic centimeter from May first to September thirtieth, and not over 500,000 between October first and April thirtieth. The sale of milk containing more than 3,000,000 bacteria per cubic centimeter is prohibited.
It has been urged that bacterial standards are not of value since the healthfulness of milk depends on the kind of bacteria present rather than on the number. It is well recognized that milk containing millions of acid-forming organisms, butter milk, is a healthful food, while that containing many less bacteria may contain some disease-producing organisms. It has been urged that a qualitative standard should supplant the quantitative. The consumer desires milk that has been produced under clean conditions, and which has good keeping qualities. The harmless forms of bacteria exert the greatest influence on the keeping quality. Experience has shown that the quantitative examination of the milk supply as it comes from the farm is the most feasible method of determining, in the laboratory, whether the farmer has obeyed the rules with reference to cleanliness and cooling of the milk. The bacteriological examination also gives an indication as to whether the large number of bacteria is due to gross contamination of the milk with mud and manure, or actual growth of bacteria as in old milk. In the latter case the ordinary acid-forming bacteria will usually predominate in the milk, while in the former, the number of kinds of bacteria and the proportion between the kinds will be changed. It is of course evident that the quantitative standards should be applied with judgment.
It is also claimed that the delay in securing the results in the quantitative examination of milk is an objection[Pg 208] to the bacterial standard, since the milk is consumed before the laboratory findings can be obtained. It is true that it does not protect the community as far as the particular sample is concerned, but it is also true that the examination is not made for the purpose of determining the condition of the particular sample, so much as it is to determine the methods that are employed on any particular farm, and these do not vary widely from day to day. Thus, if a number of samples give high results, it is evident that conditions surrounding production need investigation.
If the milk is well cooled on the farm, and kept cold while being shipped, the growth of bacteria will be slow, and the condition of the milk as far as keeping quality is concerned, much better than if less care is used. Some cities have temperature standards; New York requires that the milk shall be cooled to 50° F. on the farm, and shall not be above 50° F. on arrival in the city. Others require that it shall not be above 50° F. on delivery to the consumer.
Certified milk. In many cities the Medical Societies have appointed Milk Commissions, that adopt rules and regulations, concerning the production of milk that shall receive the certificate of the commission. Producers, who desire to have their milk thus certified, must satisfy the commission that they are able to conform to the rules. The commission appoints a physician to examine the personnel of the farm, a veterinarian to make frequent examinations of the herd, a chemist to examine the milk as to its contents in fat and other solids, and a bacteriologist to determine the bacterial content of the milk. The rules are very stringent and cover every point that may influence, in any way, the value of the milk as human food.[Pg 209] In order to conform to these requirements, a heavy expenditure must be incurred, and the business must pay for such expert service; hence, certified milk must be sold at high prices, twelve to twenty-five cents per quart. This price makes it a special product and its use is confined mainly to infant feeding.
The bacterial standard for certified milk is usually 10,000 bacteria per cubic centimeter. It is only by the exercise of the greatest care at every point that the bacterial content can be kept below this maximum.
The term "certified milk" has been registered by Mr. Francisco of New Jersey, who was the first to engage in the production of such milk under the direction of the Medical Milk Commission of Essex County, New Jersey. The use of the term is allowed when the milk is produced under the regulation of any Medical Milk Commission.
Most certified milk is now produced on fancy dairy farms conducted by wealthy men. The barns and other equipment are the best that can be obtained, and the methods employed, as far as cleanliness is concerned, are extreme. In some of the dairies the bacterial content is reduced to a few hundred per cubic centimeter, or to that which is derived from the interior of the udder. Such milk will, when well refrigerated, keep for long periods of time. It is a not uncommon thing for such milk to keep perfectly sweet for ten to fifteen days.
Tests for the quality of milk. At the milk depot and elsewhere, it is frequently desired to determine the bacterial condition of the milk in a less refined manner than by the plate cultures of the bacteriologist, which require a large amount of time for their preparation and do not yield any positive information for at least twenty-four hours. There are a number of such tests that may be applied.
 Fig. 39.—Sediment Testers.
Fig. 39.—Sediment Testers.1. Dirt or sediment test. This is made by filtering a pint of the mixed milk through a small disc of absorbent cotton. The insoluble dirt is retained and imparts a color to the cotton, the shade of which is dependent on the amount of dirt (P. 45). Since it is impossible to have dirt without bacteria, it is evident that milks containing[Pg 211] a large amount of dirt will be high in bacteria. The reverse, however, is not necessarily true.
 Fig. 40.—Good Milk.
Fig. 40.—Good Milk.2. Acidity test. The acidity of the milk is also an indication of its bacterial content. If the acidity has increased, above the normal for fresh milk, the bacterial content is certain to be high, and the keeping quality poor. An acidity above 0.2 per cent in market milk is to be avoided, as an increase in acidity is always preceded by a great increase of bacteria.
Whether the acidity is above or below this point can be rapidly and easily determined at the receiving station[Pg 212] by a modification of the Farrington acid test. Dissolve one alkaline tablet in an ounce of water. A unit volume of this solution added to a unit volume of milk is equal to 0.1 per cent of acidity. If two measures are provided,—one for the alkaline solution holding just twice as much as that used for the milk, the approximate acidity can be quickly determined by mixing a measure of each in a common white cup. If the acidity is above 0.2 per cent the color will remain white; if a pink color develops, it indicates an acidity less than[Pg 213] this amount. This test is also useful in the selection of milk or cream that is to be used for special purposes, such as pasteurization.
 Fig. 41.—Poor Milk.
Fig. 41.—Poor Milk.3. Alcohol test. A test giving similar information is made by adding two parts of 70 per cent alcohol to one part of milk, and noting whether curdling occurs.
4. Curd test. The curd test described on p. 100 gives no indication of the number of bacteria present, only concerning the types present. It has been proposed to combine the fermentation test with the reduction test referred to below and thus gain some idea of, not only the number, but the kinds of bacteria present.
5. Reduction test. The reduction test is made by adding to twenty cubic centimeters of milk, one-half cubic centimeter of a solution of methylene blue, a coal tar dye. A saturated solution of the dye is made in alcohol, and 2.5 per cent of this solution added to water. The time required for the reduction of the dye or the change of the color from blue to white when the samples are placed in tubes and kept at 98 to 100° F., is dependent upon the number of bacteria present. By allowing the tubes to stand until curdling occurs, and noting the nature of the curd, whether the solid curd of the desirable acid-forming bacteria or the gassy curd of the harmful types is produced, knowledge is gained of the kinds of bacteria present.
According to Barthel, milks that reduce the methylene blue within fifteen minutes contain hundreds of thousands of bacteria per cubic centimeter. Those that require from fifteen minutes to one hour for the disappearance of the color are also high in bacteria, and are to be classed as a poor grade of market milk. If one to three hours is required, the milk is comparatively low in bacteria, and is to be classed as a good grade of market[Pg 214] milk. When more than three hours elapse before the disappearance of the blue color, the bacterial content is low and the milk is to be placed in the highest grade.
The time of reduction is only a rough index of the number of bacteria present, but it gives a good idea of the keeping quality of the milk, and of the conditions of production and handling. Of the above tests the sediment and acid tests are more frequently used.
Examination of milk sediments. In the modern municipal laboratory, efforts are made to determine, as far as possible, the conditions of production on the farms, by an examination of the milk in the laboratory. The samples of milk are sedimented in a small centrifuge, and an examination of the sediment made with the microscope. The types of bacteria and the number of body cells found is an indication as to whether any of the animals of the herd are suffering from inflammation of the udder. The test also gives information similar to the dirt test since the insoluble dirt will be thrown down and will impart a color to the sediment.
Pasteurization of market milk..The spread of the pasteurizing process as applied to market milk has been rapid. This has been due to the recognition of the fact that only by this process can a safe milk i.e., one free from pathogenic bacteria, be obtained. As previously mentioned a small proportion of all human beings that have suffered from typhoid fever become bacillus carriers. It is impossible to examine all persons who may be concerned in the handling of milk in order to ascertain whether they belong to this dangerous and unfortunate class of people.
The larger cities have also recognized the impossibility of requiring the tuberculin test of all cattle furnishing[Pg 215] milk. Pasteurization remains the only safeguard, and it is probable that within a short time all the larger cities will require the pasteurization of all milk, except that produced under strict supervision.
As previously mentioned heating causes certain changes in milk. In the treatment of market milk it is desirable to use as low temperatures as will suffice to destroy the disease-producing bacteria. It is fortunate that temperatures that will insure this result have little effect on the milk. The temperatures now recommended for pasteurization are as follows:
158 degrees F. for 3 minutes.
155 degrees F. for 5 minutes.
152 degrees F. for 10 minutes.
148 degrees F. for 15 minutes.
145 degrees F. for 18 minutes.
140 degrees F. for 20 minutes.
In actual practice the milk is heated to 145 degrees for 25 to 30 minutes. The acid-forming bacteria are not completely destroyed and the pasteurized milk as a rule will undergo the same type of fermentation as raw milk. It is, however, deemed essential that all pasteurized milk be sold as such; that it be delivered to the consumer within twenty-four hours after pasteurization and that no milk be pasteurized a second time.
The continuous pasteurizing machines have the disadvantage that a small portion of the milk passes through so quickly that all pathogenic bacteria therein might not be destroyed, (p. 131). This has led to the use of the "holding" process in which the milk is heated to the desired temperature and then placed in tanks where it remains at this temperature for any desired time. Every portion is thus treated in a uniform manner.
If the milk is bottled after pasteurization, there remains opportunity for reinfection, possibly with typhoid bacilli. Pasteurization in the final container, the bottle, is being recommended. This is possible only when a special bottle is used with a metal cap lined with paper.
Milk distribution. Until within recent years in the cities and at present in smaller towns, milk is largely retailed from cans which are carried on the wagons or are kept in stores. This exposes the milk to contamination from street dust and from the container furnished by the consumer. It is well recognized that every utensil with which milk is brought in contact adds more or less bacteria to it, and the less milk is handled, the better will be its condition when it reaches the consumer. Milk is now largely retailed in glass bottles which are closed with pulp caps. In some cities the bottling is mainly done in the country at the bottling station to which the milk is brought by the farmers; or it may be shipped by the producer to a distributing company, and all subsequent treatment, as pasteurization and bottling done in the city.
Milk plants are now generally equipped for the rapid and economical handling of large quantities of milk in a most sanitary manner. The bottles as they are returned from the consumer are washed in a continuously-acting automatic washer which washes, rinses and sterilizes the bottles without their being removed from the cases in which they are carried on the wagons. These machines are effective, if not run at too rapid a rate, so that the bottles are not exposed for a sufficiently long period of time to sterilize them. The bottles are then filled and the paper caps inserted by machinery. The[Pg 217] caps can now be obtained from the manufacturers in sealed tubes in which they have been sterilized so that the contamination from this source is avoided. The shipping cans are washed and sterilized with live steam, and in many plants are thoroughly dried, by passing hot air into them. Under these conditions they then reach the farmer with none of the musty and disagreeable odor that frequently is present when the can contains a small quantity of water, condensed from steam.
The top of the milk bottle over which the milk is poured is exposed to contamination from the hands of the deliveryman. Trouble from this source can be avoided if the consumer cleans the lip of the bottle before removing the cap. The better grades of milk are dispensed in bottles, the top of which is protected by an additional cover of paper or tin foil which reaches to the neck of the bottle and is held in place by a crimped metal band.
Milk supply of the small cities. It is true that the quality of milk supplied to the large cities by the great milk companies is generally much superior to that sold in the smaller cities and villages. Many of the smaller places are however, attempting in various ways to improve their supply. It is evident that methods will be successful here that can not be employed in the larger places. A detailed and careful farm inspection by a tactful, capable inspector, coupled with proper publicity will do much to improve conditions. The publication of the scores of the different farms, and the demonstration of the sediment test as applied to their product attracts favorable attention to the good dairies and unfavorable attention to the poor. This usually has an effect[Pg 218] on the trade sufficient to cause the negligent producer and dealer to improve.
It is also becoming recognized that high grade milk can be produced with very simple equipment. In fact the small farm is often more successful in producing high grade milk than is the large farm on which the work must be done by hired help for here the personality of the owner can not make itself felt as where the producer is doing a portion of the work about the barn and dairy himself. It is becoming more and more evident that the chief factor in the production of clean milk is the personality of the producer; he should be one who gets enjoyment out of his clean stables and cows and his high grade product.
The man who is producing milk for the city market is but one of many and his individual efforts can not make themselves felt. The dairyman who is marketing his own product is in a position where his efforts to produce a fine product should prove of distinct advantage to him in enabling him to sell it for a higher price than that obtained for ordinary milk.
It should be remembered that the production of clean, healthful milk is not a question of equipment, but of methods and of additional work. The cows must be fed, the stables must be cleaned, the cows milked, and the milk delivered to the consumer. If beyond this unavoidable labor a small additional amount is expended, the improvement in the product will be great. It is necessary that the additional work be placed where it will do the most good, in keeping the cows clean both summer and winter so that little need be done in cleaning them before milking, the pails and other utensils kept clean and sterilized, and the milk cooled as soon as possible[Pg 219] and kept cold until delivered to the consumer. The delivery should be made within the shortest practicable time after the milk is drawn. In order that the healthfulness of the milk may be beyond question, the herd must be kept free from tuberculosis and some attention should be paid to the health of the men, especially with reference to whether they may be typhoid carriers or not. The necessary labor should not increase the cost of the milk over one cent per quart. It has been shown in many cases that such a product can be marketed at a price that will more than compensate for the additional cost. Clean, fresh, rich milk is being sold in villages and small cities located in the great butter and cheese producing sections of the country for eight to ten cents per quart.
The duty of the consumer. The educational campaign that has been carried on by the health departments with reference to farm conditions and methods of handling has been most effective in improving the milk supply. Many cities are now extending this to the consumer, recognizing that as much harm may be done in the home as on the farm. The importance of keeping the milk cold, of not allowing it to stand exposed in open vessels, of thoroughly cleaning the vessel in which it is kept, or the milk bottle before returning it to the milkman are especially emphasized.
Moreover, it must be impressed upon the consumer that all of these improvements, not only on the farm where the milk is produced, but in the hands of the distributing companies in the cities, involve much expense, and cannot be carried out, unless the consumer is willing to pay their cost. More objection seems to be raised over[Pg 220] an increase in the price of milk than any other food stuff. The consumer therefore needs education along the line of higher prices for milk. Dairy products of all types have increased much in value in recent years, so that at present prices milk, sold directly as milk, is relatively cheaper than in any form, when prevailing prices are compared with those that obtained a decade ago.
Abnormal fermentations, overcoming of, 108.
Abortion, contagious, 75.
Acid, amount of formed in milk, 84.
Acidity test, 211.
Actinomycosis, 75.
Aeration of milk, 55.
Aerobic bacteria, 13.
Air, contamination of milk from, 51.
Alcohol test, 213.
Alcoholic fermentation, 96.
Anaerobic bacteria, 13.
Animal, contamination of milk from, 42.
Anthrax, 75.
Antiseptics, 16, 117.
B.
Bacillus Bulgaricus, 89, 101.
Bacillus lactis acidi, 86.
Bacteria, aerobic, 13;
anaerobic, 13;
culture media for, 20;
desirable acid-forming, 86;
determining number of, 22;
distribution of, 18;
effect of cold on, 14;
effect of heat on, 15;
food of, 12;
forms of, 8;
manner of growth of, 9;
movement of, 11;
nature of, 8;
parasitic, 11;
products of, 17;
pure cultures of, 25;
rate of growth of, 13;
relation to air, 13;
relation to chemicals, 16;
relation to drying, 15;
relation to light, 16;
relation to temperature, 12;
size of, 9;
saprophytic, 11;
spores of, 10;
types of acid-forming, 86;
undesirable acid-forming, 90.
Bedding, 47.
Bitter fermentation, 97.
Bleaching powder, 112.
Bloody milk, 99.
Butter, bacteria in, 154;
bacterial defects in, 156;
cowy odor in, 157;
deterioration of, 155;
fishy, 157;
metallic, 157;
molding of, 157;
preservatives in, 155;
putrid, 156;
source of flavor, 140;
turnip flavored, 156;
types of, 137.
Butter-milk, 100.
Butyric fermentation, 93.
Boric acid, 117.
Borax, 117.
C.
Carbolic acid, 111.
Cheese, abnormal fermentations of, 174;
bitter, 177;
Camembert, 186;
Cheddar, 164;
colored, 178;
flavor production in, 172;
gassy, 174;
Gorgonzola, 185;
Limburger, 187;
moldy, 179;
preservation of by acid, 171;
putrid, 178;
quality of milk for, 162;
ripening of, 169;
Roquefort, 184;
Stilton, 185;
Swiss, 180;
temperature of ripening, 173;
types of, 161.
Children, diseases of, 80.
Chloride of lime, 112.
Cholera, 80.
Cleaning utensils, 39.
Clean milk, production of, 53.
Cold, effect of, on bacteria, 14.
Colored milk, 98.
Condensed milk, 135.
Contagious abortion, 75.
Contamination of milk, from milking machine, 50;
in factory, 59.
Cooling of milk, 54.
Corrosive sublimate, 111.
Cream, control of fermentation of, 142;
pasteurization of, 146;
ripening of, 138;
separators, 36.
Cresol, 111.
Curd test, 104.
Cycle of fermentations, 99.
D.
Deodorants, 109.
Digestive fermentation, 93.
Diphtheria, 79.
Dirt, exclusion of, 44;
removal of from milk, 53.
Disinfectants, 16, 109.
Disinfection, 109.
Distribution of bacteria, 18.
Dried milk, 135.
[Pg 222]Drugs, excretion of in milk, 58.
Drying, effect of on bacteria, 15.
E.
Emmenthaler cheese, 180.
Evaporated milk, 134.
F.
Factory by-products, 36;
treatment of, 38.
Feeds, effect of on milk, 57.
Fermentation test, 104.
Fermented milks, 100.
Fly, contamination of milk by, 60;
means of spreading typhoid fever, 78.
Foot and mouth disease, 74.
Fore milk, 31; rejection of, 34.
Formalin, 112.
G.
Galactase, 172.
Garget, 75.
Germicidal action of milk, 33.
Gorgonzola cheese, 185.
H.
Hairs, bacteria on, 43.
Heat, effect on bacteria, 15.
Heated milk, detection of, 39.
Hydrogen peroxide, 118.
K.
Kefir, 102.
Koumiss, 102.
L.
Lange Wei, 95.
Light, effect on bacteria, 16.
Limburger cheese, 187.
Lime, 110.
Lumpy jaw, 75.
M.
Malta fever, 75.
Market milk, municipal regulations concerning, 190;
pasteurization of, 214.
Milk, acid fermentation of, 83;
aeration of, 55;
affected by feed, 57;
alcoholic fermentation of, 96;
bacterial standards for, 206;
bitter fermentation of, 93;
certified, 202;
butyric fermentation of, 93;
certified, 202, 208;
clarifying of, 115;
condition of when secreted, 29;
contamination of from animal, 42;
from by-products, 36;
from utensils, 34;
contamination of with tubercle bacilli, 67;
cooling of, 54;
creaming of, 136;
culture medium for bacteria, 28;
cycle of fermentation in, 99;
distribution of, 216;
digestive fermentation of, 93;
dirt in, 44;
effect of heat on, 119;
filtration of, 114;
germicidal action of, 33;
grades of, 201;
guaranteed, 201;
inspected, 202;
miscellaneous fermentations of, 98;
pasteurization of, 120;
pasteurization of in home, 131;
preservation of by antiseptics, 117;
preservation of by cold, 116;
relation to children's diseases, 80;
ropy fermentation, 94;
sediments, examination of, 214;
selected, 203;
slimy, 94;
spontaneous fermentation of, 91;
sterilization of, 134;
straining of, 153;
supply of small cities, 217;
sweet curdling fermentation of, 92;
tainted, 56, 58;
temperature standards for, 208;
tests for quality of, 209.
Milk pails, sanitary, 48;
small topped, 48.
Milker, factor in contamination of milk, 51.
Milking-machines, 36, 50.
Mold on butter, 177;
on cheese, 179.
O.
Odors, absorption of, 56, 58.
Oidium lactis, 186.
Oleomargarine, 152.
P.
Pasteurization, 120;
efficiency of, 133;
purpose of, 123;
methods of, 125.
Pasteurized milk, fermentations in, 124.
Pasteurizing machines, tests of, 130.
Process butter, 152.
Ptomaine poisoning, 81.
Pure cultures, 25.
R.
Rabies, 75.
Reduction test, 213.
Rennet, 170.
Ropy fermentation, 94.
Roquefort cheese, 184.
Rusty spot in cheese, 178.
S.
Salicylic acid, 117.
Scarlet fever, 79.
Score card for dairies, 198.
Sediment test, 210.
Skim milk, heating of, 38.
Slimy fermentation, 94.
[Pg 223]Spores of bacteria, 10.
Stalls, 46.
Starters, 143;
for cheese, 167;
propagation of, 146.
Sterilization, 21, 134.
Stilton cheese, 185.
Storch test, 39.
Straining of milk, 33.
Sulphur, 111.
Sweet curdling of milk, 92.
Swiss cheese, 180.
T.
Taints, determination of cause of, 58, 103.
Temperature effect on growth, 12.
Tubercle bacilli, destruction of, 71;
in butter, 70;
in cheese, 70;
in milk, 67.
Tuberculin test, 73.
Tuberculosis, 64;
closed, 70;
distribution of disease in animal, 66;
economic aspects of, 72;
open, 70.
Typhoid fever, 76.
U.
Udder, inflammation, 75;
invasion of by bacteria, 30;
number and kind of bacteria from, 32;
structure of, 30;
washing of, 47;
cleaning of, 39.
Utensils, contamination from, 34.
W.
Water, effect on butter, 153;
supply, 59;
testing of, 60.
Whey, heating of, 38.
Wisconsin curd test, 104.
Y.
Yeast fermentation, 96.
Yoghurt, 101.
End of the Project Gutenberg EBook of Outlines of dairy bacteriology, by
H. L. Russell and E. G. Hastings
*** END OF THIS PROJECT GUTENBERG EBOOK OUTLINES OF DAIRY BACTERIOLOGY ***
***** This file should be named 32367-h.htm or 32367-h.zip *****
This and all associated files of various formats will be found in:
https://www.gutenberg.org/3/2/3/6/32367/
Produced by Stacy Brown, Peter Vachuska, Julia Miller and
the Online Distributed Proofreading Team at
https://www.pgdp.net
Updated editions will replace the previous one--the old editions
will be renamed.
Creating the works from public domain print editions means that no
one owns a United States copyright in these works, so the Foundation
(and you!) can copy and distribute it in the United States without
permission and without paying copyright royalties. Special rules,
set forth in the General Terms of Use part of this license, apply to
copying and distributing Project Gutenberg-tm electronic works to
protect the PROJECT GUTENBERG-tm concept and trademark. Project
Gutenberg is a registered trademark, and may not be used if you
charge for the eBooks, unless you receive specific permission. If you
do not charge anything for copies of this eBook, complying with the
rules is very easy. You may use this eBook for nearly any purpose
such as creation of derivative works, reports, performances and
research. They may be modified and printed and given away--you may do
practically ANYTHING with public domain eBooks. Redistribution is
subject to the trademark license, especially commercial
redistribution.
*** START: FULL LICENSE ***
THE FULL PROJECT GUTENBERG LICENSE
PLEASE READ THIS BEFORE YOU DISTRIBUTE OR USE THIS WORK
To protect the Project Gutenberg-tm mission of promoting the free
distribution of electronic works, by using or distributing this work
(or any other work associated in any way with the phrase "Project
Gutenberg"), you agree to comply with all the terms of the Full Project
Gutenberg-tm License (available with this file or online at
https://gutenberg.org/license).
Section 1. General Terms of Use and Redistributing Project Gutenberg-tm
electronic works
1.A. By reading or using any part of this Project Gutenberg-tm
electronic work, you indicate that you have read, understand, agree to
and accept all the terms of this license and intellectual property
(trademark/copyright) agreement. If you do not agree to abide by all
the terms of this agreement, you must cease using and return or destroy
all copies of Project Gutenberg-tm electronic works in your possession.
If you paid a fee for obtaining a copy of or access to a Project
Gutenberg-tm electronic work and you do not agree to be bound by the
terms of this agreement, you may obtain a refund from the person or
entity to whom you paid the fee as set forth in paragraph 1.E.8.
1.B. "Project Gutenberg" is a registered trademark. It may only be
used on or associated in any way with an electronic work by people who
agree to be bound by the terms of this agreement. There are a few
things that you can do with most Project Gutenberg-tm electronic works
even without complying with the full terms of this agreement. See
paragraph 1.C below. There are a lot of things you can do with Project
Gutenberg-tm electronic works if you follow the terms of this agreement
and help preserve free future access to Project Gutenberg-tm electronic
works. See paragraph 1.E below.
1.C. The Project Gutenberg Literary Archive Foundation ("the Foundation"
or PGLAF), owns a compilation copyright in the collection of Project
Gutenberg-tm electronic works. Nearly all the individual works in the
collection are in the public domain in the United States. If an
individual work is in the public domain in the United States and you are
located in the United States, we do not claim a right to prevent you from
copying, distributing, performing, displaying or creating derivative
works based on the work as long as all references to Project Gutenberg
are removed. Of course, we hope that you will support the Project
Gutenberg-tm mission of promoting free access to electronic works by
freely sharing Project Gutenberg-tm works in compliance with the terms of
this agreement for keeping the Project Gutenberg-tm name associated with
the work. You can easily comply with the terms of this agreement by
keeping this work in the same format with its attached full Project
Gutenberg-tm License when you share it without charge with others.
1.D. The copyright laws of the place where you are located also govern
what you can do with this work. Copyright laws in most countries are in
a constant state of change. If you are outside the United States, check
the laws of your country in addition to the terms of this agreement
before downloading, copying, displaying, performing, distributing or
creating derivative works based on this work or any other Project
Gutenberg-tm work. The Foundation makes no representations concerning
the copyright status of any work in any country outside the United
States.
1.E. Unless you have removed all references to Project Gutenberg:
1.E.1. The following sentence, with active links to, or other immediate
access to, the full Project Gutenberg-tm License must appear prominently
whenever any copy of a Project Gutenberg-tm work (any work on which the
phrase "Project Gutenberg" appears, or with which the phrase "Project
Gutenberg" is associated) is accessed, displayed, performed, viewed,
copied or distributed:
This eBook is for the use of anyone anywhere at no cost and with
almost no restrictions whatsoever. You may copy it, give it away or
re-use it under the terms of the Project Gutenberg License included
with this eBook or online at www.gutenberg.org
1.E.2. If an individual Project Gutenberg-tm electronic work is derived
from the public domain (does not contain a notice indicating that it is
posted with permission of the copyright holder), the work can be copied
and distributed to anyone in the United States without paying any fees
or charges. If you are redistributing or providing access to a work
with the phrase "Project Gutenberg" associated with or appearing on the
work, you must comply either with the requirements of paragraphs 1.E.1
through 1.E.7 or obtain permission for the use of the work and the
Project Gutenberg-tm trademark as set forth in paragraphs 1.E.8 or
1.E.9.
1.E.3. If an individual Project Gutenberg-tm electronic work is posted
with the permission of the copyright holder, your use and distribution
must comply with both paragraphs 1.E.1 through 1.E.7 and any additional
terms imposed by the copyright holder. Additional terms will be linked
to the Project Gutenberg-tm License for all works posted with the
permission of the copyright holder found at the beginning of this work.
1.E.4. Do not unlink or detach or remove the full Project Gutenberg-tm
License terms from this work, or any files containing a part of this
work or any other work associated with Project Gutenberg-tm.
1.E.5. Do not copy, display, perform, distribute or redistribute this
electronic work, or any part of this electronic work, without
prominently displaying the sentence set forth in paragraph 1.E.1 with
active links or immediate access to the full terms of the Project
Gutenberg-tm License.
1.E.6. You may convert to and distribute this work in any binary,
compressed, marked up, nonproprietary or proprietary form, including any
word processing or hypertext form. However, if you provide access to or
distribute copies of a Project Gutenberg-tm work in a format other than
"Plain Vanilla ASCII" or other format used in the official version
posted on the official Project Gutenberg-tm web site (www.gutenberg.org),
you must, at no additional cost, fee or expense to the user, provide a
copy, a means of exporting a copy, or a means of obtaining a copy upon
request, of the work in its original "Plain Vanilla ASCII" or other
form. Any alternate format must include the full Project Gutenberg-tm
License as specified in paragraph 1.E.1.
1.E.7. Do not charge a fee for access to, viewing, displaying,
performing, copying or distributing any Project Gutenberg-tm works
unless you comply with paragraph 1.E.8 or 1.E.9.
1.E.8. You may charge a reasonable fee for copies of or providing
access to or distributing Project Gutenberg-tm electronic works provided
that
- You pay a royalty fee of 20% of the gross profits you derive from
the use of Project Gutenberg-tm works calculated using the method
you already use to calculate your applicable taxes. The fee is
owed to the owner of the Project Gutenberg-tm trademark, but he
has agreed to donate royalties under this paragraph to the
Project Gutenberg Literary Archive Foundation. Royalty payments
must be paid within 60 days following each date on which you
prepare (or are legally required to prepare) your periodic tax
returns. Royalty payments should be clearly marked as such and
sent to the Project Gutenberg Literary Archive Foundation at the
address specified in Section 4, "Information about donations to
the Project Gutenberg Literary Archive Foundation."
- You provide a full refund of any money paid by a user who notifies
you in writing (or by e-mail) within 30 days of receipt that s/he
does not agree to the terms of the full Project Gutenberg-tm
License. You must require such a user to return or
destroy all copies of the works possessed in a physical medium
and discontinue all use of and all access to other copies of
Project Gutenberg-tm works.
- You provide, in accordance with paragraph 1.F.3, a full refund of any
money paid for a work or a replacement copy, if a defect in the
electronic work is discovered and reported to you within 90 days
of receipt of the work.
- You comply with all other terms of this agreement for free
distribution of Project Gutenberg-tm works.
1.E.9. If you wish to charge a fee or distribute a Project Gutenberg-tm
electronic work or group of works on different terms than are set
forth in this agreement, you must obtain permission in writing from
both the Project Gutenberg Literary Archive Foundation and Michael
Hart, the owner of the Project Gutenberg-tm trademark. Contact the
Foundation as set forth in Section 3 below.
1.F.
1.F.1. Project Gutenberg volunteers and employees expend considerable
effort to identify, do copyright research on, transcribe and proofread
public domain works in creating the Project Gutenberg-tm
collection. Despite these efforts, Project Gutenberg-tm electronic
works, and the medium on which they may be stored, may contain
"Defects," such as, but not limited to, incomplete, inaccurate or
corrupt data, transcription errors, a copyright or other intellectual
property infringement, a defective or damaged disk or other medium, a
computer virus, or computer codes that damage or cannot be read by
your equipment.
1.F.2. LIMITED WARRANTY, DISCLAIMER OF DAMAGES - Except for the "Right
of Replacement or Refund" described in paragraph 1.F.3, the Project
Gutenberg Literary Archive Foundation, the owner of the Project
Gutenberg-tm trademark, and any other party distributing a Project
Gutenberg-tm electronic work under this agreement, disclaim all
liability to you for damages, costs and expenses, including legal
fees. YOU AGREE THAT YOU HAVE NO REMEDIES FOR NEGLIGENCE, STRICT
LIABILITY, BREACH OF WARRANTY OR BREACH OF CONTRACT EXCEPT THOSE
PROVIDED IN PARAGRAPH F3. YOU AGREE THAT THE FOUNDATION, THE
TRADEMARK OWNER, AND ANY DISTRIBUTOR UNDER THIS AGREEMENT WILL NOT BE
LIABLE TO YOU FOR ACTUAL, DIRECT, INDIRECT, CONSEQUENTIAL, PUNITIVE OR
INCIDENTAL DAMAGES EVEN IF YOU GIVE NOTICE OF THE POSSIBILITY OF SUCH
DAMAGE.
1.F.3. LIMITED RIGHT OF REPLACEMENT OR REFUND - If you discover a
defect in this electronic work within 90 days of receiving it, you can
receive a refund of the money (if any) you paid for it by sending a
written explanation to the person you received the work from. If you
received the work on a physical medium, you must return the medium with
your written explanation. The person or entity that provided you with
the defective work may elect to provide a replacement copy in lieu of a
refund. If you received the work electronically, the person or entity
providing it to you may choose to give you a second opportunity to
receive the work electronically in lieu of a refund. If the second copy
is also defective, you may demand a refund in writing without further
opportunities to fix the problem.
1.F.4. Except for the limited right of replacement or refund set forth
in paragraph 1.F.3, this work is provided to you 'AS-IS' WITH NO OTHER
WARRANTIES OF ANY KIND, EXPRESS OR IMPLIED, INCLUDING BUT NOT LIMITED TO
WARRANTIES OF MERCHANTIBILITY OR FITNESS FOR ANY PURPOSE.
1.F.5. Some states do not allow disclaimers of certain implied
warranties or the exclusion or limitation of certain types of damages.
If any disclaimer or limitation set forth in this agreement violates the
law of the state applicable to this agreement, the agreement shall be
interpreted to make the maximum disclaimer or limitation permitted by
the applicable state law. The invalidity or unenforceability of any
provision of this agreement shall not void the remaining provisions.
1.F.6. INDEMNITY - You agree to indemnify and hold the Foundation, the
trademark owner, any agent or employee of the Foundation, anyone
providing copies of Project Gutenberg-tm electronic works in accordance
with this agreement, and any volunteers associated with the production,
promotion and distribution of Project Gutenberg-tm electronic works,
harmless from all liability, costs and expenses, including legal fees,
that arise directly or indirectly from any of the following which you do
or cause to occur: (a) distribution of this or any Project Gutenberg-tm
work, (b) alteration, modification, or additions or deletions to any
Project Gutenberg-tm work, and (c) any Defect you cause.
Section 2. Information about the Mission of Project Gutenberg-tm
Project Gutenberg-tm is synonymous with the free distribution of
electronic works in formats readable by the widest variety of computers
including obsolete, old, middle-aged and new computers. It exists
because of the efforts of hundreds of volunteers and donations from
people in all walks of life.
Volunteers and financial support to provide volunteers with the
assistance they need are critical to reaching Project Gutenberg-tm's
goals and ensuring that the Project Gutenberg-tm collection will
remain freely available for generations to come. In 2001, the Project
Gutenberg Literary Archive Foundation was created to provide a secure
and permanent future for Project Gutenberg-tm and future generations.
To learn more about the Project Gutenberg Literary Archive Foundation
and how your efforts and donations can help, see Sections 3 and 4
and the Foundation web page at https://www.pglaf.org.
Section 3. Information about the Project Gutenberg Literary Archive
Foundation
The Project Gutenberg Literary Archive Foundation is a non profit
501(c)(3) educational corporation organized under the laws of the
state of Mississippi and granted tax exempt status by the Internal
Revenue Service. The Foundation's EIN or federal tax identification
number is 64-6221541. Its 501(c)(3) letter is posted at
https://pglaf.org/fundraising. Contributions to the Project Gutenberg
Literary Archive Foundation are tax deductible to the full extent
permitted by U.S. federal laws and your state's laws.
The Foundation's principal office is located at 4557 Melan Dr. S.
Fairbanks, AK, 99712., but its volunteers and employees are scattered
throughout numerous locations. Its business office is located at
809 North 1500 West, Salt Lake City, UT 84116, (801) 596-1887, email
business@pglaf.org. Email contact links and up to date contact
information can be found at the Foundation's web site and official
page at https://pglaf.org
For additional contact information:
Dr. Gregory B. Newby
Chief Executive and Director
gbnewby@pglaf.org
Section 4. Information about Donations to the Project Gutenberg
Literary Archive Foundation
Project Gutenberg-tm depends upon and cannot survive without wide
spread public support and donations to carry out its mission of
increasing the number of public domain and licensed works that can be
freely distributed in machine readable form accessible by the widest
array of equipment including outdated equipment. Many small donations
($1 to $5,000) are particularly important to maintaining tax exempt
status with the IRS.
The Foundation is committed to complying with the laws regulating
charities and charitable donations in all 50 states of the United
States. Compliance requirements are not uniform and it takes a
considerable effort, much paperwork and many fees to meet and keep up
with these requirements. We do not solicit donations in locations
where we have not received written confirmation of compliance. To
SEND DONATIONS or determine the status of compliance for any
particular state visit https://pglaf.org
While we cannot and do not solicit contributions from states where we
have not met the solicitation requirements, we know of no prohibition
against accepting unsolicited donations from donors in such states who
approach us with offers to donate.
International donations are gratefully accepted, but we cannot make
any statements concerning tax treatment of donations received from
outside the United States. U.S. laws alone swamp our small staff.
Please check the Project Gutenberg Web pages for current donation
methods and addresses. Donations are accepted in a number of other
ways including including checks, online payments and credit card
donations. To donate, please visit: https://pglaf.org/donate
Section 5. General Information About Project Gutenberg-tm electronic
works.
Professor Michael S. Hart was the originator of the Project Gutenberg-tm
concept of a library of electronic works that could be freely shared
with anyone. For thirty years, he produced and distributed Project
Gutenberg-tm eBooks with only a loose network of volunteer support.
Project Gutenberg-tm eBooks are often created from several printed
editions, all of which are confirmed as Public Domain in the U.S.
unless a copyright notice is included. Thus, we do not necessarily
keep eBooks in compliance with any particular paper edition.
Most people start at our Web site which has the main PG search facility:
https://www.gutenberg.org
This Web site includes information about Project Gutenberg-tm,
including how to make donations to the Project Gutenberg Literary
Archive Foundation, how to help produce our new eBooks, and how to
subscribe to our email newsletter to hear about new eBooks.